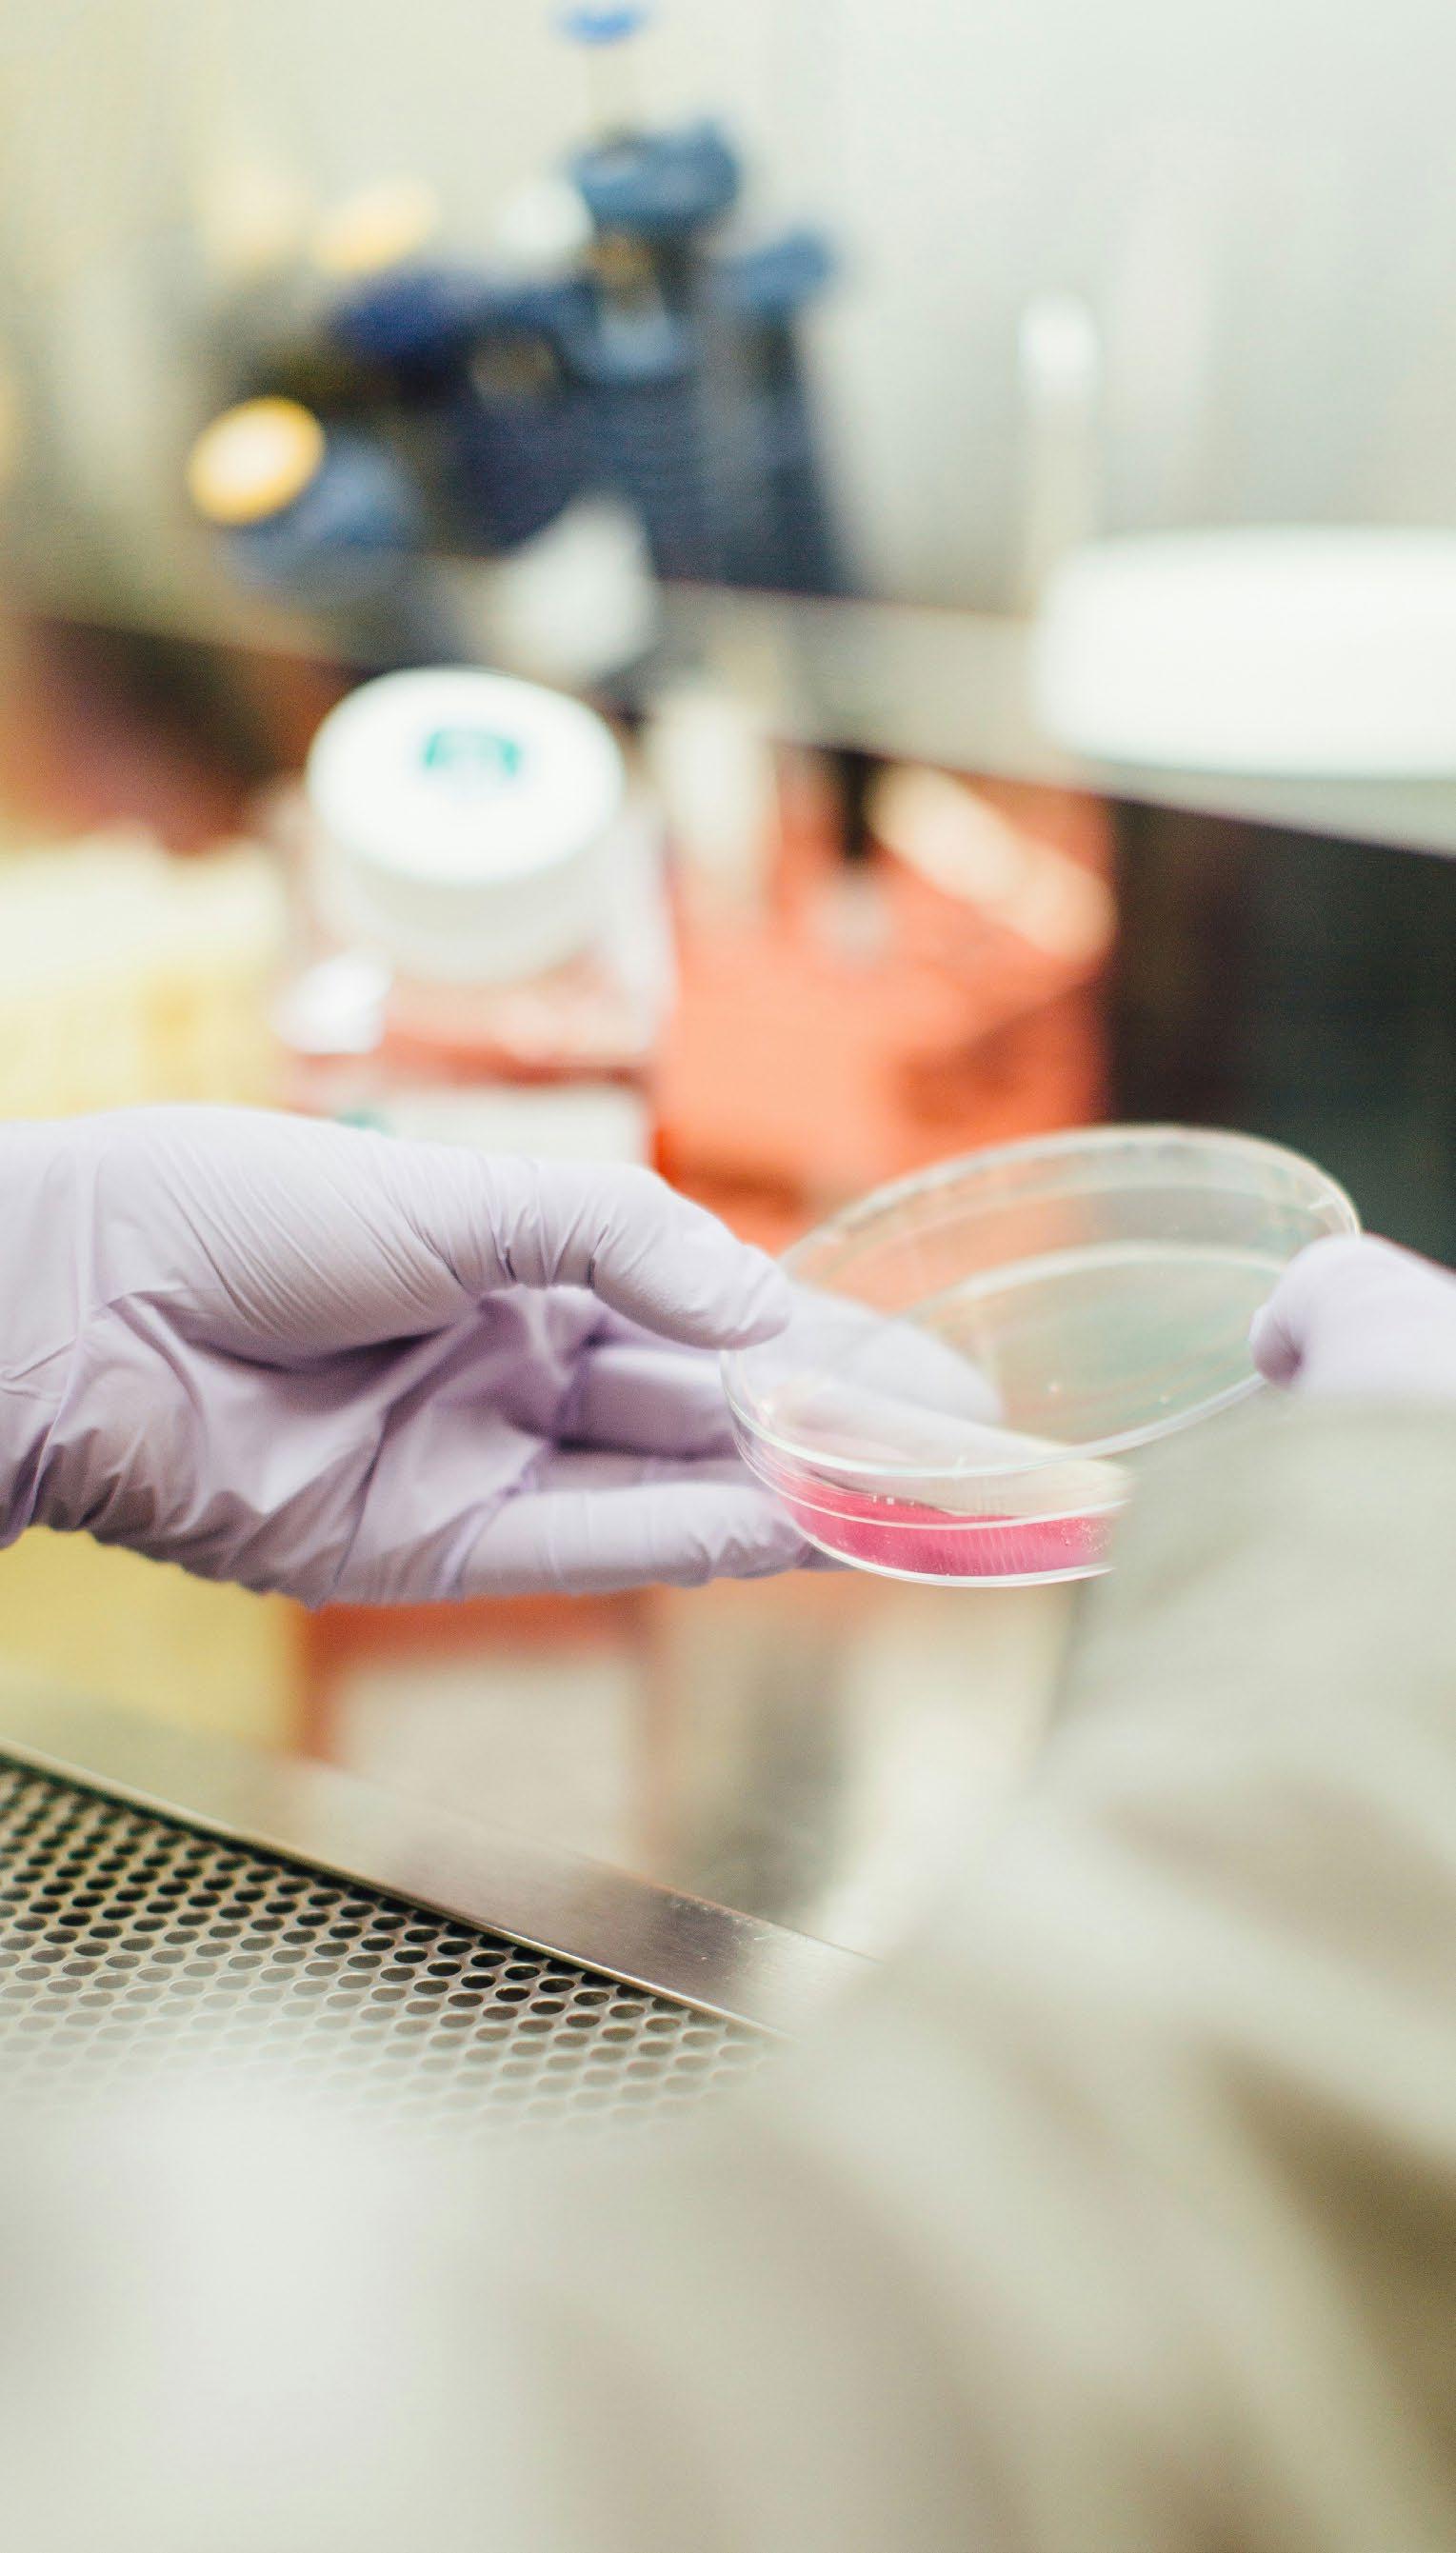

![]()






















































› Volteadoras BACKHUS










› Cribas de tambor TERRA SELECT
› Cribas de estrella STAR SELECT









› Trituradores de monoeje TEUTON





















› Trituradores de doble eje FORUS























































Plantas de tratamiento y producción de biogás.












































Veolia tiene como misión desarrollar el acceso a los recursos, preservarlos y renovarlos mediante el fomento de la economía circular. Ayudamos a nuestros clientes a afrontar los desafíos de la transformación ecológica y la descarbonización. Conoce más sobre nuestras soluciones en veolia.es

Javier Domínguez, Sogama

Cristina Sánchez, Pacto Mundial de la ONU España

Laura Silva, Instituto de Tecnología de la Construcción (ITeC)

Joaquín Pérez, Aeversu

José María Fernández, Ihobe

Pablo Pérez, Grupo de Interés Áridos Reciclados de RCD
DIRECTOR
Jesús Alberto Casillas Paz albertocasillas@retema.es
PUBLICIDAD
David Casillas Paz davidcasillas@retema.es
REDACCIÓN
Nuria Suárez nuriasuarez@retema.es
Griselda Romero griseldaromero@retema.es

Guiomar Rubio, G-advisory

Víctor Moralo, Ecija

Rita Martínez, Asociación Nacional de Empresarios Fabricantes de Áridos (ANEFA)


Javier Fernández, Garrigues

Luis Medina-Montoya, Fundación para la Economía Circular

Cristina Sanabria, Ayuntamiento de Madrid


EDITA: ADC MEDIA · Calle Maestro Arbos 9, oficina 0.02 - 28045 Madrid Telf. (+34) 91 471 34 05 - info@retema.es
COLABORADORES
Patricia Ruiz Guevara
Judit Alonso
SUSCRIPCIONES suscripciones@retema.es
DISEÑO Y MAQUETACIÓN
Irene García Alba
IMPRIME
Monterreina
La dirección de RETEMA no se hace responsable de las opiniones contenidas en los artículos firmados que aparecen en la publicación. La aparición de la revista RETEMA se realiza a meses vencidos. © Prohibida la reproducción total o parcial por cualquier medio sin autorización previa y escrita del autor.
Suscripción 1 año España: 136 €
Suscripción 1 año resto de Europa: 246 €
Suscripción 1 año resto de paises: 281 €
Suscripción Digital 1 año: 78 €
Depósito Legal M.38.309-1987
ISSN 1130 - 9881
Publicación impresa en papel bajo el sistema de certificación forestal PEFC procedente de bosques gestionados de forma sostenible y fuentes controladas y con tintas ecológicas a base de aceites vegetales. Libre de plastificados. Monomaterial y 100% reciclable al final de su vida útil. PEFC/14-38-00015
JULIO/AGOSTO 2024 • Nº 256 • AÑO 37


NOTICIAS DESTACADAS
Página 6
EMPRESA
EL PAPEL CLAVE DE LAS EMPRESAS DE INSERCIÓN PARA LA GESTIÓN SOSTENIBLE DE LOS RESIDUOS TEXTILES Y LA INCLUSIÓN LABORAL
Página 12
INFOGRAFÍA
GESTIÓN DE RESIDUOS A NIVEL GLOBAL: ESTADO ACTUAL Y PROYECCIONES A 2050
Página 16
EN PRIMERA PERSONA EL VALOR DE UN SERVICIO QUE NO SE VALORA
Página 18
EMPRESA
MARESME CIRCULAR, LA IMPORTANCIA DE FOMENTAR LA DESCARBONIZACIÓN EN LA GESTIÓN DE RESIDUOS Página 22
TECNOLOGÍA CONSUMO DE ENERGÍA OPTIMIZADO CON LA ENCINTADORA DE BALAS ELÉCTRICA CW 2200
Página 26
ENTREVISTA
JOAQUÍN PÉREZ VIOTA, PRESIDENTE DE AEVERSU Página 28
INVESTIGACIÓN AITEX TRABAJA EN EL RECICLADO QUÍMICO DE
RESIDUOS TEXTILES POST-CONSUMO
Página 36
EN PRIMERA PERSONA DESAFÍOS, OPORTUNIDADES Y CUESTIONES PENDIENTES EN LA IMPLANTACIÓN DEL REAL DECRETO DE ENVASES Página 38
TECNOLOGÍA PASS™ FINALMENTE LLEGA A ESPAÑA
Página 42
REPORTAJE LA GESTIÓN DE RESIDUOS A ESCALA GLOBAL: PRESENTE Y FUTURO Página 44


TECNOLOGÍA
DO YOU SPEAK CAMEC?
Página 54
EN PRIMERA PERSONA
PRESERVAR LOS RECURSOS PARA MANTENER EL BIENESTAR
Página 56
REPORTAJE
EUROPA HACIA LA CIRCULARIDAD:
LA NECESIDAD DE UNA LEY DE USO CIRCULAR DE MATERIALES
Página 60
TECNOLOGÍA
AMPLIA VERSATILIDAD PARA EL RECICLAJE CON EL TRITURADOR MÓVIL FORUS F38 DE EGGERSMANN
Página 72
TECNOLOGÍA
NAVEGANDO LA OLA DE RESIDUOS DE NUEVA GENERACIÓN: EL ENFOQUE PROACTIVO DE PICVISA
Página 74
EN PRIMERA PERSONA
ECONOMÍA CIRCULAR: EL CAMINO HACIA EL INFINITO SOSTENIBLE
Página 76
REPORTAJE
NUEVA PLANTA DE CLASIFICACIÓN DE ENVASES LIGEROS DE ALZIRA, VALENCIA
Página 80
TECNOLOGÍA
NUEVA ALIANZA ENTRE AMBISORT E ITALREC PARA MEJORAR EL RECICLAJE DE PLÁSTICOS EN ESPAÑA
Página 92
ENTREVISTA
JOSÉ MARÍA FERNÁNDEZ ALCALÁ, DIRECTOR DE ECONOMÍA CIRCULAR DE IHOBE
Página 94
3 CLAVES DE FUTURO EL ROL DEL ECODISEÑO PARA UNA ECONOMÍA CIRCULAR
Página 102
EN PRIMERA PERSONA REQUISITOS DE ECODISEÑO Y DIGITALIZACIÓN: A ENTRADA EN VIGOR DEL PASAPORTE DIGITAL DE PRODUCTO Página 106
TECNOLOGÍA
PRENSAS VERTICALES BRAMIDAN Y SOLUCIONES PRESTO, INNOVACIÓN EN LA GESTIÓN DE RESIDUOS Página 110
REPORTAJE HACIA UNA GESTIÓN SOSTENIBLE DE LOS RESIDUOS: OBSTÁCULOS Y ESTRATEGIAS PARA EL CAMBIO Página 112
TECNOLOGÍA LA POTENCIA DE IMABE EN EL CTR VALLADOLID: TRANSFORMANDO RESIDUOS EN EFICIENCIA
Página 122


TECNOLOGÍA
RRT SE EXPANDE EN EL MERCADO NACIONAL E INTERNACIONAL Página 123
EN PRIMERA PERSONA DESAFÍOS Y OPORTUNIDADES EN LA GESTIÓN DE RESIDUOS Y ECONOMÍA CIRCULAR EN ESPAÑA: EL PAPEL DE LOS SISTEMAS DE ALERTA TEMPRANA Página 124
PROYECTO ICAREPLAST. UNA APUESTA POR LA INNOVACIÓN Y LA CIRCULARIDAD PARA TRANSFORMAR RESIDUOS PLÁSTICOS URBANOS EN PRODUCTOS QUÍMICOS VALIOSOS Página 128
TECNOLOGÍA
TRANSFORMACIÓN ECOLÓGICA: DEL ÁRBOL A LAS RAÍCES Página 134
EMPRESA LOS NEUMÁTICOS RECICLADOS TRANSFORMADOS PARA SU USO EN LAS CIUDADES Página 135
EN PRIMERA PERSONA HACIA UNA ECONOMÍA CIRCULAR EN EL SECTOR HOTELERO: INNOVACIÓN Y SOSTENIBILIDAD EN LA GESTIÓN DE RESIDUOS Y DESPERDICIO ALIMENTARIO Página 136
REPORTAJE
NUEVA PLANTA LAVADORA Y CLASIFICADORA DE VIDRIO EN CENTROAMÉRICA
Página 140
REPORTAJE
ÁRIDOS RECICLADOS: PILAR DE LA CONSTRUCCIÓN SOSTENIBLE Página 146
EN PRIMERA PERSONA AVANZANDO DESDE LO LOCAL HACIA
UNA ECONOMÍA CIRCULAR Página 154
REPORTAJE MATERIALES BIODEGRADABLES, UNA ALTERNATIVA URGENTE CONTRA LA DEGRADACIÓN AMBIENTAL Página 158
ENTREVISTA NATIVIDAD SÁNCHEZ, DIRECTORA DE COMUNICACIÓN DE OCEANA EN EUROPA Página 164
BASURAS MARINAS DE PLÁSTICO ¿POR QUÉ ESTÁN LOS PLÁSTICOS EN EL PUNTO DE MIRA DE LA UEY DEL MUNDO? Página 170
DIRECTORIO DE EMPRESAS Página 173

Las IV Jornadas Cátedra Economía Circular reunirán en Sevilla el próximo 26 de septiembre a autoridades nacionales y regionales, así como a empresas destacadas de diferentes sectores con proyectos centrados en la economía circular y la gestión responsable de residuos, que analizarán los retos y oportunidades para el desarrollo sostenible.
El encuentro, organizado por la Cátedra de Economía Circular de la Universidad de Sevilla con la colaboración de las empresas andaluzas Aborgase y GSA Servicios Ambientales, contará con dos ponencias plenarias a cargo, respectivamente, de Alejandro Dorado Nájera, comisionado para la Economía Circular. Ministerio para la Transición Ecológica y el Reto Demográfico, y de María López Sanchís, secretaria general de Medio Ambiente, Cambio Climático y Economía Azul de la Junta de Andalucía, que abordarán las últimas normativas nacionales y andaluzas en materia de economía circular y residuos.
Las Jornadas se centrarán en asuntos de máxima actualidad medioambiental, entre los que destacan la Ley de Economía Circular de Andalucía (LECA); el impuesto sobre el depósito de residuos en vertederos, la incineración y la coincineración de residuos; así como las nuevas normativas en el ámbito de los residuos y los programas de financiación, como el PERTE de Economía Circular que contempla subvenciones para proyectos de impulso a la economía circular en la empresa, así como ayudas para los sectores clave del textil, la moda y el calzado, del plástico, entre otros asuntos.
Las IV Jornadas Cátedra Economía Circular tendrán lugar en el Acuario de Sevilla y se celebrarán en formato presencial. Los interesados en asistir pueden inscribirse de manera gratuita en la web de la Cátedra de Economía Circular.
La Conferencia Sectorial de Medio
Ambiente celebrada a finales del pasado mes de julio ha ratificado el reparto territorial de 481,1 millones de euros para diversas inversiones destinadas a la conservación y la restauración de la biodiversidad, acciones de lucha contra el cambio climático, a la implementación de la normativa de residuos o al programa de economía circular. En su reunión telemática, el órgano de coordinación entre el MITECO y las comunidades autónomas ha validado así los acuerdos aprobados previamente en Consejo de Ministros que canalizan fondos del Plan de Recuperación, Transformación y Resiliencia (PRTR) para el ejercicio presupuestario 2024 en el ámbito de la transición ecológica. El total de fondos territorializados se distribuye en distintos acuerdos: PIMA eventos adversos: 7,5 millones; PERTE digitalización ciclo del agua: 100 millones; Plan de aplicación de la normativa de residuos: proyectos estratégicos 300 millones; digitalización 48,4 millones; Actuaciones de conservación y restauración de la biodiversidad: 2 millones; Lobo ibérico, medidas preventivas e indemnizaciones por daños: 20 millones (10,5 + 9,5 millones, respectivamente); Áreas de influencia socioeconómica de parques nacionales: 3,2 millones.
La cuantía más elevada, 348,4 millones, se destina a la aplicación del Plan de apoyo a la implementación de la normativa de residuos y al fomento de la economía circular, medida 3 del componente 12 del PRTR español.
Cepsa y PreZero España han alcanzado una alianza estratégica que permitirá a ambas compañías avanzar en sus objetivos de descarbonización. Las dos empresas impulsarán el mercado del biometano mediante la colaboración en el suministro de este gas renovable por parte de PreZero España en algunos de sus proyectos a la energética, además del desarrollo conjunto de plantas de biometano. Asimismo, Cepsa y PreZero España trabajarán en la valorización de residuos para la producción de biocombustibles de segunda generación y productos químicos circulares y en la descarbonización de la flota terrestre que opera PreZero en España y Portugal. Ambas compañías ya avanzan en el desarrollo de una planta de biometano en la provincia de Huelva. Esta nueva instalación será una de las mayores instalaciones de esta energía renovable en nuestro país y servirá para la producción de hidrógeno verde y combustibles renovables. Esta planta se construirá en las instalaciones de Cepsa en Palos de la Frontera, donde la compañía cuenta con un parque energético y una planta química.

Además, PreZero facilitará a Cepsa este gas renovable, de forma preferente, en aquellos proyectos que PreZero y Cepsa identifiquen como estratégicos para ambas partes, lo que permitirá a la energética y a sus clientes descarbonizar sus procesos industriales. Durante su ciclo de vida, este gas renovable puede reducir hasta el 90% de las emisiones de CO2 respecto al gas natural y tiene las mismas características que éste, lo que permite que pueda almacenarse o inyectarse en la actual red de transporte gasista, sin necesidad de desarrollar nuevas infraestructuras. El acuerdo también permitirá a Cepsa adquirir CO2 biogénico, procedente de las plantas de biometano de PreZero España, para la producción de combustibles sintéticos. En el marco de esta alianza, PreZero valorizará otros residuos orgánicos o aceites usados de cocina para que Cepsa los utilice en la producción de biocombustibles de segunda generación, que facilitarán la descarbonización inmediata de sectores difícilmente electrificables, como el transporte pesado por carretera, marítimo o aéreo. Asimismo, PreZero tratará residuos plásticos para suministrar a Cepsa la materia prima con la que la compañía podrá desarrollar productos químicos circulares.
El Ministerio para la Transición Ecológica y el Reto Demográfico (MITECO) ha publicado una nueva convocatoria de subvenciones para proyectos de impulso a la economía circular en la empresa, destinada a proyectos que contribuyan a fomentar la sostenibilidad y circularidad de los procesos industriales y empresariales, y para mejorar la competitividad e innovación del tejido industrial. Su dotación alcanza hasta los 26,8 millones de euros y permitirá financiar las mejores iniciativas seleccionadas, con importes de entre 100.000 euros y 10 millones por proyecto y entidad beneficiaria.
La convocatoria se enmarca en la línea de acción 2 del PERTE de Economía Circular y en la inversión C12.I3 «Plan de apoyo a la implementación de la Estrategia Española de Economía Circular y a la normativa de residuos» del Componente 12 «Política Industrial de España 2030», del Plan de Recuperación, Transformación y Resiliencia (PRTR) del Gobierno de España, que cuenta con un total de 192 millones.
Europa ha alcanzado una capacidad instalada de 6.400 millones de metros cúbicos (bcm) de biometano al año, según el Mapa Europeo del Biometano. El 81% de la capacidad corresponde a plantas ubicadas en la Unión Europea (5,2 bcm). El crecimiento de los países de la UE-27 ha alcanzado el 37%, mientras que la capacidad de los países extracomunitarios analizados creció un 20% en comparación con el conjunto de datos 2022-2023.
La capacidad total instalada de biometano en Europa puede contribuir a evitar la emisión de casi 29 millones de toneladas de CO2 al año y producir 830.000 toneladas de fertilizantes orgánicos al año. Estas plantas también pueden proporcionar energía renovable a 5 millones de hogares europeos durante todo el año o abastecer a 145.000 hogares europeos de bio-GNL durante todo el año, cumpliendo así los objetivos de seguridad energética y mitigación del cambio climático de Europa a largo plazo.
El mapa muestra 1.548 plantas de biometano, lo que representa un crecimiento del 32% en el número de plantas en Europa en comparación con la edición anterior, que incluía 1.174 unidades. Más del 80% de las plantas de biometano reportadas están ahora conectadas a la red de gas, y casi la mitad de ellas (49%) están conectadas a la red de distribución y el 14% a la red de transporte.


La CNMC ha analizado la gestión de los residuos de envases destinados al contenedor amarillo y al de vidrio. En España, el sector históricamente ha funcionado como un monopolio, a diferencia de otros países europeos, por lo que favorecer la competencia es esencial para mejorar su funcionamiento. Según el análisis de la entidad, es crucial que la regulación y las autoridades promuevan la competencia de forma activa a través de las siguientes medidas:
Reducir las barreras de entrada, facilitando la autorización de nuevos SCRAPs, eliminando o flexibilizando el plazo para la firma de convenios y agilizando que las empresas puedan cambiar de SCRAP; establecer un marco de coordinación entre agentes públicos y privados eficiente; fomentar la transparencia, con medidas que mejoren la trazabilidad y la detección del fraude; prevenir y remediar conflictos de interés o fomentar la competencia en la adjudicación de residuos de los SCRAPs a los recicladores desarrollando la regulación en detalle son algunos de las principales conclusiones.
El proyecto para la gestión de biorresiduos en el Complejo de Biometanización del Parque Tecnológico de Valdemingómez (PTV) ha sido galardonado en el congreso internacional “World Biogas Summit”, celebrado en la ciudad de Birmingham (Reino Unido). Los galardones “AD and Biogas Industry Awards 2024” reconocen a los mejores proyectos del sector y, en este caso, el Ayuntamiento de Madrid se ha aupado como ganador en la categoría ‘Net Zero Circular Solutions’. El jurado ha reconocido la construcción de dos de las mayores plantas de biometanización de Europa y la reciente ampliación de la planta de tratamiento de biogás (PTB) para producir biometano. También ha puesto en valor la implantación del quinto contenedor (cubo marrón) en la ciudad de Madrid, el proyecto de movilidad sostenible y economía circular que permite desplazar autobuses de la Empresa Municipal de Transportes de Madrid (EMT Madrid) a partir del biometano generado en la gestión de los residuos, la construcción de la nueva planta de los Cantiles para el compostaje del digesto generado en el proceso de biometanización de los biorresiduos y, finalmente, el control y seguimiento de emisiones difusas de biogás en el Parque Tecnológico de Valdemingómez.
Sogama ha licitado, por un importe base de 39.619.807,14 € y un valor total estimado de 58.057.253,15 €, la gestión integral de su vertedero controlado de Areosa (Cerceda) y las instalaciones que lo conforman. El contrato, que contempla obras y servicios, y con una duración inicial de 3 años (prorrogable por 2 más), incluye la gestión de los residuos que entran en el vertedero, las depuradoras de ósmosis inversa, planta de biogás, planta de compostaje (junto con la comercialización del compost obtenido en la misma) y mantenimiento postclausura de las fases ya selladas y clausuradas.
Más allá de las labores de gestión, la licitación contempla distintas obras tales como, entre otras, el sellado de la subfase 1.2 de la ampliación sur del vertedero y la de construcción del Vaso 6, la puesta en marcha de diversas instalaciones eléctricas y de alumbrado que dan servicio a las instalaciones del vertedero, la construcción de un nuevo centro de transformación y la adaptación de la planta de compostaje a los requisitos SANDACH categoría 3.

Producción de combustible alternativo en un solo paso. Preciso. Seguro. Económico.
Producción de combustible alternativo en un solo paso. Preciso. Seguro. Económico.

Durante 2023, SIGNUS gestionó 205.825,7 toneladas de neumáticos fuera de uso que convirtió en nuevos productos útiles para diferentes aplicaciones. Del total recogido más del 12% se destinó a la preparación para su reutilización (neumático de segundo uso o recauchutado), el 51,1% se recicló en productos que se destinaron a diferentes aplicaciones y el 36,49 % se destinó a valorización energética mayoritariamente como sustituto de combustibles fósiles. En el transcurso del año 2023, SIGNUS siguió recogiendo cantidades superiores, en todas las comunidades autónomas, a las que fija para SIGNUS el Ministerio para la Transición Ecológica y el Reto Democrático (MITERD). En algún caso la diferencia supera el 20% concentradas en aquellas comunidades autónomas en que la recogida de los neumáticos fuera de uso es más complicada, por extensión geográfica, población dispersa o distancia a los centros de tratamiento.
Respecto al reciclaje, entre los principales usos a los que se destinó el material obtenido del neumático al final de su vida útil en 2023, destacan 25.478 toneladas para la instalación de cerca de 255 campos de fútbol, 20.802 toneladas para la construcción de aproximadamente 4.100 parques infantiles y 1.708 toneladas que se incorporaron a 160 kilómetros de carreteras, entre otros. También destaca la incorporación de la pirólisis como tratamiento para añadir el negro de carbón recuperado y el aceite obtenido a nuevos procesos.
La Fundación Biodiversidad del Ministerio para la Transición Ecológica y el Reto Demográfico (MITECO), ha lanzado una nueva convocatoria de subvenciones para el impulso de la economía circular en el sector del plástico, en el marco del PERTE de Economía Circular del Plan de Recuperación, Transformación y Resiliencia (PRTR), financiado por la Unión Europea - NextGenerationEU. Su dotación es de 97,5 millones de euros y permitirá financiar las mejores iniciativas seleccionadas, con importes que van desde 100.000 euros hasta 10 millones por proyecto y entidad beneficiaria. Esta convocatoria, conforme con la Estrategia europea para el plástico en una economía circular y la Estrategia Española de Economía Circular, busca prevenir el uso de materiales, reducir la presencia de aditivos con sustancias contaminantes, evitar la liberación no intencionada de microplásticos, fomentar el reciclaje y la valorización material de los residuos, y promover modelos circulares, bajo parámetros de ecodiseño y coordinando esfuerzos.
Asimismo, la convocatoria incluye la adquisición de herramientas digitales con el propósito, por ejemplo, de incorporar marcas de agua para ciclos cerrados de polietileno de tereftalato (PET) de calidad alimentaria, el uso de visión artificial para la separación de siliconas o el apoyo a las tecnologías de circuito cerrado y control de stocks para favorecer la reutilización y logística inversa. El plazo de presentación de candidaturas se extenderá hasta el 23 de septiembre. Está previsto que la convocatoria se resuelva en el primer trimestre de 2025. Los proyectos seleccionados deberán concluir, como máximo, el 30 de octubre de 2027.



Koopera, empresa de innovación social y medioambiental con 34 años de historia, recoge, prepara y clasifica 17.200Tn de textil post-consumo al año generando empleo para personas en situación o riesgo de exclusión social.


La correcta gestión de los residuos textiles se ha convertido en un tema crucial en la conversación global sobre la sostenibilidad. Cada año, millones de toneladas llegan a vertederos en todo el mundo y la economía circular se muestra como una estrategia prioritaria para afrontar esta problemática. Desde hace años, las empresas de inserción, como, Koopera y otras promovidas por Cáritas bajo la marca Moda re-, están desempeñando un papel clave en esta valorización de los residuos textiles y son, además, ejemplo de integración de los tres pilares de la sostenibilidad: económico, social y medio ambiental.
Koopera cuenta actualmente con 2.171 contenedores de recogida de residuo textil para uso de la ciudadanía en más de 500 municipios. Cada año, la empresa recoge, prepara y clasifica 17.200Tn de textil post-consumo, una labor con la que, además de beneficiar al medio ambiente, se genera un impacto social y económico positivo, creando puestos de trabajo para personas en situación o riesgo
Las empresas de inserción como Koopera desempeñan un papel crucial en la creación de empleo y en la promoción de la inclusión social, siendo un agente de gran importancia en la gestión de residuos desde sus inicios



de exclusión social y asegurando un salario digno y un puesto de trabajo conforme a los convenios colectivos generales. Esto reduce la dependencia de las prestaciones económicas públicas.
Las empresas de inserción como Koopera desempeñan un papel crucial en la creación de empleo y en la promoción de la inclusión social, siendo un agente de gran importancia en la gestión de residuos desde sus inicios. De hecho, en España, alrededor de la mitad de los residuos textiles recogidos separadamente son gestionados por estas empresas de inserción. Su papel es esencial para una economía que aspira a ser verdaderamente circular y equitativa y promueven, además, la consecución de los Objetivos de Desarrollo Sostenible (ODS).
Koopera cuenta actualmente con 2.171 contenedores de recogida de residuo textil para uso de la ciudadanía en más de 500 municipios. Cada año, la empresa recoge, prepara y clasifica 17.200Tn de textil post-consumo, una labor con la que, además de beneficiar al medio ambiente, se genera un impacto social y económico positivo
EL MARCO NORMATIVO Y SU PAPEL EN EL IMPULSO DE LAS EMPRESAS DE INSERCIÓN Y LOS VALORES QUE REPRESENTAN
En este contexto, la Unión Europea ha reconocido ya la relevancia de la economía social en la economía circular, particularmente en la gestión de residuos textiles. La Directiva 2014/24/ UE fue un paso significativo al reservar determinados contratos públicos
para empresas cuyo principal objetivo sea la integración social y profesional de personas en situación de vulnerabilidad. En España, la Ley de Contratos del Sector Público incluyó en su anexo VI los servicios de recogida y reciclaje, y la Ley 7/2022 prioriza la contratación de estos servicios a empresas de inserción o centros especiales de empleo de iniciativa social. Actualmente, las negociaciones sobre la Directiva Marco de Residuos
de 2018 buscan reforzar el papel de la economía social dentro de la responsabilidad ampliada del productor, especialmente en el ámbito de los residuos textiles y es un momento determinante para que las Administraciones Públicas apoyen y promuevan el papel preferente de las empresas de inserción, dentro de dicha modificación de la Directiva, en la transición hacia una economía socialmente justa para ser, realmente, una economía circular.
KOOPERA www.koopera.org

Fuente: Global Waste Management Outlook 2024: Beyond an age of waste – Turning rubbish into a resource. Programa de Medio Ambiente de Naciones Unidas e ISWA.
La generación de residuos y las prácticas de gestión de residuos continúan como hoy, y se proyecta que la generación de residuos crecerá más rápidamente en regiones sin capacidad adecuada de gestión de residuos.
Un punto intermedio, con algunos avances en la prevención de residuos y la mejora de su gestión. Las políticas gubernamentales y las acciones de los productores avanzan hacia la eliminación de residuos; la generación de residuos se desvincula del crecimiento económico para 2030. Aumentan las inversiones en prevención y gestión de residuos; la cobertura de recogida aumenta al 100% en 2050; el reciclaje aumenta proporcionalmente con otros métodos de tratamiento; el vertido no controlado termina en 2050.
La generación de residuos está desvinculada del crecimiento económico: la tasa mundial de reciclaje de residuos sólidos urbanos alcanza el 60% y el resto se gestiona de forma segura. Las políticas gubernamentales y las acciones de los productores conducen a una adopción generalizada del ecodiseño y la reutilización, eliminando aún más la producción de residuos; la generación de residuos cae a los niveles de 2020 para 2050. La cobertura de recogida es del 100%; las tasas de reciclaje de residuos sólidos urbanos aumentan al 60% en 2050; el vertido no controlado de estos residuos termina en 2050.
EN PRIMERA PERSONA
La gestión y el tratamiento de los residuos municipales continúa siendo un servicio público cuyo coste real nadie, o casi nadie, quiere poner sobre la mesa. Urge explicar a la ciudadanía los costes asociados a la gestión de sus residuos.

LJAVIER DOMÍNGUEZ PRESIDENTE DE SOGAMA
a gestión y el tratamiento de los residuos municipales parece seguir siendo el servicio público cuyo coste real nadie, o casi nadie, quiere poner sobre la mesa, y ello a pesar de tratarse de un servicio básico y esencial para la ciudadanía que, de no prestarse debidamente, generaría un problema sanitario de primera mag-
nitud y comprometería la viabilidad de cualquier otra acción ambiental que quiera llevarse a cabo para combatir el cambio climático.
Siendo conscientes de su alcance y repercusión, lo cierto es que continúa sin ser un servicio debidamente valorado. De hecho, en muchas ocasiones no tiene ni siquiera un reflejo como tal en los presupuestos de las admi-


EN PRIMERA PERSONA
LA GESTIÓN Y EL TRATAMIENTO DE LOS RESIDUOS MUNICIPALES PARECE SEGUIR
SIENDO EL SERVICIO PÚBLICO CUYO COSTE REAL NADIE, O CASI NADIE, QUIERE PONER
SOBRE LA MESA, Y ELLO A PESAR DE TRATARSE DE UN SERVICIO BÁSICO Y ESENCIAL PARA LA CIUDADANÍA
nistraciones, camuflándose o complementándose con partidas destinadas a otros menesteres.
Si bien todos coincidimos en su importancia crucial para el bienestar, la salud y la calidad de vida, cuando se trata de traducir la correcta gestión de nuestros desechos en cifras económicas, cualquier precio que se ponga a esta actividad, por modesto que sea, parece desmesurado, representando para los entes locales una quimera que hay que maquillar e incluso ocultar, cuando, en realidad, gestionar residuos de forma sostenible tiene un coste con nombre propio.
La pregunta que nos hacemos desde hace mucho tiempo aquéllos que pertenecemos al sector de los residuos es por qué la gestión y el tratamiento de los mismos no tiene entidad propia, por qué las tarifas que pagamos los ciudadanos nos parecen siempre excesivas, aunque resulten claramente insuficientes para cubrir los costes, y por qué a las administraciones que tienen las competencias en materia
de residuos les parece desmesurado el canon que abonan a las plantas de tratamiento, cuando éstas operan desde el máximo cumplimiento de la legislación vigente y con alto estándares de eficiencia.
Hemos entrado en una espiral, que no es precisamente la de la economía circular, que nos ha condenado a no valorar la correcta gestión de los residuos porque parece haberse interiorizado la falsa creencia de que desaparecen por arte de magia, cuando la magia está en el esfuerzo y la labor diaria de cientos de empresas de recogida y gestión, y de miles de trabajadores que, en la mayor parte de los casos, operan las 24 horas del día y los 365 días del año para que, jornada tras jornada, los ciudadanos encuentren los contenedores vacíos y listos para acoger nuevos residuos.
Pero, a diferencia de otros servicios como pueden ser la luz, el agua, internet, telefonía, etc, el del tratamiento los residuos no nos hace disfrutar de algo en concreto, sino que retira de
HEMOS ENTRADO EN UNA ESPIRAL, QUE NO ES PRECISAMENTE LA DE LA ECONOMÍA CIRCULAR, QUE NOS HA CONDENADO A NO
VALORAR LA CORRECTA GESTIÓN DE LOS RESIDUOS PORQUE
PARECE HABERSE INTERIORIZADO LA FALSA CREENCIA DE QUE
DESAPARECEN POR ARTE DE MAGIA
nuestra vista y elimina lo que nos incomoda o lo que podría hacernos daño, pero que no percibimos de forma nítida, quedando casi relegado a la inexistencia, salvo en circunstancias puntuales como pueden ser los conflictos y huelgas en el servicio, momento en el que la basura emerge y crece por doquier, inundando calles y establecimientos, y removiendo conciencias que piden a gritos que se restablezca un servicio que hasta ese preciso instante pasaba desapercibido.
La ley 7/2022, de 8 de abril, de residuos y suelos contaminados para una economía circular recoge expresamente que, a partir de 2025, los ayuntamientos quedarán obligados a repercutir el coste real del servicio en las tasas ciudadanas. Entretanto, las plantas de tratamiento se han visto obligadas a actualizar el canon que cobran a sus clientes, los ayuntamientos, por la lesión económica que las medidas estatales han ocasionado sobre sus cuentas. Me refiero, en el caso de Sogama, al impuesto a la valorización energética y al vertedero, a la supresión de la retribución a la inversión de la planta termoeléctrica, comprometida hasta el año 2026, cuando finalizaría su vida útil, a la disminución de la retribución a la explotación de la planta de cogeneración en el segundo semestre de 2023 y a la recuperación del impuesto energético del 7%. Todo ello se ha traducido
en un desequilibrio económico para la empresa pública de 21,9 millones de euros en 2023 y unas pérdidas de 18 millones, cuando en los últimos años la compañía había obtenido beneficios con los que pudo realizar inversiones por importe de 100 millones de euros. Entre éstas, cabría destacar la puesta en marcha de un planta para la recuperación de los materiales contenidos en la basura en masa, que opera en línea con la industria 4.0, y que nos ha permitido incrementar la capacidad de tratamiento del Complejo Medioambiental de Cerceda (A Coruña) en un 81%, llegando a 1 millón de toneladas anuales, además de incrementar nuestra aportación al reciclaje, así como construir y poner en marcha una red de infraestructuras para la valorización de la materia orgánica recogida de forma diferenciada a través del contenedor marrón, conformada por 17 instalaciones: 4 plantas de biorresiduos, una por cada provincia gallega, y 13 plantas de transferencia de apoyo a las que se ha dotado con una tolva específica para el trasvase de la fracción orgánica.
La pretensión última de esta infraestructura ha sido precisamente ayudar a los ayuntamientos, que son los que tienen las competencias en el ámbito de los residuos, a cumplir la legislación europea, que exigía que, a partir del 31 de diciembre de 2023, los municipios tuviesen implantada la recogida separada de la materia orgánica. Esta red de instalaciones se complementó con un programa específico de compostaje doméstico, liderado por Sogama en Galicia, en el marco del cual esta empresa repartió de forma gratuita, entre ayuntamientos, centros educativos y colectivos sociales, más de 22.000 compostadores, además de impartir la formación y editar material divulgativo de apoyo. La iniciativa, especialmente orientada al rural gallego, con una gran dispersión poblacional, pretendía que el autocompostaje fuese la opción a seguir por las familias para el tratamiento de sus residuos orgánico, evitando de esta forma una contenerización desproporcionada y una recogida con un coste económico exacerbado debido a las grandes distancias a recorrer,
más allá del impacto medioambiental originado por las propias emisiones de CO 2 a la atmósfera.
Aunque ya han surgido experiencias en el pago por generación, que sería el sistema más justo, lo cierto es que su verdadera implantación requerirá de tiempo e inversiones, además de formación y sensibilización. Lo realmente importante es que los ciudadanos se vean recompensados por su esfuerzo en la reducción de la producción de residuos y en la segregación de los mismos para posibilitar su posterior recuperación y reciclaje, y que también conozcan el trabajo de sus ayuntamientos, así como el de las empresas de recogida y tratamiento por dar la mejor gestión a esos desechos. La transparencia contribuirá a arrojar luz sobre un servicio que adolece muchas veces de oscurantismo y escaso interés, cuando realmente su importancia es vital. Es por ello que urge explicar a la ciudadanía los costes asociados a la gestión de sus residuos y animarla a ser partícipe del sistema para comprender su dimensión. Solo así podrá valorarlo y cuidarlo. La pedagogía es el primer paso a dar.


Con la población cada vez más consciente de los desafíos ambientales a los que nos enfrentamos, la gestión de los residuos y la optimización de los recursos se han convertido en factores imprescindibles para cuidar del planeta y avanzar en el camino hacia la descarbonización. De esta manera, la economía circular emerge como una
El Centro Integral de Valorización de Residuos del Maresme, ubicado en Mataró, se encarga de gestionar los residuos municipales de la fracción resto de los 28 municipios de la comarca del Maresme
solución innovadora y responsable con el entorno para reducir al mínimo la generación de residuos, transformando los patrones de producción y consumo de la sociedad.
En este contexto, el Centro Integral de Valorización de Residuos del Maresme, ubicado en Mataró, se encarga de gestionar los residuos municipales de la fracción resto, es decir, de aquellos que no se han podido recoger selectivamente de los 28 municipios de la comarca del Maresme. Esta entidad, dependiente del Consorcio de Residuos del Maresme, está gestionada por la UTE TEM y participada en un 47% por Veolia, compañía líder en descarbonización, economía circular y gestión optimi -
En la actualidad, Maresme Circular, la marca del Consorcio de Residuos del Maresme, desarrolla distintas iniciativas para avanzar en su camino hacia la sostenibilidad
zada de los residuos y que cada año gestiona 200.000 toneladas de residuos provenientes de la fracción resto del Maresme y el Vallés Oriental para una población aproximada de un millón de habitantes.
Especializado en el tratamiento de residuos sólidos urbanos e industriales, este Centro Integral de Valoriza-
ción de Residuos intenta dar una segunda vida a estos desechos a través de sus plantas de selección, compostaje, metanización y recuperación energética. Es decir, el Centro no solo se dedica a la recuperación de materiales reciclables, sino que también genera energía eléctrica a partir de la valorización energética de materiales no

El Centro Integral de Valorización de Residuos del Maresme no solo se dedica a la recuperación de materiales reciclables, sino que también genera energía eléctrica a partir de la valorización energética de materiales no reciclables
reciclables, evitando que terminen en los vertederos.
En la actualidad, Maresme Circular, la marca del Consorcio de Residuos del Maresme, desarrolla distintas iniciativas para avanzar en su camino hacia la sostenibilidad. Entre ellas destacan la reciente investigación sobre la viabilidad de crear energía renovable a partir de la biomasa forestal del Parque del Montnegre y el Corredor; el proyecto para aprovechar las aguas residuales procedentes de la Estación Depuradora de Aguas Residuales de Mataró y utilizarlas en los procesos de tratamiento de residuos; o la instalación en la chimenea de la incineradora de una caja-nido para facilitar la cría del halcón peregrino y así preservar la biodiversi-
dad de la zona. Estas acciones remarcan el compromiso de la entidad por proteger los entornos naturales e impulsar la regeneración de los recursos.
La descarbonización del planeta se ha convertido en el objetivo primordial para muchas infraestructuras industriales. En el Centro Integral de Valorización de Residuos llevan más de un año promoviendo un riguroso plan de descarbonización global motivado por un proyecto normativo para las plantas de valorización energética de Cataluña
que exige, para el año 2035, lograr una reducción de la huella de carbono del 50% en relación con el año 2020.
El objetivo de Maresme Circular es ir más allá de lo que se establece en el marco regulatorio catalán. Por ello, prevén reducir casi el 80% de las emisiones de CO₂ fósil en el conjunto del centro y en torno a un 70% del total de emisiones (de origen fósil y biogénico). Para garantizar este objetivo, están desarrollando cuatro sub-proyectos estratégicos encaminados a mejorar la separación de los residuos plásticos que llegan al Centro, multiplicar por cinco la producción de biometano y reducir a la mitad el rechazo destinado a vertedero, mantener la autosuficiencia energética del Centro


tar con la experiencia, capacitación y know-how tecnológico de una empresa líder como Veolia para alcanzar nuestros objetivos de descarbonización”, señala el director de Maresme Circular, Carles Salesa.
mediante la renovación de su Planta de Valorización Energética y, por último, la creación de una Planta de captura, purificación, licuefacción y almacenaje de las emisiones de CO2 del Centro Integral de Valorización de Residuos del Maresme.
En la actual fase preliminar del plan y desde el conocimiento de la instalación actual en operación para con-
El objetivo de Maresme Circular es ir más allá de lo que se establece en el marco regulatorio catalán. Por ello, prevén reducir casi el 80% de las emisiones de CO₂ fósil en el conjunto del centro y en torno a un 70% del total de emisiones VEOLIA www.veolia.es MARESME CIRCULAR www.maresmecircular.cat
seguir instalaciones más sostenibles, resulta idóneo contar con la ayuda de una empresa como Veolia, capaz de diseñar soluciones innovadoras y personalizadas que garanticen un uso optimizado de los recursos, promover prácticas energéticas eficientes y fomentar un ciclo de producción más responsable con el entorno. “Para nosotros es muy importante poder con-
Maresme Circular, junto a la ayuda de una empresa líder en la transformación ecológica del planeta como Veolia, se consolida como un referente en el impulso de la economía circular al gestionar de manera eficiente y responsable con el entorno y las generaciones futuras los residuos municipales.

Cross Wrap es mundialmente conocida por sus embaladoras de balas eficientes, fiables y de alta calidad. La embaladoras de balas CW 2200 ha establecido el estándar en la industria de conversión de residuos en energía y manipulación de residuos. La CW 2200 ahora está en transición para ser completamente eléctrica, mejorando su rendimiento y confiabilidad.
VENTAJAS DE UN FUNCIONAMIENTO TOTALMENTE ELÉCTRICO
Eficiencia energética mejorada: Los motores eléctricos de la encintadora de balas CW 2200 optimizan el consumo energético dirigiéndolo precisamente hacia donde se necesita, lo que redu-
ce significativamente el uso de energía. Esto hace que la CW 2200 eléctrica sea aún más eficiente que sus predecesores. Funcionamiento más silencioso: los motores eléctricos funcionan de forma más silenciosa que las bombas hidráulicas, lo que reduce los niveles generales de ruido y crea un entorno de trabajo más seguro y agradable.
Mayor confiabilidad: los motores eléctricos localizan las fallas potenciales, minimizando el tiempo de inactividad y los costos de mantenimiento. Este diseño modular garantiza menor necesidad de mantenimiento: sin sistemas hidráulicos, no hay necesidad de cambios regulares de aceite ni reemplazos de filtros, lo que reduce los costos operativos y de mantenimiento generales.
EL ESTÁNDAR DE LA INDUSTRIA PARA EMBALAR RESIDUOS
Con la confianza de más de 23 marcas diferentes de prensas en 60 países, la embaladora de balas CW 2200 está diseñada para un manejo, transporte y almacenamiento de balas más inteligentes y confiables. La tecnología única de Cross Wrap optimiza el consumo de film, asegurando una producción rentable y una integración flexible en los sistemas existentes.




ENTREVISTA O
PRESIDENTE
Alberto Casillas
El desafío de avanzar en la gestión sostenible de los residuos en España pone sobre la mesa la necesidad acuciante de impulsar políticas y soluciones que aceleren un cambio de modelo que permita el fin del uso masivo del vertido y la transición hacia una economía circular. En este contexto, la valorización energética de residuos emerge como una palanca imprescindible para cumplir con los ambiciosos objetivos de la Unión Europea. Hablamos con Joaquín Pérez Viota, presidente de la Asociación de Empresas de Valorización Energética de Residuos Urbanos (Aeversu), para conocer su visión sobre el futuro de la gestión de residuos en España. En esta entrevista, nos comparte también su perspectiva sobre los desafíos actuales del sector y las palancas necesarias para impulsar un cambio de paradigma significativo en nuestro país.
Primero de todo nos gustaría felicitarle por su nuevo puesto al frente de Aeversu, le deseamos lo mejor en este nuevo rol dentro de la Asociación. Para comenzar nos gustaría saber más sobre su trayectoria en el sector, ¿dónde ha desarrollado su carrera profesional y cuál es su posición actual?
Muchísimas gracias. Mi formación es la de ingeniero de Caminos, Canales y Puertos, y comencé mi actividad en el proceso de diseño y construcción del complejo de tratamiento integral de residuos de Cantabria hace ya 25 años. Desde
ese momento y hasta la actualidad he desarrollado la totalidad de mi carrera profesional en el ámbito de la gestión de los residuos, pasando desde la dirección de explotación de las instalaciones de Cantabria, a la dirección general de la misma a partir del año 2014. Anteriormente, durante el periodo del 2011 al 2013, tuve la responsabilidad de la dirección general de la planta de tratamiento integral de residuos de Marsella, en Francia.
¿Qué objetivos se plantea en esta nueva etapa al frente de Aeversu?
En esta etapa nos proponemos dar soporte y promover la valorización energética como una herramienta clave, de acuerdo con los principios de la jerarquía de tratamiento de
Es necesario el reconocimiento de la valorización energética como una fuente de energía sostenible a nivel nacional y europeo

residuos establecidos por la Unión Europea, para cumplir con los objetivos de reducción de residuos enviados a vertederos y contribuir así a minimizar el impacto medioambiental. Es necesario el reconocimiento de la valorización energética como una fuente de energía sostenible a nivel nacional y europeo. Además, estamos comprometidos con mejorar la eficiencia de nuestras instalaciones actuales -11 en España, y una en Andorra- y explorar oportunidades estratégicas para un crecimiento responsable. Nuestros esfuerzos se centran en fortalecer el papel económico y social de nuestras plantas en las comunidades locales, asegurando que aporten un valor añadido. Buscamos la integración de
la valorización energética en la agenda de sostenibilidad de España, asegurando un impacto positivo en las comunidades a las que servimos.
Aunque acaba de aterrizar en la presidencia de a asociación, como nos ha detallado cuenta con una dilatada experiencia en la industria. ¿Cuál es la situación actual de la valorización energética en España?
Creo que antes de exponer la situación de la valorización energética en España, es necesario hacer ver la situación del

Buscamos la integración de la valorización energética en la agenda de sostenibilidad de España, asegurando un impacto positivo en las comunidades a las que servimos

tratamiento de residuos en nuestro país. Eliminamos actualmente 10,4 millones de toneladas de residuos en vertederos, lo que representa un 47% del total de residuos generados. Nuestro país es responsable del 20% de los residuos enviados a vertedero en toda la Unión Europea (UE). Frente a este porcentaje, tan solo se valorizan energéticamente un 11% del total. Hay que señalar que mientras que en la Unión Europea el porcentaje de residuo eliminado en vertedero es del 24,6%, son valorizados energéticamente el 26,4% de los residuos generados.
Hay que destacar que los países con mayor madurez medioambiental, como Alemania, Austria, Países Bajos y Dinamarca, que cuentan con los porcentajes de reciclaje más elevados de la Unión, entre el 58 y el 68%, tienen tasas de valorización energética que oscilan entre el 30% y el 40%. En estos países, los residuos no reciclables enviados a vertederos son prácticamente inexistentes.
Según su visión, ¿cuáles considera son los principales desafíos que enfrenta el sector en nuestro país en la actualidad?
Enfrentamos un futuro que promete ser una época de transformaciones profundas en la gestión de residuos, impulsadas por la innovación y el compromiso ambiental. La valorización energética se presenta como un componente esencial para alcanzar un modelo de economía circular sostenible, promoviendo la reducción de residuos enviados a vertederos y la recuperación energética. Antes de llegar al 2035, todos los estados miembros deberán reciclar al menos el 65% de los residuos producidos, y eliminar en vertedero menos del 10%.
No podemos olvidar el desafío que supone la gestión de los gases de efecto invernadero y los costes asociados con la
JOAQUÍN PÉREZ VIOTA, AEVERSU
La propuesta de una moratoria al impuesto sobre la valorización energética puede incentivar prácticas más sostenibles y económicamente viables
emisión de metano en los vertederos. Una planta de valorización energética tiene unas emisiones netas de gases de efecto invernadero un 245% inferiores a las generadas por un vertedero.
Es crucial iniciar un debate nacional en España sobre el incremento de la capacidad de valorización energética. Esta necesidad está alineada con los objetivos europeos de minimizar el uso de vertederos y maximizar la reutilización y el reciclaje de residuos. Además, la propuesta de una moratoria al impuesto sobre la valorización energética puede incentivar prácticas más sostenibles y económicamente viables, tomando como ejemplo las medidas adoptadas por los países escandinavos en este sentido.
¿Qué palancas considera necesarias para producir un cambio de tendencia en nuestro país?
Además de incrementar la capacidad de reciclado de materiales, en línea con los objetivos fijados por la Unión Europea,
Los países con mayor madurez medioambiental, como Alemania, Austria, Países Bajos y Dinamarca, que cuentan con los porcentajes de reciclaje más elevados de la Unión, tienen tasas de valorización energética que oscilan entre el 30% y el 40%
El balance neto de emisiones de CO2e/t de residuo valorizado energéticamente es un 245% inferior al generado por su eliminación en un vertedero
es esencial duplicar la capacidad de tratamiento de aquellos residuos no reciclables mediante valorización energética, para reducir la cantidad de residuos que terminan en los vertederos, y de esta manera cumplir con los objetivos de reducción. Esto no solo disminuiría las emisiones de gases de efecto invernadero, sino que también aprovecharía la energía de los residuos no reciclables, como una fuente de energía local y renovable. No podemos olvidar que entre el 65 y el 70% de la energía generada en el proceso de valorización energética del residuo no reciclable procede de fuentes biogénicas.
Por último, las políticas nacionales deben estar alineadas a las directivas de la Unión Europea, que establecen objetivos claros para la reducción de residuos en vertederos. Implementar estas palancas ayudará a transformar la gestión de residuos en España, avanzando hacia un futuro más sostenible.
La valorización energética de residuos aporta beneficios significativos en materia de gestión de residuos y transición energética. ¿Qué papel debe tener la valorización energética en la consecución de la senda marcada por Europa para acelerar en economía circular y la transición hacia energías renovables y autóctonas?
La valorización energética debe ser un componente clave en la estrategia de España para avanzar en la economía circular y la transición energética, contribuyendo a la sostenibilidad ambiental, la seguridad energética y el desarrollo socioeconómico del país. Juega un papel crucial en la consecución de la senda marcada por Europa para acelerar la economía circular y la transición hacia energías renovables y autóctonas. Además, permite transformar los residuos municipales no reciclables en energía eléctrica y térmica, lo que incluye calefacción y agua caliente. Este proceso reduce significativa-
mente las emisiones de metano, un gas con un potencial de calentamiento global muy superior al CO2, que se generarían si estos residuos fueran depositados en vertederos.
Las instalaciones de valorización energética de Aeversu tratan aproximadamente 2,5 millones de toneladas de residuos no reciclables al año y generan 2.000 GWh al año. Además, suministran una energía eléctrica equivalente a las necesidades de 600.000 hogares, 1,6 millones de habitantes, el 3,5% de la población española.
La transformación de residuos en energía también representa una fuente autóctona y renovable (entre un 65% y 70%), lo cual contribuye a reducir la dependencia de fuentes externas de energía y la necesidad de importación.
Teniendo en cuenta este potencial, ¿qué beneficios aporta a nivel ambiental y de desarrollo económico en las comunidades locales y regionales? ¿podría exponernos algunos ejemplos reales?
Ambientalmente, al disminuir la cantidad de residuos destinados a vertederos, se reducen significativamente las emisiones de metano y la contaminación del suelo y aguas subterráneas. A diferencia de los vertederos, que son una fuente importante de gases de efecto invernadero, la valorización energética minimiza estas emisiones. De esta forma, el balance neto de emisiones de CO2e/t de residuo valorizado energéticamente es un 245% inferior al generado por su eliminación en un vertedero.
Económicamente, la valorización energética fomenta el uso eficiente de los recursos y avanza hacia sistemas energéticos con emisiones netas cero. Esto reduce la dependencia de fuentes externas de energía. Además, genera empleo de calidad, proporcionando trabajo estable y cualificado a más de 2.500 personas en España.
En el norte de Europa disponemos de un amplio abanico de ejemplos que muestran claramente el camino a seguir. Tenemos el caso de Copenhague, que alberga la primera
planta de valorización energética con una pista de esquí, Copenhill, que tiene previsto ser neutra en carbono en 2025 gracias a su captura y almacenamiento. En Francia, alrededor del 50% de la red de calefacción urbana de París se abastece de las tres plantas de conversión de residuos en energía de la ciudad. En Alemania, gracias a la gestión de los residuos no reciclables en la instalación de Wuppertal, se genera hidrógeno para alimentar los autobuses de transporte público.
En España tenemos también muy buenos ejemplos para tener en cuenta. TERSA en Sant Adrià de Besòs (Barcelona), una de las instalaciones asociadas a Aeversu, suministra energía térmica a la red de climatización urbana de calor y frío, que da servicio a más de 180 edificios de las zonas Fòrum y 22@ de la ciudad de Barcelona, para su utilización en calefacción, climatización y agua caliente sanitaria.
¿Cuáles son los hitos más significativos alcanzados por el sector en los últimos tiempos?
JOAQUÍN PÉREZ VIOTA, AEVERSU
Hemos trabajado una estrategia para dar solución al problema de los vertederos de residuos en España y, al mismo tiempo, generar energía que se aprovecha en viviendas y en la propia industria.
Recientemente, Aeversu ha cumplido 25 años desde su creación. En este periodo, las instalaciones de valorización energética asociadas han tratado 55 millones de toneladas de residuos no reciclables que se han convertido en energía, evitando así su depósito en vertederos.
Mirando al futuro, ¿se consideran optimistas respecto al desarrollo del sector en España?
El futuro de la gestión de residuos se encamina hacia la integración de tecnologías limpias y eficientes. La valorización energética es un paso clave en esta dirección, ofreciendo una solución viable para mitigar el impacto ambiental de los residuos y avanzar hacia un futuro más sostenible.

El proyecto CHEMUP III, liderado por AITEX, ofrece una solución innovadora y sostenible para el reciclaje químico de residuos textiles posconsumo.
En un mundo cada vez más consciente de la necesidad de proteger el medio ambiente, AITEX presenta el proyecto CHEMUP III como una solución innovadora y sostenible para el reciclaje de residuos textiles.
El objetivo general del presente proyecto es la validación e implementación del reciclado químico de residuos textiles posconsumo a escala piloto, un hito importante en la industria textil. En concreto se centra en el estudio y optimización del reciclado químico de residuos de poliéster y algodón, materiales comunes que a menudo terminan en vertederos. Sin embargo,

Residuo textil 100% PET Monómero contaminado
Residuo textil granceado
Residuo textil triturado Monómero purificado PET virgen
POLIMERIZACIÓN
DEPOLIMERIZACIÓN
CHEMUP III se centra en el estudio y optimización del reciclado químico de residuos de poliéster y algodón, materiales que a menudo terminan en vertederos
a través de procesos químicos avanzados, estos materiales se descomponen y transforman en fibras recicladas y otros productos textiles de uso cotidiano, reduciendo la cantidad de residuos y proporcionando una nueva vida a estos materiales.
Además de estos objetivos técnicos, AITEX también busca con el proyecto CHEMUP III la transferencia de conocimiento para crear una industria textil más sostenible. Esto incluye la identificación del mercado a nivel mundial, europeo, nacional y regional para encontrar oportunidades que permitan implementar estas tecnologías de reciclaje y fomentar su adopción entre las empresas involucradas en la cadena de valor.
Durante este proyecto que ha desarrollado AITEX, se ha llevado a cabo el reciclaje químico del PET mediante glicólisis en la que se obtiene el monómero (BHET) con una pureza de alrededor del 99% y posteriormente, a este monómero, se le realiza la polimerización y se obtiene el rPET con rendimientos del 70-90%. En dicha reacción, se ha encontrado un catalizador que reduce un 33% el tiempo de reacción, lo que supone un ahorro en el consumo de energía. En cuanto al proceso de purificación, se ha validado un pretratamiento mecánico con carbón activo que mejora el grado de blanco del BHET obtenido y elimina contaminantes de origen inorgánico.




Además, la polimerización de poliéster a partir de BHET se ha llevado a cabo con éxito, obteniendo un poliéster reciclado químicamente con propiedades reológicas adecuadas para la obtención de nuevas fibras recicladas.
Por otro lado, en cuanto al reciclado químico de residuos textiles de algodón, se han utilizado los líquidos iónicos (IL) que han demostrado ser disolventes eficientes para los materiales de base celulósica, pudiéndose utilizar

El proyecto CHEMUP III cuenta con el apoyo de la Conselleria d’Economia Sostenible, Sectors Productius, Comerç i Treball de la Generalitat Valenciana, a través del IVACE


para el reprocesamiento químico de algodón. Esta estrategia ha permitido el reciclado de fibras de algodón empleando un proceso de hilatura en húmedo (dry jet wet spinning) y un baño de coagulación de agua fría. También se ha optimizado el proceso de preparación del dope, formado por la disolución de algodón en el líquido iónico, suponiendo un avance en la obtención de fibras de algodón recicladas con propiedades mecánicas similares a las del algodón virgen.
Se espera que este proyecto de AITEX inspire a buscar otras formas innovadoras de evolucionar las industrias a más sostenibles. El proyecto CHEMUP III acerca a la sociedad un paso más hacia ese futuro.



GUIOMAR RUBIO, DIRECTORA EN G-ADVISORY JAVIER FERNÁNDEZ, SOCIO EN GARRIGUES
Aescasos meses de que se cumplan dos años desde su aprobación, el Real Decreto de Envases (RD 1055/2022) sigue representando un punto de inflexión en la legislación ambiental española, especialmente por el refuerzo que introdujo en el régimen de la responsabilidad ampliada del productor y su extensión a todos los envases, incluidos los comerciales y los industriales. Una norma que nació con la encomiable finalidad de avanzar hacia una economía más circular previniendo la generación de residuos de envases y fomentando acciones y medidas que promovieran la reutilización, el reciclado y otras formas de valorización de acuerdo con el principio de jerarquía.
Con las miras puestas en esos fines, el real decreto introdujo un amplio conjunto de objetivos de prevención para el horizonte 2030, como reducir en un 15 % el peso de los residuos de envases respecto de los generados en 2010, conseguir que para entonces todos los envases puestos en el mercado fueran reciclables y, a ser posible, reutilizables, o minorar en un 20 % el número de botellas de plástico de un solo uso para bebidas.
También introdujo nuevos objetivos de reutilización aplicables a los envases de bebidas, como que para 2030 el 40 % de los envases de agua embotellada, el 85 % de los de cerveza o el 70 % de los de refrescos puestos en el mercado
DECRETO VINO A
EN PROFUNDIDAD DE LOS
DE NEGOCIO DE LAS EMPRESAS PRODUCTORAS Y ENVASADORAS. LA NECESIDAD DE INCORPORAR DISEÑOS DE ENVASES SOSTENIBLES, SISTEMAS LOGÍSTICOS EFICACES O NUEVAS TECNOLOGÍAS DE RECICLAJE EFICIENTES SON SÓLO ALGUNOS
EJEMPLOS DE LAS ADAPTACIONES QUE LA NUEVA NORMA INTRODUJO
a través del canal HORECA sean reutilizables, o que en el mismo horizonte dichos porcentajes sean del 10 % en el canal doméstico. Y no menos ambiciosos fueron los objetivos de reciclado y valoración, pues el real decreto ordenó que en 2025 se reciclara un mínimo del 65 % en peso de todos los residuos de envases y que en 2030 ese porcentaje fuera del 70 %, estableciendo para cada uno de esos límites temporales, además, unos concretos objetivos mínimos en peso de reciclado para materiales como el plástico, el vidrio, el papel o el cartón, entre otros.
Asimismo, como parte de su responsabilidad ampliada, la norma impuso expresamente a los productores la obligación de adoptar las medidas necesarias para contribuir al cumplimiento de esos objetivos de prevención y reutilización, así como, directamente, alcanzar los de reciclado. Y todo ello aparte de muchas otras obligaciones que también les
atribuyó, como financiar y organizar la recogida y tratamiento de los residuos de envases o establecer sistemas de depósito, devolución y retorno de los envases reutilizables que pusieran en el mercado. En suma, desde una perspectiva económica y operativa, el real decreto vino a imponer una revisión en profundidad de los modelos de negocio de las empresas productoras y envasadoras. La necesidad de incorporar diseños de envases sostenibles, sistemas logísticos eficaces o nuevas tecnologías de reciclaje eficientes son sólo algunos ejemplos de las adaptaciones que la nueva norma introdujo.
UNA OPORTUNIDAD PARA LA INNOVACIÓN
Nadie duda de las oportunidades que todo ello ofrece, muy significativamente en dos ámbitos. El primero, la innovación en materiales y en ecodiseño,
campo el que los envasadores ya han dado y siguen dando pasos de gigante que los consumidores observamos a diario y que contribuyen a reducir el impacto ambiental de los envases. Y el segundo, el reciclaje, en el que van cobrando fuerza nuevas técnicas prometedoras, como el reciclaje químico, que permite obtener productos de interés para la industria química orgánica. En los últimos años se observa un interés creciente por los proyectos que emplean la tecnología de pirólisis para el tratamiento de fracciones mezcladas de residuos de envases. Se trata de una tecnología conocida desde principios del siglo XX, pero escasamente extendida aún a escala industrial, y menos aún para el tratamiento de residuos, debido principalmente a la dificultad para alcanzar una rentabilidad económica sobre la base de los ingresos obtenidos tanto por el tratamiento de los residuos como por la venta de los productos generados. Sin embargo, el interés tanto del sector del tratamiento de residuos por encontrar soluciones que reduzcan la fracción rechazo de residuos plásticos y de envases como de las compañías químicas y petroquímicas con objetivos de descarbonización en el medio plazo, unido a las tasas de vertido, está haciendo que estos proyectos aumenten su rentabilidad y susciten el interés de financiadores e inversores.
Lo cierto es que el reciclaje químico puede contribuir a paliar el problema medioambiental de la gestión de la fracción de rechazo de residuos plásticos y envases que actualmente tienen como destino el vertedero. Dado que no todos los plásticos se pueden reciclar con técnicas convencionales de reciclaje mecánico, el químico puede ser una alternativa viable y sostenible. El PET, por ejemplo, es uno de los plásticos susceptibles de esta técnica (de hecho, el PET reciclado o R-PET es un material sostenible y circular porque es totalmente reciclable). No obstante, esta técnica todavía se encuentra en fase de desarrollo por la necesidad de partir de un material muy puro para el proceso y por las altas exigencias de calidad para llegar a obtener la autorización de la Autoridad Europea de Seguridad Alimentaria (EFSA) para su contacto con alimentos. En cualquier caso, representa sin duda una muy buena alternativa para el cumplimiento de los objetivos a los que antes nos referíamos.
Sin perjuicio de que esas oportunidades existen, lo cierto es que la efectiva implementación del Real Decreto de Envases sigue planteando algunas dificultades por una mezcla de desconocimiento de su alcance, cierto déficit regulatorio en lo que a la concreción de algunos aspectos estructurales se refiere, e incluso las dudas que actualmente suscita su futura compatibilidad
con el reglamento europeo de envases que está por llegar (como las relativas a los sistemas de depósito, devolución y retorno o las de reutilización y marcado de productos envasados), las cuales convendría ir aclarando cuanto antes para ganar seguridad jurídica.
Pero quizás el ámbito en el que las dificultades son especialmente acusadas es el relativo a la apertura del mercado a la competencia, pues si bien hasta el momento dos únicos SCRAPs de envases han venido copando en la práctica la actividad, lo cierto es que la evolución del sector, unida al marco creado por la Ley de Residuos y el Real Decreto de Envases, han favorecido la aparición natural de nuevos sistemas colectivos.
Al margen de que la realidad está demostrando que las administraciones públicas no disponen de los medios necesarios para resolver con agilidad el grueso de las autorizaciones de los pretendidos nuevos SCRAPs, lo cierto es que la misma normativa que propicia esa entrada de nuevos operadores en la actividad es la que carece de la regulación que debería asegurar la correcta articulación entre SCRAPs competidores y la asignación a todos ellos de costes y responsabilidades de forma justa.
De ahí que la CNMC, en su reciente “Estudio sobre la gestión de residuos de envases” (E/CNMC/004/21), haya afirmado que para lograr que exista
LA EFECTIVA IMPLEMENTACIÓN DEL REAL DECRETO DE ENVASES SIGUE PLANTEANDO ALGUNAS DIFICULTADES POR UNA MEZCLA DE DESCONOCIMIENTO DE SU ALCANCE, CIERTO DÉFICIT REGULATORIO EN LO QUE A LA CONCRECIÓN DE ALGUNOS ASPECTOS ESTRUCTURALES SE REFIERE, E INCLUSO LAS DUDAS QUE ACTUALMENTE SUSCITA SU FUTURA COMPATIBILIDAD CON EL REGLAMENTO EUROPEO DE ENVASES QUE ESTÁ POR LLEGAR

competencia real en este sector, es imprescindible que la regulación y las autoridades la promuevan de forma efectiva. Y que, con base en ello, haya realizado cinco recomendaciones muy concretas y relevantes: (i) reducir las barreras de entrada de nuevos SCRAPs a la actividad (facilitando el otorgamiento de autorizaciones, eliminando el plazo previsto para la firma de convenios con las administraciones y flexibilizando los cambios de SCRAP); (ii) establecer un marco de coordinación entre agentes públicos y privados eficiente y procompetitivo (regulando en detalle la coexistencia de sistemas competidores, creando un organismo de coordinación y supervisión, introduciendo un sistema de convenio único con cada administración con compensación financiera entre SCRAPs basada en sus cuotas de mercado, elaborando un convenio tipo a nivel estatal, consensuando entre todos los agentes los requisitos de calidad y dotando a la ad-
ministración de los medios materiales y personales necesarios); (iii) fomentar la transparencia (mejorando la trazabilidad de los residuos de envases y la detección del fraude); (iv) prevenir y remediar los conflictos de interés (por ejemplo, restringiendo la participación de asociaciones y federaciones en los SCRAPs, por los riesgos que plantea de influencia sobre sus asociados y de incremento de conductas anticompetitivas); y (v) fomentar la competencia en la adjudicación de residuos (desarrollando la regulación sobre un siste-
ma electrónico de adjudicación de los residuos de envases).
Los objetivos del Real Decreto de Envases son lo suficientemente trascedentes desde todo punto de vista como para que todos los agentes concernidos pongan de su parte cuanto haga falta para garantizar su consecución. Y para ello quizás sería bueno comenzar por valorar la conveniencia de afrontar en los meses venideros una revisión de la norma que garantice su plena compatibilidad con el futuro reglamento europeo y asuma las recomendaciones de la CNMC.
PASS, solución todo en uno de Palmieri, está destinada a plantas de producción de biogás y biometano para el pretratamiento de los residuos orgánicos municipales y para el desempaquetado de alimentos caducados.
PASS, Palmieri Advanced Splitting System, es una solución “todo en uno” innovadora, compacta y con bajo consumo energético, destinada a plantas de producción de biogás/biometano, ideal tanto para el pretratamiento de los residuos orgánicos FORM como para el desempaquetado de alimentos caducados.
PASS es una solución ya probada y con importantes referencias en Italia y en el extranjero. Son 4 plantas de biogás desde FORM que han adoptado este sistema, tanto en proyectos greenfield como en renovación, con ambos modelos de máquinas actualmente en producción, es decir PASS (180 Kw con rendimiento superior a 15 ton/h) y PASS Light (120 Kw con rendimiento hasta 15 ton/h).
Las maquinas PASS, son monitoreadas constantemente de forma remota para evaluar su eficiencia y rendimiento, así como para planear las intervenciones de servicio; además, las pruebas biológicas realizadas periódicamente para examinar la calidad del material

exprimido y de los materiales separados (plástica y hierro) dan siempre excelentes resultados, conforme a las disposiciones vigentes.
La participación en el III Salón del Gas Renovable permitió a Palmieri entrar en este nuevo e importante mercado en rápido crecimiento, muy sensible a las cuestiones medioambientales y a todas las fuentes de energía renovables. Es en este escenario que el Grupo PALMIERI ha optado por unirse con
PROMAK llegando a España y Portugal. PROMAK Y PALMIERI, entusiastas por el reciente acuerdo, estarán presentes en el próximo Salón del Gas Renovable de Valladolid los días 1 y 2 de octubre y juntos informarán de todas las soluciones innovadoras PASS.





Cada año, el mundo genera más de dos mil millones de toneladas de residuos sólidos urbanos (RSU), un volumen tan vasto que, si se empaquetara en contenedores estándar y se alineara de punta a punta, daría la vuelta al ecuador de la Tierra 25 veces. Este creciente aluvión de desechos no solo refleja el aumento del consumo y la producción, sino también el impacto de nuestras decisiones diarias sobre el medio ambiente. La generación de residuos está profundamente entrelazada con la triple crisis planetaria del cambio climático, la contaminación y la pérdida de biodiversidad. Los residuos municipales, que incluyen productos desechados por hogares, minoristas y pequeñas empresas, son solo una parte de la historia. La actividad humana también produce residuos agrícolas, industriales, de construcción y demolición, y sanitarios, cada uno con sus propios desafíos y efectos sobre el entorno. La gestión de estos residuos es un servicio esencial que, idealmente, debería ser universal, pero en muchos lugares sigue siendo inadecuada o inexistente.
Desde el primer informe de la UNEP sobre “Perspectivas mundiales de la gestión de residuos” publicado en 2015, se ha reconocido la necesidad urgente de una gestión eficiente y sos-
tenible de los residuos para mitigar su impacto en la salud humana y el medio ambiente. Sin embargo, a pesar de algunos esfuerzos, la situación ha empeorado, con una creciente acumulación de residuos y un aumento en la contaminación y las emisiones de gases de efecto invernadero.
Basado en la actualización más reciente de este informe, “Perspectivas mundiales de la gestión de residuos 2024. Más allá de la era de los residuos: Convertir la basura en un recurso”, elaborado por el Programa de las Naciones Unidas para el Medio Ambiente (UNEP) junto con la International Solid Waste Association (ISWA), el presente reportaje explora la compleja realidad de la generación, el crecimiento y la gestión de los RSU, abordando sus impactos ambientales, sociales y económicos; y examina los escenarios futuros para la gestión de residuos, ofreciendo una visión crítica sobre cómo los diferentes enfoques podrían modelar nuestro futuro y qué acciones son necesarias para avanzar hacia una gestión más sostenible y equitativa.
PRESENTE
Generación
A medida que los países se enriquecen, la industrialización y la urbanización aumentan, lo que lleva a cambios en

los patrones de vivienda y consumo y a una mayor comercialización de productos. Esto resulta en un incremento en la cantidad de residuos sólidos urbanos (RSU) generados por persona. Las previsiones futuras de la generación de RSU basadas en el producto interior bruto (PIB) indican que el crecimiento económico seguirá impulsando el aumento de residuos hasta 2050. Aunque existen otros factores relacionados, como el Índice de Desarrollo Humana, la proporción de población
LA GESTIÓN DE RESIDUOS A ESCALA GLOBAL: PRESENTE Y FUTURO
urbana, la renta o las tasas de alfabetización, el PIB per cápita sigue siendo el indicador más preciso.
Considerando esto, cabe destacar que en el año 2020, se generaron aproximadamente 2.100 millones de
toneladas de RSU a nivel mundial; y en vistas del continuo crecimiento económico y demográfico, se prevé un aumento del 56% para 2050, alcanzando los 3.800 millones de toneladas, si no se implementan medidas urgentes. El

REPORTAJE
mayor crecimiento se anticipa en economías en las que se prevé un rápido desarrollo económico y demográfico, particularmente en Asia Central, Meridional y el África Subsahariana, donde la generación de residuos ya está superando la capacidad para gestionarlo. Estos datos subrayan la necesidad de desvincular el crecimiento económico del consumo de recursos y fortalecer la capacidad de gestión de residuos, especialmente en países con mayores dificultades en este ámbito.
La composición de los residuos sólidos urbanos (RSU) varía según los niveles de renta y el grado de urbanización. En los países de renta baja, donde predomina la población rural, la menor necesidad de envases para el transporte de alimentos se traduce en una mayor proporción de residuos alimentarios y una menor presencia de envases en los RSU, como ocurre en África Subsahariana y Sudamérica. En contraste, en las regiones más urbanizadas y con mayores ingresos, como Norteamérica y Europa occidental, los residuos incluyen más envases y productos de un solo uso, reflejando patrones de consumo que priorizan la comodidad. Además, factores como el clima, la densidad de población y las prácticas culturales también influyen en la composición específica de los residuos en cada región.
Gestión
Controlados vs. Incontrolados
A nivel mundial, la gestión de los residuos sólidos urbanos (RSU) muestra una preocupante disparidad entre regiones. En 2020, el 38% de los RSU generados no se gestionaron de manera controlada, lo que implica que fueron vertidos o incinerados al aire


EN
libre, sin ningún tipo de tratamiento adecuado. Este porcentaje de residuos incontrolados es especialmente alto en regiones como el África Subsahariana y Asia Central y Meridional, mientras que en Norteamérica y Europa Occidental casi todos los residuos se gestionan de forma controlada. En Norteamérica, predomina la eliminación en vertederos sanitarios, mientras que Europa Occidental se destaca por sus altas tasas de reciclaje y conversión de residuos en energía. Se prevé que, para 2050, el porcentaje de RSU incontrolados aumente ligeramente al 41%, lo que implicará un incremento alarmante en la cantidad total de residuos incontrolados, de 806 millones de toneladas en 2020 a 1.600 millones de toneladas en 2050.
El acceso a los servicios de recogida de residuos también varía considerablemente entre regiones y dentro de ellas. En las regiones de ingresos más altos, se recoge casi la totalidad de los residuos sólidos urbanos (RSU), mientras que en los países de ingresos más bajos, menos del 40% de los RSU son recogidos. Las áreas con menor cobertura de recogida, como Oceanía, Asia Central y Meridional, y África Subsahariana, también presentan las tasas de urbanización más bajas. Aproximadamente 2.700 millones de personas no tienen
acceso a servicios de recogida de residuos, lo que incluye a 2.000 millones en zonas rurales y 700.000 en zonas urbanas. Este déficit en la gestión de residuos representa alrededor de 540 millones de toneladas de RSU, equivalentes al 27% del total mundial, que no se recogen adecuadamente.
A pesar de su larga historia, el reciclaje de residuos sólidos urbanos (RSU) sigue siendo limitado en la actualidad, siendo reciclados solo un 19% de los residuos totales, entre los que se incluyen metales, vidrio, papel, cartón, algunos plásticos y residuos biodegradables tratados mediante compostaje y digestión anaeróbica. La reutilización y el reciclaje son fundamentales para reducir la demanda de materias primas, minimizar el impacto ambiental y evitar la contaminación. Sin embargo, la reutilización es preferible debido a su menor consumo energético en comparación con el reciclaje. El reciclaje, por tanto, no es el objetivo último de la gestión de residuos; siempre es mejor reducir los residuos, evitándolos en primer lugar.
Las tasas de reciclaje varían significativamente entre regiones: mientras que algunos países de renta alta superan registran tasas de reciclaje superiores al 50%, en otros de África
Subsahariana y Sudamérica apenas alcanzan el 5%. Europa septentrional y meridional presentan altas tasas de reciclaje (44% y 42%, respectivamente), aunque la cantidad total reciclada en Asia Oriental y Sudoriental es mayor debido a la exportación de materiales reciclables desde Europa.
La conversión térmica de residuos en energía, también conocida como incineración con recuperación de energía,
27% DEL TOTAL MUNDIAL NO SE RECOGEN ADECUADAMENTE
es una tecnología empleada en un número limitado de países. Aunque este método permite generar electricidad a partir de residuos altamente caloríficos, como plásticos y papel, enfrenta críticas por promover un uso lineal de los recursos y reducir los incentivos para reducir y reutilizar residuos. La quema de materiales reciclables también perjudica a los recolectores informales, que dependen de estos materiales para su subsistencia. A pesar de la expansión de esta tecnología en algunos países industrializados, su impacto ambiental es motivo de creciente escrutinio, especialmente en términos de emisiones de gases de efecto invernadero y otros contaminantes. La Unión Europea y el Reino Unido han decidido incluir la producción de energía a partir de residuos en sus regímenes de comercio de derechos de emisión, reflejando la creciente preocupación por las emisiones asociadas. En respuesta a estos desafíos, se investigan alternativas como la co-combustión de plásticos en hornos de cemento y la pirólisis de residuos plásticos, aunque estas tecnologías también presentan incertidumbres y riesgos ambientales.
Los vertederos sanitarios son unas instalaciones controladas para la eliminación segura de residuos sólidos, con características como selección adecuada del emplazamiento, uso de geomembranas para evitar la lixiviación
y sistemas para gestionar lixiviados y gases. Los vertederos sanitarios son fundamentales para manejar residuos que no pueden reciclarse ni valorizarse, incluyendo cenizas de instalaciones de conversión de residuos en energía. El biogás generado en estos vertederos, rico en metano, contribuye significativamente al calentamiento global; por lo tanto, muchos países priorizan el reciclaje y compostaje de residuos biodegradables para reducir estas emisiones. Sin embargo, a pesar de los esfuerzos en reducción y reciclaje, los vertederos seguirán siendo necesarios. Tecnologías como los vertederos semiaeróbicos pueden mejorar la sostenibilidad, con ejemplos de reducción de emisiones de metano de hasta un 40% en lugares como Mozambique.
El vertido y la quema al aire libre de residuos siguen siendo prácticas prevalentes en muchas partes del mundo, especialmente en el Sur Global, donde entre 400.000 y 1 millón de personas mueren anualmente debido a enfermedades relacionadas con la mala gestión de residuos. Estas prácticas causan graves problemas ambientales y de salud, como la contaminación del agua, inundaciones locales, y el incremento de enfermedades transmitidas por mosquitos. La quema de residuos libera contaminantes tóxicos y carbono negro, que contribuyen al calentamiento global y afectan la salud humana. Los vertederos incontrolados, que a menudo se ubican cerca de costas, filtran sustancias químicas peligrosas al medio ambiente, exacerbadas por el cambio climático. Además, estos vertederos pueden ser focos de incendios prolongados y deslizamientos de tierra, presentando riesgos significativos para las comunidades y complicaciones en su rehabilitación.
LA GESTIÓN DE RESIDUOS A ESCALA GLOBAL: PRESENTE Y FUTURO
En 2020, la gestión de residuos sólidos urbanos (RSU) a nivel mundial tuvo un coste directo de 252.300 millones de dólares. Estos costes son principalmente atribuibles a la recogida de residuos, que incluye salarios, combustible, mantenimiento de vehículos y otros gastos indirectos. Adicionalmente, el reciclaje y la eliminación de residuos, como los vertederos y la conversión de residuos en energía, implican inversiones significativas en infraestructura, así como altos costes operativos y de mantenimiento. Incluso el vertido de residuos al aire libre incurre en gastos directos, como la extinción de incendios y la pérdida de valor del suelo.


Gestión de residuos orgánicos agrícolas industriales
RECONOCER EL COSTE TOTAL DE LAS EXTERNALIDADES
PROPORCIONA A LOS GOBIERNOS Y A LOS RESPONSABLES DE LA TOMA DE DECISIONES UNA BASE SÓLIDA PARA PRIORIZAR LA REDUCCIÓN Y GESTIÓN DE RESIDUOS HACIA UN FUTURO
MÁS SOSTENIBLE
Más allá de estos costes directos, existen externalidades significativas asociadas con la mala gestión de residuos. Estas externalidades están vinculadas a la triple crisis planetaria del cambio climático, la pérdida de biodiversidad y la contaminación, además de afectar la salud humana y la justicia medioambiental. Los impactos nega-
tivos son especialmente severos para las comunidades vulnerables, como los trabajadores de residuos y los ciudadanos de países con menos recursos, debido a la falta de infraestructura adecuada y la incapacidad de aplicar normativas ambientales eficaces.
Los costes totales, incluyendo estas externalidades, ascienden, por tanto,


Biofiltros olores
troncos y tocones, turba, corteza pino, brezo, astilla de madera

Biocombustibles
Biomasa Restos de poda

Alquiler maquinaria
Trituradora
Giratoria
Trommel
a 361.000 millones de dólares, destacando los importantes “costes ocultos” de la gestión de residuos. Reducir los residuos y fomentar el reciclaje no solo disminuye la demanda de materias primas y los impactos ambientales, sino que también puede reducir significativamente estos costes y mejorar la salud pública. Esto prueba la importancia de reconocer el coste total de las externalidades, que proporcionará a los gobiernos y a los responsables de la toma de decisiones una base sólida
para priorizar la reducción y gestión de residuos hacia un futuro más sostenible. Asimismo, mejorar la gestión de residuos a nivel global requerirá inversiones sustanciales, siendo la reducción de residuos y la valorización de materiales secundarios la solución más económica a largo plazo.
Tras evaluar la situación actual de la gestión global de residuos, con es-
pecial atención al incremento en la generación de residuos y los desafíos asociados con la composición, las infraestructuras, los sistemas de gestión, y sus costes asociados, examinamos las posibles trayectorias futuras a nivel global. Se prevén tres posibles escenarios que ilustran cómo podría evolucionar la gestión de residuos en las próximas décadas: desde un enfoque continuista que perpetúa las prácticas vigentes, hasta una completa transición hacia un modelo de

economía circular. Los tres supuestos destacan las diversas implicaciones para el clima, la salud humana y los ecosistemas, así como las reformas necesarias para avanzar hacia un futuro más sostenible.
En primer lugar, bajo un enfoque continuista o sin cambios para la gestión de residuos, se prevé que la generación de residuos continúe aumentando a medida que crezca la economía global. En este modelo, las prácticas actuales de gestión de

residuos, que incluyen una infraestructura de recogida y reciclaje insuficiente, permanecerían sin cambios. Esto conduciría a una expansión continua de la eliminación incontrolada de residuos, especialmente en regiones con capacidades de gestión inadecuadas.
Esta perspectiva resultaría, por ende, en impactos negativos crecientes sobre el clima, la calidad de los ecosistemas y la salud humana. La falta de avances en la gestión de residuos contribuiría a mayores emisiones de gases de efecto invernadero, la contaminación de suelos, agua y aire, y un aumento en los riesgos para la salud. Por tanto, este escenario poco optimista ilustra una situación en la que los problemas asociados con la gestión de residuos se agravarían debido a la falta de reformas significativas.
Por otro lado, en un escenario en el que la gestión de residuos se mantuviera bajo control, se observarían avances significativos en la gestión de residuos, con un enfoque intermedio entre el status quo y una economía circular completa. En este modelo, la generación de residuos se estabilizaría gracias a políticas gubernamentales y medidas preventivas que desvinculan la generación de residuos del crecimiento económico. Las inversiones en prevención y gestión aumentarían, lo que llevaría a una mejora en la recogida y reciclaje de residuos, con la cobertura de recogida alcanzando el 100% para 2050 y el fin de la eliminación incontrolada.
Avanzar hasta este escenario mejorado exige una eficiencia mejorada en el uso de productos y materiales, así como una gestión más efectiva de los residuos. La capacidad global de reciclaje deberá duplicarse, especialmente en regiones como África subsahariana y Sudamérica, para al -
canzar estos objetivos. Sin embargo, aunque este escenario de control optimizado de los residuos reduciría los impactos negativos sobre el clima y, en menor medida, sobre la salud humana en comparación con 2020, los efectos sobre la salud de los ecosistemas solo se estabilizarían en los niveles de 2020.
Por último, el pronóstico más optimista prevé un futuro en el que se logre una transición completa y efectiva hacia un modelo de economía circular, desvinculando la generación de residuos del crecimiento económico mediante un modelo de consumo y producción sostenible. Bajo este enfoque, los productos y materiales se diseñarían para ser reutilizados, reciclados o recuperados, permaneciendo en la economía el mayor tiempo posible. Como resultado, la generación de residuos se reduciría a los niveles de 2020 para 2050, y la tasa mundial de reciclaje alcanza el 60%, con el resto de los residuos gestionados de forma segura.
Alcanzar este escenario exige una cobertura total de recogida de residuos, junto con una significativa mejora en la capacidad de reciclaje, que se triplicaría, pasando de 400 millones de toneladas en 2020 a más de 1.200 millones de toneladas en 2050. Para alcanzar estos objetivos, será necesario reducir drásticamente el consumo intensivo de recursos en regiones como Norteamérica, Australia, Nueva Zelanda y la mayor parte de Europa, así como implementar medidas de prevención en áreas con alto crecimiento económico y urbanización. Este último modelo tendría un impacto neto positivo sobre las emisiones de gases de efecto invernadero y la salud humana, y reduciría significativamente el impacto negativo sobre la calidad de los ecosistemas, aunque no lo eliminaría por completo para 2050.
TECNOLOGÍA I CAMEC
CAMEC es una empresa con más de treinta años de historia, especializada en soluciones tecnológicas avanzadas para el sector del reciclaje y la manipulación de materiales. A través de sus tres divisiones de éxito - reciclaje, manipulación e instalaciones de reciclaje- atienden a una prestigiosa cartera de clientes en todo el mundo.

La larga experiencia de CAMEC en el sector del tratamiento de residuos les ha permitido desarrollar soluciones a medida que pueden responder con mucha precisión a las necesidades de
sus clientes. Sus plantas, de hecho, nunca se estandarizan, sino que siempre se personalizan a partir de las solicitudes que nos llegan de nuestros interlocutores y las necesidades del territorio en el que operan.
CAMEC diseña cada una de sus plantas de forma personalizada, definiendo
junto con el cliente qué maquinaria instalar, cómo organizar los espacios de trabajo, cómo gestionar la movilidad dentro de la planta, etc., para permitir que cada planta funcione de una manera realmente eficiente.
Estos son algunos de los tipos de sistemas diseñados y construidos por CAMEC:

• Planta de separación y trituración de residuos sólidos urbanos, para clasificar los residuos y triturar el componente de residuos, que se envía para la producción de combustible sólido secundario.
• Planta de CDR/CSS, para el tratamiento de residuos domésticos e industriales, transformándolos en CDR (combustible residual) y CSS (combustible sólido secundario).
• Planta de tratamiento de plástico, en la que los residuos plásticos se separan aún más entre sí para maximizar el rendimiento y la calidad del plástico reciclado.
• Planta para el tratamiento de neumáticos al final de su vida útil (NFU), capaz de separar materiales como el acero y la fibra textil y moler neumáticos para obtener materia prima secundaria de tamaños de grano específicos.
• Planta para el tratamiento de RAEE. Las máquinas semiautomáticas especiales permiten la extracción de materiales valiosos (como oro, cobre y otros metales preciosos) presentes en los residuos de equipos eléctricos y electrónicos.
• Plantas de tratamiento y molienda de cables eléctricos, que permiten extraer y explotar el cobre presente en su interior.
• Planta para el tratamiento de depósitos y parachoques de automóviles, diseñada para obtener gránulos para ser utilizados como materia prima secundaria.
• Plantas de eliminación de tóner, en las que se separan y clasifican los en-
voltorios de plástico, evitando que el polvo de tóner se disperse en el medio ambiente.
• Plantas para el tratamiento de papel y cartón, equipadas con trituradoras especiales capaces de reducir el tamaño de estos materiales particularmente duros, para luego poder reciclarlos y reutilizarlos.
• Plantas de tratamiento de residuos de madera, capaces de tratar tanto madera virgen como madera reciclada, permitiendo recuperar un material que, además de ser 100% reciclable, es muy contaminante si se elimina de forma incorrecta, ya que su degradación en un medio sin oxígeno genera y emite gases que cambian el clima, como el dióxido de carbono y el metano.
Desde el diseño de las instalaciones hasta su puesta en funcionamiento, todas las fases se rigen por un proceso colaborativo y flexible que tiene en cuenta los requisitos específicos de nuestros clientes. CAMEC www.camec.net/es

EN PRIMERA PERSONA

A LA CIRCULAR
OLIVER-SOLÀ,
Hablar de sostenibilidad y economía es hablar, principalmente, de externalidades. Es hablar de cómo durante siglos, y aún hoy en la mayoría de los países y sectores productivos, contaminar no tiene coste. O más bien, existe un coste, pero no se repercute a la actividad económica que lo causa y, por tanto, no se tiene en cuenta al tomar decisiones ni al trasladar los costes ambientales a la señal de precio que se envía al resto de la cadena de valor para que cuadren las cuentas. El modelo lineal de producción y consumo —conocido popularmente
como de usar y tirar— se basa en la extracción de materias primas y su procesamiento en bienes de consumo que tarde o temprano acaban siendo considerados residuos. En contraposición al modelo lineal, se propone adoptar una economía circular que tenga como objetivo principal preservar durante el mayor tiempo posible el valor de los productos, los componentes y los materiales dentro de la economía, implicando una nueva forma de concebir las relaciones entre los mercados, los clientes y los recursos naturales. Un modelo de producción y consumo que desvincule el progreso del creciente consumo de recursos.
HABLAR DE SOSTENIBILIDAD Y ECONOMÍA ES HABLAR, PRINCIPALMENTE, DE EXTERNALIDADES. AÚN HOY EN LA MAYORÍA DE LOS PAÍSES Y SECTORES PRODUCTIVOS, CONTAMINAR TIENE UN COSTE QUE NO SE TIENE EN CUENTA AL TOMAR DECISIONES NI AL TRASLADAR LOS COSTES AMBIENTALES A LA SEÑAL DE PRECIO QUE
SE ENVÍA AL RESTO DE LA CADENA DE VALOR
Según el Circularity Gap Report de 2023, la economía mundial consumió más de 110 gigatoneladas (Gt = 109 t) de materiales en 2022, pero solo el 7,2% tuvo una segunda vida. Si comparamos este dato con el del informe de 2018 ―9,1% de circularidad― vemos que el porcentaje de circularidad no solamente es bajo, sino que sigue menguando.
Además, la baja circularidad de los recursos se acompaña de otro dato: el aumento acelerado de su consumo global. En tan solo 50 años, el uso global de materiales casi se ha cuadruplicado, mientras que en el mismo período el crecimiento de la población se ha duplicado. En 1972, el mundo consumió 28,6 Gt de recursos; en 2000, 54,9 Gt y, a partir de 2019, se superaron las 100 Gt.
El Circularity Gap Report de 2024 profundiza en este último análisis y revela que solo en el período 20182023, la economía mundial ha consumido el 28% de los materiales utilizados desde 1900.

EN PRIMERA PERSONA

Debido a la aceleración de los últimos años, cada vez se escuchan más voces que defienden la necesidad de decrecer, es decir, reducir el consumo de recursos para garantizar la sostenibilidad del planeta y asegurar el bienestar de las generaciones futuras. La idea del decrecimiento parte de la premisa de que la capacidad del planeta para proveer recursos y absorber residuos y emisiones es limitada, y que, por tanto, el crecimiento económico continuo ligado a un consumo creciente de recursos no es viable.
Probablemente, la economía circular sea una de las vías a transitar para retornar la economía dentro de los límites de la biosfera.
CÓMO AVANZAR HACIA UNA ECONOMÍA CIRCULAR
La economía circular implica (re)diseñar productos y procesos de producción
LOS INCENTIVOS EN EL LUGAR ADECUADO PARA FAVORECER LA CONSERVACIÓN DE LOS RECURSOS
de manera que permitan recuperar y reutilizar los componentes, reciclar los materiales y fomentar prácticas como la reparación, el intercambio de productos usados o su uso compartido.
La transición de las empresas hacia una economía circular requerirá cambios estructurales a diversos niveles, ya que afectará a las estrategias de producto o servicio, a los procesos productivos, a la estrategia de suministro, a la estrategia organizativa, al modelo de negocio, etc. Estos son enormes retos empresariales, pero
también sociales, tecnológicos y de gestión pública, que deberán situar los incentivos en el lugar adecuado para favorecer la conservación de los recursos. En este sentido, destacan dos grandes líneas de actuación: por un lado, los modelos de negocio circulares y, por otro, la fiscalidad.
MODELOS DE NEGOCIO CIRCULARES
Los modelos de negocio lineales se basan en la renovación del stock de re-
cursos presentes en la economía y, por tanto, existe un incentivo para la corta durabilidad, la falta de reparabilidad, etc., lo que se conoce como obsolescencia.
En contraposición, los modelos de negocio circulares buscan capturar el valor y maximizar el uso de los recursos presentes en la economía. Un ejemplo de esta familia de modelos de negocio es la servitización. La servitización es el proceso por el cual las empresas ponen en el centro de su negocio el valor que generan para el cliente en lugar del producto mediante el cual lo hacen posible. Pasan de centrarse en la venta de un producto o maquinaria tradicional a centrarse en ofrecer un servicio y experiencia al cliente, por ejemplo, a través del alquiler o el pago por uso.
El producto pasa de ser un elemento de coste a una oportunidad para ofrecer un mejor servicio al cliente y, por tanto, generar ingresos adicionales. La servitización supone un impulso para la economía circular a diversos niveles:
1. La durabilidad como beneficio empresarial: Cuando una empresa retiene la propiedad de los productos y se hace responsable de su mantenimiento y del pago de los costes operativos, la durabilidad y la reparación del producto, así como la reutilización de componentes y el reciclaje de materiales, se convierten en estrategias prioritarias para la empresa. Esto se debe a que cuanto más tiempo el producto permanezca instalado sin tener que ser sustituido, más beneficios genera a la empresa.
2. Desvincular el beneficio económico del consumo de más recursos naturales: Los modelos de negocio que favorecen el acceso a un producto compartido, como por ejemplo el carsharing, permiten que un mayor número de personas accedan al valor y/o a la función de un producto sin necesidad de consumir más recursos.
3. Mejores escenarios de fin de vida: Manteniendo la propiedad de los pro-
ductos, las empresas pueden prolongar su vida útil, reduciendo la necesidad de sustitución y fomentando las reparaciones. Las empresas priorizan productos duraderos y pueden obtener valor residual mediante la separación de componentes para la reventa, reutilización, remanufactura o reciclaje. Esto impulsa productos más circulares y exige repensar los modelos logísticos.
El uso de los impuestos y los gastos públicos es un instrumento para influir en el comportamiento de los agentes económicos (consumidores, empresas y sector público) y para lograr objetivos como la protección del medio ambiente, entre otros. En este sentido, la fiscalidad puede incentivar procesos y decisiones que faciliten la transición hacia una economía circular conservadora en el uso de los recursos. Por ejemplo:
1. Reducir los costes o aumentar los beneficios de algunas actividades que se consideran deseables para la economía circular: como la reparación, la reutilización o los modelos de negocio basados en la prestación de un servicio. Esto se puede hacer mediante incentivos directos (subvenciones o créditos) o indirectos (deducciones o bonificaciones fiscales).
2. Aumentar los costes o reducir los beneficios de algunas actividades que se consideran perjudiciales para la economía circular: como el uso de materias primas vírgenes, la generación de residuos sólidos o las emisiones de gases y aguas residuales. Esto se puede hacer
mediante impuestos específicos (p. ej., la tasa al plástico) que desincentiven estos comportamientos y favorezcan el aprovechamiento de los recursos presentes en la economía.
3. Corregir las fallas del mercado que provocan las externalidades ambientales: a través de impuestos pigouvianos, sobrecostes que se imponen a los generadores de externalidades negativas para que las tengan en consideración y, por tanto, se incentive su reducción.
En resumen, la fiscalidad juega un papel fundamental en promover un modelo económico viable a largo plazo, generando valor y reduciendo los impactos negativos del modelo de usar y tirar.
La transformación de los modelos de negocio y la fiscalidad tienen la capacidad de favorecer la circularidad y generar bienestar con un menor consumo de recursos asociado. La economía circular se erige como la vía para repensar los incentivos y potenciar la capacidad innovadora de los agentes económicos y sociales, al mismo tiempo que crea valor para la empresa y la sociedad.
• Circle Economy (2018) The Circularity Gap Report 2018 https://www.legacy.circularity-gap. world/2018
• Circle Economy (2023) The Circularity Gap Report 2023: We live in the overshoot era https://www.circularity-gap.world/2023
• Circle Economy (2024) The Circularity Gap Report 2024 https://www.circularity-gap. world/2024


CON AIZEA ASTOR HOSCHEN, SENIOR LEGAL AND POLICY OFFICER DE FEAD, ASOCIACIÓN EUROPEA DE GESTIÓN DE RESIDUOS
La creciente demanda de materiales y la escasez progresiva de recursos en Europa han convertido en prioridad el establecimiento de una legislación sólida sobre uso de materiales circulares, que garantice el suministro de materias primas recicladas de alta calidad.
Con unas proyecciones para Europa que anticipan un aumento significativo en la demanda de materiales para apoyar la transición verde y digital, un incremento en la generación anual de residuos y una creciente escasez de materias primas debido a las presiones en las cadenas de suministro mundiales, se hace evidente la necesidad urgente de reforzar la capacidad de Europa para suministrar materias primas de alta calidad provenientes del reciclado de sus propios residuos. En este contexto, la necesidad de una legislación sólida y efectiva sobre el uso circular de materiales se ha convertido en una cuestión prioritaria.
La Asociación Europea de Gestión de Residuos, FEAD, enfatizaba esta urgencia en un manifiesto publicado el pasado mes de mayo de 2024, que pone de relieve la necesidad de priorizar un Acuerdo Industrial Europeo que transforme la industria europea hacia un modelo más sostenible, competitivo y circular. Para ello, FEAD aboga por el establecimiento de una Ley de Uso Circular de Materiales (CMUA, por sus siglas en inglés) que integre políticas integrales y exhaustivas que abarquen la gestión de residuos y la transformación de materiales de desecho en recursos valiosos para la producción industrial.
En este reportaje, exploramos en profundidad la propuesta de FEAD para una Ley de Uso Circular de Materiales, subrayando su rol crucial en la transformación del mercado de mate-
rias primas recicladas. A través de las perspectivas de Aizea Astor Hoschen, responsable principal de Asuntos Jurídicos y Políticas de FEAD, examinamos cómo esta legislación puede abordar los desafíos actuales, allanando el camino hacia la economía circular en Europa; y evaluamos sus objetivos clave y propuestas, los beneficios esperados y los obstáculos a superar para lograr una implementación efectiva.
UNA LEY DE USO CIRCULAR DE MATERIALES?
La necesidad de una nueva legislación sobre el uso circular de materiales en la Unión Europea se manifiesta claramente a través de la persistente y preocupante estaticidad en la tasa de uso circular de materiales, esto es, los recursos materiales utilizados en la UE que proceden de materiales reciclados, explica Astor Hoschen. Según datos recientes de Eurostat, esta tasa alcanzó apenas el 11,5% en 2022, con un incremento marginal del 0,1% entre 2021 y 2022 y un crecimiento acumulado de solo 0,8% desde 2010, “datos muy bajos para una sociedad con ambiciones de transición hacia una economía circular”, lamenta. Este estancamiento contrasta profundamente con los objetivos ambiciosos planteados en el Pacto Verde Europeo de 2019 y en el Nuevo Plan de Acción para la Economía Circular de 2020, que buscaban una transición hacia un modelo de crecimiento regenerativo, y con tal fin, esforzarse por reducir su huella de consumo y duplicar su tasa de utilización de material circular en la próxima década. La experta de FEAD enfatiza la gravedad de la situación, al señalar que la pobre evolución de la tasa de uso circular de materiales es indicativa de una desconexión entre las metas políticas y los resultados prácticos. Este estancamiento subraya


una deficiencia en la aplicación efectiva de las políticas existentes y revela la falta de un marco legal que impulse cambios sustanciales en el uso de materiales reciclados.
Si bien es cierto que las políticas de la UE han fomentado la evolución de la gestión de residuos hasta convertirla en una industria altamente especializada que, además de descontaminar el medio ambiente y destruir sustancias peligrosas, es capaz de suministrar materias primas secundarias y energía a su economía; la realidad es que, “a pesar de sus buenas intenciones, estas políticas continúan siendo insuficientes”, opina Astor Hoschen, considerando que “tenemos un problema generalizado de aplicación de la normativa y de demanda de materiales reciclados”.
La experta advierte que, sin una aplicación adecuada de la ley, se corre el riesgo de que los ambiciosos objetivos “queden en nada”. Un claro ejemplo de esta deficiencia es la recogida selectiva de residuos orgánicos, obligatoria desde el 1 de enero de 2024, pero cuya aplicación es inconsistente y no se ha ejecutado uniformemente ni siquiera en Alemania, país pionero en implementar esta medida en 2014. Otro ejemplo son los altos índices de vertido de residuos municipales en determinados países, a pesar del objetivo de alcanzar un máximo de 10% para 2035.
En contraste, existen otros ejemplos de prácticas exitosas a nivel europeo, que podrían servir de referencia para esta nueva ley. Italia, por ejemplo, ha establecido un objetivo nacional de recogida selectiva de residuos, complementado por metas específicas para distintos tipos de materiales; República Checa ha propuesto reducir el IVA sobre los productos que contienen materiales reciclados, con el fin de estimular la demanda de estos productos; o Bélgica, donde el SCRAP Valipac es

LA LEY DE USO CIRCULAR DE MATERIALES PERMITIRÍA UN SUMINISTRO MÁS EFICIENTE DE MATERIAS PRIMAS SECUNDARIAS Y ENERGÍA A LA ECONOMÍA EUROPEA, AL TIEMPO QUE SE GESTIONAN LOS RESIDUOS DE MANERA SEGURA Y RESPONSABLE CON EL MEDIO AMBIENTE
pionero en la gestión de envases industriales con un enfoque financiero y de libre mercado, evidenciando un modelo innovador en la gestión de residuos.
Considerando los datos actuales y ante la urgencia y necesidad de establecer objetivos claros que impulsen una transición efectiva hacia la economía circular en toda Europa, FEAD aboga por recoger estas ambiciones en un instrumento “legalmente vinculante”. En este sentido, propone la
implementación de una Ley de Uso Circular de Materiales, la cual, según Aizea, debería articular una visión a largo plazo para el uso de recursos circulares, empezando por dos objetivos fundamentales: alcanzar una tasa de uso circular de materiales del 25% para el año 2030 y lograr un objetivo de reciclaje del 75% para todos los residuos en la UE para 2035. Estos objetivos están diseñados para abordar las deficiencias observadas en el sistema actual y para alinear las prácticas europeas con las ambiciones declaradas en el Pacto Verde Europeo y el Nuevo Plan de Acción para la Economía Circular.
Apenas unos meses de la celebración de las elecciones europeas de junio, Aizea describe una actualidad en la que se está gestando un nuevo Pacto Industrial y de Competitividad para el nuevo período legislativo. Ursula von der Leyen, reelegida como presidenta de la Comisión Europea el 17 de julio, ha anunciado, para los primeros cien días de su segundo mandato, un Pac-
to Industrial Limpio, cuyo objetivo es potenciar una industria competitiva, descarbonizar y reducir los precios de la energía.
En este escenario, el primer gran desafío será adaptar la producción industrial a la economía circular. Según Aizea, la Ley de Uso Circular de Materiales deberá aumentar la demanda industrial de materias primas recicladas, estableciendo incentivos para que los fabricantes sustituyan los materiales vírgenes por materiales reciclados. Sugiere además la creación de un Fondo de Inversión en Economía Circular que respalde el abandono de las materias primas primarias, añade. Astor Hoschen enfatiza que la introducción de incentivos económicos para incorporar materiales reciclados en la fabricación de productos es esencial para asegurar la sostenibilidad, competitividad y autonomía de la industria y la economía europeas; y son los países de la UE los que “tienen en su mano” el impulsar la demanda de materiales sostenibles. Esto puede alcanzarse mediante la implementación de requisitos adicionales de contenido mínimo reciclado obligatorio, así como con la adopción
de políticas como la contratación pública sostenible o la reducción del IVA en productos que contengan material reciclado, ejemplifica.
Otro asunto pendiente sobre el que habrá que decidir próximamente es el establecimiento de un objetivo intermedio de reducción de emisiones de gases de efecto invernadero para 2040, antes de alcanzar la neutralidad climática en 2050. Es fundamental que la revisión que se haga de la legislación europea reconozca la importancia crucial de la economía circular en la mitigación del cambio climático. Aprovechar la gestión de residuos y la economía circular es clave para reducir emisiones, promover el uso de recursos alternativos y desarrollar materias
primas que sustituyan los combustibles fósiles, afirma Aizea. Por tanto, la Ley de Uso Circular de Materiales debería considerar un mecanismo que reconozca las emisiones de CO² evitadas por la industria de la gestión de residuos, a fin de impulsar la competitividad de los materiales reciclados frente a los vírgenes.
Por otro lado, para reforzar la autonomía de la UE sobre su suministro de recursos, hay que hacer todo lo posible para que las materias primas recicladas que se reintroduzcan en la producción industrial europea se obtengan y reciclen dentro de la propia UE, agrega. Como mínimo, la Ley de Uso Circular de Materiales debería exigir que todos los productos importados que se co-
mercialicen en la UE estén sujetos a las mismas normas y requisitos que los productos fabricados en la UE, incluyendo garantías de calidad y sostenibilidad de su contenido reciclado.
Reforzar la aplicación uniforme de la legislación ambiental va a ser otra prioridad en la legislatura entrante. Esto va a ser un reto considerable en los próximos años, que requerirá recursos financieros y humanos a escala europea, nacional y local, anticipa la experta. Desde FEAD, piden que que la Ley de Uso Circular de Materiales cree una agencia encargada de supervisar la aplicación de los marcos jurídicos de la economía circular, con la posibilidad de sancionar las infracciones. En lugar de crear una nueva
4


agencia, tal función podría atribuirse a la Agencia Europea de Medio Ambiente, que ya apoya a la CE en determinadas funciones, propone.
Por último, contar con un mercado de residuos justo y transparente será clave para fomentar la inversión del sector privado. La última propuesta de FEAD en relación a la nueva Ley
es la introducción de medidas que garanticen un mercado competitivo, excluyendo cualquier tipo de trato preferente de las entidades públicas sobre las empresas privadas. Asimismo, esta deberá garantizar que se mantengan los principios del mercado único, sobre todo en relación a las normas sobre ayudas estatales a las

Una Ley de Uso Circular de Materiales debería articular una visión a largo plazo con dos objetivos fundamentales: alcanzar una tasa de uso circular de materiales del 25% para el año 2030 y lograr un objetivo de reciclaje del 75% para todos los residuos en la UE para 2035.
Aizea Astor Hoschen Senior Legal and Policy Officer de FEAD, Asociación Europea de Gestión de Residuos.
empresas públicas, evitando la legislación que establece la propiedad o el acceso restringido a determinados flujos de residuos.
La nueva Ley de Uso Circular de Materiales, propuesta por FEAD, representa, por tanto, un avance significativo y tiene potencial para transformar la gestión de residuos en la Unión Europea. Según Aizea, la ley pretende establecer un mercado único que sea competitivo, justo y transparente, y del que se esperan múltiples beneficios. Este marco legislativo, diseñado para acelerar la transición hacia una economía circular, permitirá un suministro más eficiente de materias primas secundarias y energía a la economía europea, al tiempo que se gestionan los residuos de manera segura y responsable con el medio ambiente. En este proceso, la industria de la gestión de residuos juega un papel crucial. A través de una gestión adecuada de los residuos, se espera, por tanto, lograr importantes beneficios medioambientales y económicos, entre los que Astor Hoschen destaca el ahorro de energía, la reducción de emisiones de CO² y la estabilización en el suministro de materias primas, lo cual no solo proporciona un impulso sostenible a la industria, sino que también generará empleo. Asimismo, la implementación de la ley brinda una oportunidad para que la UE consolide su liderazgo en sostenibilidad. Descontaminar la economía y suministrarla de materiales reciclados de calidad, que puedan que competir con materias primas vírgenes, fortalecerá la sostenibilidad en las cadenas de valor europeas y contribuirá a reforzar la independencia estratégica de la UE, fundamental en un contexto global marcado por grandes retos

CADENAS DE VALOR EUROPEAS Y CONTRIBUIRÁ A REFORZAR LA INDEPENDENCIA ESTRATÉGICA DE LA UE
medioambientales y climáticos, como la contaminación ambiental, la escasez o la sobreexplotación de los recursos, agrega.
Sin embargo, la implementación efectiva de esta ley también enfrenta desafíos significativos, como las disparidades actuales entre los países miem-
bros de la Unión Europa, que afectan al desarrollo de la infraestructura existente, los sistemas legislativos y los medios materiales y humanos a disposición de las administraciones públicas, explica la experta. Alcanzar los objetivos propuestos requerirá el despliegue de todas las tecnologías de tratamiento de residuos disponibles, asegurando que estas cuenten con las capacidades adecuadas. Por ende, tanto para el traslado de residuos como para el desarrollo de infraestructuras, será necesario acelerar los procedimientos de

concesión de permisos, reducir la burocracia y digitalizar los procesos, señala Astor Hoschen. La modernización y agilización de estos procedimientos es esencial para superar los obstáculos administrativos que podrían ralentizar la transición hacia una economía circular efectiva. Además, las administraciones públicas deberán contar con “personal suficiente y suficientemente especializado” para garantizar que las políticas se implementen de manera eficiente y eficaz, evitando retrasos y problemas en la ejecución.

Para alcanzar los objetivos planteados y enfrentar eficazmente los mencionados retos, los Estados miembros deben considerar cuatro ejes fundamentales, aplicables a cualquier modelo socioeconómico, que asegurarán la exitosa implementación de la economía circular en Europa.
El primer eje para lograr una transición circular efectiva es la colaboración estrecha entre los diversos actores clave del sector. Aizea señala que impulsar la incorporación de materias primas provenientes del reciclaje a la economía va a requerir asociaciones en la cadena de valor que conecten el sector de la gestión de residuos con la producción industrial. Este tipo de asociaciones deberán basarse en principios claros de cooperación y responsabilidad compartida. Para ello, es imperativo que las autoridades públicas, los productores de residuos y los recolectores cooperen sobre una base de obligaciones y responsabilidades definidas, estableciendo sistemas de recogida selectiva eficaces y a gran escala.
PRIMAS PROVENIENTES DEL RECICLAJE
VA
ASOCIACIONES EN LA CADENA DE VALOR QUE CONECTEN EL SECTOR DE LA GESTIÓN DE RESIDUOS CON LA PRODUCCIÓN INDUSTRIAL
Por otro lado, enfatiza que la acción concertada entre el sector de la gestión de residuos, la producción industrial y el diseño de productos o servicios debe extenderse hacia varios aspectos clave. Estos incluyen el desarrollo de especificaciones sobre requisitos de calidad industrial para la incorporación de materias primas recicladas en la producción industrial; la determinación de medidas basadas en la demanda, como objetivos de contenido reciclado en determinados flujos de materiales o categorías de productos; y la mejora del diseño ecológico de los productos para facilitar el reciclado y limitar la presencia de sustancias peligrosas en los materiales de desecho. Además, es esencial desarrollar programas conjuntos de investigación y desarrollo (I+D) para optimizar el uso de materias primas recicladas y explorar nuevas salidas para el reciclado de materiales de desecho.
También el apoyo gubernamental se erige como un pilar esencial en la transición hacia una economía circular robusta y sostenible, que deberá concretarse en la formulación e implementación de políticas que favorezcan el uso de materiales reciclados y promuevan un mercado más competitivo y justo para estos materiales. En la actualidad, las materias primas provenientes del reciclaje presentan un costo superior al de las vírgenes, lo que limita el crecimiento del mercado circular. Astor Hoschen sostiene que cuando los materiales reciclados no son competitivos, la economía circular no puede desarrollarse ni crecer. Para superar este obstáculo, es imperativo que los gobiernos impulsen políticas que internalicen las externalidades negativas asociadas con el uso de materias primas vírgenes, tales como la

CUANDO LOS MATERIALES RECICLADOS NO SON COMPETITIVOS, LA ECONOMÍA
CIRCULAR NO PUEDE
DESARROLLARSE NI CRECER
extracción de recursos naturales y la emisión de gases de efecto invernadero, que no están adecuadamente reflejadas en su precio, ejemplifica.
3. Financiación
Asimismo, el desarrollo de nuevas tecnologías para el reciclaje o la mejora de las infraestructuras necesarias para gestionar los residuos de manera efectiva, harán necesario garantizar a la industria el acceso a diversas fuentes de financiación, asevera la experta, que menciona algunos ejemplos como los fondos europeos específicos disponibles a través de los planes nacionales de recuperación y resiliencia, u otros instrumentos de financiación existentes como el Fondo de Inno -
vación, Horizonte Europa, Life y los programas del Banco Europeo de Inversiones. Además, considerando la importancia estratégica de desarrollar nuevas tecnologías para el reciclaje de materias primas críticas y estratégicas, Aizea sugiere la creación de un fondo específico dedicado a la financiación de proyectos innovadores en este ámbito. Este tipo de apoyo financiero permitirá avanzar en la investigación y desarrollo de soluciones tecnológicas avanzadas que faciliten la incorporación de materiales reciclados en la cadena de suministro.
4. Sensibilización
El último eje fundamental para el éxito es la comunicación. Aizea subraya que la transición circular deberá ir de la mano de la aceptación pública e industrial de la gestión de residuos como parte intrínseca de una sociedad que funciona y como pilar clave de un suministro de materias primas más independiente para la economía de la UE. Para ello será necesario mejorar la comunicación sobre el valor de los residuos y la importancia de apoyar
las infraestructuras de gestión como valor local, económico y medioambiental, opina. Esta sensibilización deberá incluir campañas educativas que fomenten una buena gestión de los residuos por parte de la ciudadanía y resalten el valor de los residuos como recursos. También es esencial garantizar que los ciudadanos confíen en que los materiales segregados para reciclar se procesan de manera efecti -
LA TRANSICIÓN CIRCULAR DEBERÁ IR DE LA MANO DE LA ACEPTACIÓN PÚBLICA E INDUSTRIAL DE LA GESTIÓN DE RESIDUOS COMO PARTE INTRÍNSECA DE UNA SOCIEDAD QUE FUNCIONA Y PILAR CLAVE DE UN SUMINISTRO DE MATERIAS PRIMAS MÁS INDEPENDIENTE PARA LA ECONOMÍA DE LA UE
va, aportando beneficios ambientales y creando empleo local. Del mismo modo, las industrias deben reconocer al sector de la gestión de residuos como un proveedor fiable de materias primas recicladas, y los responsables políticos deben valorar la recogida de residuos como una actividad económica valiosa y altamente profesional, que contribuye a la preservación de recursos y al mantenimiento de un entorno limpio y saludable.
Por tanto, la clave para avanzar con éxito hacia una economía circular en Europa, radica en buena parte en el establecimiento e implementación


efectiva de una Ley de Uso Circular de Materiales, que permita garantizar materiales reciclados competitivos, a la altura de los estándares de calidad y precio de materiales vírgenes. Según relata Aizea, desde la publicación del manifiesto de FEAD en mayo de 2024, la organización ha trabajado arduamente para conseguir una amplia diseminación de sus propuestas, así como para generar el apoyo social y político necesario para impulsar la inclusión de los objetivos de economía circular en las próximas prioridades de la Comisión Europea. Con vistas a futuro, estos esfuerzos incluyen el fortalecimiento del diálogo con las instituciones europeas, como el nuevo Comisario de Medio Ambiente y los
eurodiputados recién electos, además de la planificación de eventos públicos destinados a promover y discutir la nueva legislación y los desafíos del sector de gestión de residuos. Por el momento, ya es un enorme éxito que Ursula von Der Leyen haya incluido en sus directrices para la próxima Comisión Europa (2024-2029) el propósito de establecer una nueva Ley de Economía Circular que ayude a crear una demanda de mercado para materiales reciclados y un mercado único para los residuos, especialmente en relación con las materias primas críticas. Estos avances nos alientan a avistar un futuro optimista para Europa, en el que la circularidad sea la norma y no la excepción, concluye la experta de FEAD.

desarrollamos





















TECNOLOGÍA I EGGERSMANN

En un mundo donde la sostenibilidad y la gestión adecuada de residuos son cada vez más cruciales, el triturador móvil Forus F38 de Eggersmann se posiciona como una solución versátil y eficaz para el reciclaje de una amplia gama de materiales. Este triturador destaca por su capacidad de manejar desde residuos RAEE de energías renovables hasta residuos industriales y de construcción, demostrando su adaptabilidad y eficiencia en diversos escenarios de reciclaje.
El Forus F38 está especialmente diseñado para enfrentar el desafío de
triturar grandes y robustos equipos de energías renovables. Entre sus aplicaciones más destacadas se encuentra la trituración de palas de molinos de viento y placas solares.
La industria de la energía eólica se enfrenta a un reto en la gestión de la eliminación de palas de rotor de viento fuera de servicio, en particular en la recuperación de materiales valiosos como el cobre y el aluminio.
Los materiales compuestos reforzados con fibra deben separarse en plásticos reforzados con fibra de vidrio y de carbono. Mientras que los plásticos reforzados con fibra de vidrio se pueden utilizar para la recuperación de energía, los segmentos reforzados con fibra de carbono requieren un reciclaje especializado.
Estos componentes, que al final de su vida útil pueden ser difíciles de manejar debido a su tamaño y resistencia, son procesados de manera eficiente por el Forus F38, reduciendo su volumen significativamente, separando los diferentes materiales de fabricación y facilitando su posterior valorización y reciclaje.
La versatilidad del Forus F38 no se limita a los residuos de energías renovables. Este equipo es igualmente competente en la trituración de otros tipos de residuos, tales como:
• Residuos de la Construcción: Con su capacidad para triturar materiales
como hormigón, ladrillos y otros escombros de construcción, el Forus F38 ayuda a minimizar el impacto ambiental de los proyectos de construcción y demolición.
• Vidrio: La trituración de vidrio, que puede ser un proceso complicado y peligroso, se realiza de manera segura y eficiente, permitiendo su reciclaje en nuevos productos de vidrio.
• Biomasa y Madera: Este triturador puede procesar biomasa y residuos de madera, facilitando su conversión en biomasa utilizable para energía.
• Residuos de Aparatos Eléctricos y Electrónicos (RAEE): El Forus F38 es capaz de triturar una variedad de RAEE, desde pequeños electrodomésticos hasta equipos electrónicos más grandes. Esta capacidad es crucial para el reciclaje de componentes valiosos y la reducción de residuos peligrosos.
• Residuos Sólidos Urbanos (RSU): Los residuos domésticos y comerciales se trituran eficazmente, reduciendo su volumen y permitiendo una gestión más eficiente.
• Neumáticos: La capacidad de triturar neumáticos usados permite su reciclaje en productos de caucho reutilizable.
• Balas de Cartón: El Forus F38 maneja grandes cantidades de cartón, reduciéndolo a tamaños manejables para su reciclaje posterior.
El reciclaje de materiales diversos presenta múltiples desafíos, desde la variabilidad en el tamaño y la dureza de los residuos hasta la necesidad de cumplir con estándares específicos de granulometría para su reutilización. El Forus F38 está diseñado para responder a estos retos de manera eficaz. Su capacidad para triturar los residuos no solo facilita su manejo y transporte, sino que también incrementa las posibilidades de valoriza -
ción de los mismos, contribuyendo a un ciclo de vida más sostenible para los materiales.
Una de las características más destacadas del Forus F38 es la posibilidad de instalar diferentes parrillas de salida. Estas parrillas permiten garantizar la granulometría deseada del material triturado, adaptándose a los requisitos específicos de cada tipo de residuo y facilitando su reutilización y reciclaje eficiente.
El triturador Forus F38 además se completa con las siguientes características.
• Mantenimiento sencillo: Fácil acceso al motor y a todos sus componentes para el mantenimiento del equipo.
• Overband de salida: Un separador magnético ajustable en altura hidráulicamente para la eliminación de materiales férricos del flujo de salida.
• Control versátil: Programas individuales y fáciles de modificar que per-
miten ajustar el equipo para diferentes tipos de materiales.
• Ejes individualmente ajustables: Los ejes puede girar en sentido y velocidades independientes uno del otro. Esto tiene un efecto de limpieza de los ejes individualmente y además es ideal para reducir el riesgo de enrollamiento de materiales.
• Parrillas intercambiables fácilmente: .Las barras rompedoras son fácilmente intercambiables sin herramientas, gracias al sistema de montaje y bloqueo hidráulico se pueden cambiar en menos de 10 minutos.
En conclusión, el equipo móvil Forus F38 de Eggersmann es una herramienta indispensable en el campo del reciclaje, gracias a su capacidad para manejar una amplia variedad de residuos y su flexibilidad para adaptarse a diferentes necesidades de granulometría. Su diseño robusto y eficiente lo convierte en una solución ideal para enfrentar los desafíos del reciclaje moderno, promoviendo la sostenibilidad y la valorización de los materiales reciclados.





Los residuos de nueva generación, que abarcan desde vapeadores y cosméticos hasta drones y vehículos al final de su vida útil (VFU), están transformando el panorama del reciclaje. Cada semana, millones de estos productos se desechan, planteando desafíos monumentales en términos de volumen e impacto ambiental.
La clasificación de estos residuos es compleja debido a la diversidad de materiales involucrados: plásticos, metales, componentes electrónicos e incluso baterías de litio. Esta realidad demanda un nuevo enfoque en el tra-
tamiento de residuos, y con ello, surgen desafíos sin precedentes.
En el sector automotriz, los VFU representan una categoría crítica de residuos. El auge de vehículos eléctricos y autónomos está dejando obsoletos a millones de modelos, aumentando la necesidad de procesos de reciclaje más avanzados. Tecnologías como las de PICVISA permiten la recuperación de materiales valiosos, alineando a la industria con los principios de la economía circular.
Además, el crecimiento de los dispositivos portátiles y los drones ha acelerado la generación de residuos electrónicos, que requieren soluciones de
reciclaje más eficientes. Las innovaciones como el estándar SD 9.0, que apoya el movimiento “Derecho a Reparar”, son un paso adelante en la lucha contra estos residuos.
En PICVISA están comprometidos con liderar esta transformación mediante el desarrollo de tecnologías avanzadas de clasificación y separación. Su objetivo es enfrentar los desafíos del reciclaje de residuos de nueva generación y contribuir a un futuro más sostenible.
PICVISA www.picvisa.com

JASO Industrial Cranes es referente en fabricación de equipos de elevación para el sector de RSU con amplia presencia nacional e internacional. Somos calidad, innovación, versatilidad y servicio.
Grúas con programación automatizadas y semiautomatizadas • Soluciones a medida • Polipastos de cable • Grúas monorraíles y birraíles
EN PRIMERA PERSONA
La economía circular es más que una estrategia ambiental; es una visión audaz para el futuro. Al incorporar el concepto de infinito, este modelo busca crear un sistema en el que cada acción contribuye a un ciclo continuo de bienestar económico, social y ambiental.

ECRISTINA SÁNCHEZ
DIRECTORA EJECUTIVA DEL PACTO MUNDIAL DE LA ONU ESPAÑA
n nuestro imaginario el concepto de infinito evoca imágenes de un horizonte sin fin, una extensión sin límites que va más allá de nuestra percepción. En el ámbito de la economía, el infinito puede parecer una idea abstracta, casi filosófica, pero resulta ser también una metáfora para explicar un modelo económico emergente: la economía circular.
Para entenderlo, podemos empezar hablando de la economía lineal, aquella que predomina en el sistema pro-
ductivo global y que consiste en extraer, producir, consumir y desechar. Un proceso que tiene un alto impacto medioambiental debido al agotamiento de recursos naturales, la generación de residuos y la contaminación que conlleva. Éste, aunque ha impulsado el crecimiento económico durante décadas, enfrenta desafíos cada vez más urgentes en términos de sostenibilidad y resiliencia.
En contraposición a este enfoque, la economía circular nos propone una alternativa donde el concepto de infini-
to se convierte en el eje de un sistema más sostenible y regenerativo, inspirado en los procesos que se dan en la naturaleza. En los ecosistemas naturales, los desechos de un organismo se convierten en recursos para otros, en un flujo constante de energía y materia. Este equilibrio natural inspira la economía circular, donde buscamos imitar estos procesos para construir una economía sostenible.
De este modo, en lugar de seguir una línea recta, como en la economía lineal, este modelo se basa en la

idea de un ciclo continuo donde los recursos fluyen constantemente. Este ciclo se fundamenta en principios de reducción, reutilización, reparación y reciclaje, en un esfuerzo por mantener los materiales en uso durante el mayor tiempo posible.
Así, en la economía circular, el infinito no se refiere a la ausencia de fin en un sentido literal, sino a la capacidad de los recursos para ser renovados y reutilizados indefinidamente. El objetivo es crear un sistema en el que los productos y materiales continúen su vida útil de manera constante, minimizando los residuos y maximizando el valor a lo largo del tiempo.
Esto no sólo consigue reducir el impacto ambiental - la economía circular tiene la capacidad de reducir las emisiones globales de gases de efecto invernadero un 39% y el uso de materias primas en un 28% – sino que también impacta directamente en el progreso de la economía. De hecho, la transición a la circularidad podría desbloquear un crecimiento del PIB mundial de hasta 4,5 billones de dólares hasta 2030. Además, poniendo el foco en los beneficios empresariales, según las estimaciones del I Plan de Acción de la Economía
Circular de la Comisión Europea, la aplicación de las medidas incluidas supondría un ahorro de 600.000 millones de euros para las empresas europeas, equivalente a un 8% de su cifra de negocio.

Pero ¿está calando realmente este modelo dentro de las empresas españolas? De acuerdo con nuestro informe “Implantación de la Agenda 2030 en las empresas españolas. Resultados de la consulta de desarrollo sostenible 2024”, el 54% de las empresas españolas ya afirma trabajar en el ODS 12 relativo a producción y consumo sostenible, siendo una de las cinco áreas más relevantes para el tejido empresarial del país. Más concretamente, de este estudio se desprende que el 60% de las empresas desarrolla procesos de economía circular y casi el 50% evalúa a sus proveedores según criterios medioambientales. Además, el 46% de las empresas consultadas –2.310 en total– opina que la economía circular es uno de los ámbitos en los que debería haber una mayor regulación.
Como vemos, este modelo es cada vez más popular entre las empresas de nuestro país, pero aún no es predominante. Esto es lógico, pues no se puede cambiar la economía de un día para otro y su implementación requiere ajustes significativos en las cadenas de producción y en las estrategias empresariales. Esta transformación, además, implica un cambio de mentalidad, donde las empresas no solo se centren en maximizar las ganancias a corto plazo, sino que también consideren el impacto a largo plazo de sus actividades.
Hablamos de reducir su impacto ambiental, pero también de los costes de producción, la creación de nuevas oportunidades de mercado y la mejo -
LA COLABORACIÓN ENTRE EMPRESAS DE DIFERENTES
CAPACIDADES Y ÁREAS DE ESPECIALIZACIÓN PUEDE ACELERAR LA INNOVACIÓN Y FACILITAR LA ADOPCIÓN DE PRÁCTICAS CIRCULARES EN TODA LA CADENA DE VALOR
ra de su reputación. Por ejemplo, la implementación de procesos de reciclaje y reutilización puede disminuir la dependencia de materias primas vírgenes, lo que a su vez reduce el gasto. Además, las empresas que evalúan a sus proveedores según criterios medioambientales aseguran una cadena de suministro más sostenible y resiliente.
Por supuesto, la innovación es esencial en este proceso. Empresas de diferentes sectores ya están explorando nuevas formas de diseñar productos que sean más fáciles de desmontar y reciclar, desarrollando materiales biodegradables y creando modelos de negocio basados en servicios en lugar de productos.
Pero para que esta innovación sea posible, en ocasiones tenemos que echar mano de una de las palancas más importantes del desarrollo sostenible: las alianzas. En este sentido, me gustaría alentar a todas las empresas a colaborar, en especial entre grandes y pymes, para lograr una transición más rápida hacia la economía circular. La colaboración entre empresas de diferentes capacidades y áreas de especialización puede acelerar la innovación y facilitar la adop -
ción de prácticas circulares en toda la cadena de valor.
Las grandes empresas, con sus recursos y capacidades de investigación y desarrollo, pueden liderar el camino al establecer estándares y ejemplos a seguir. Al mismo tiempo, las pymes pueden aportar flexibilidad, agilidad y creatividad en la implementación de soluciones circulares adaptadas a diferentes sectores y mercados locales. Esta colaboración no solo fortalecerá la resiliencia de las empresas frente a los desafíos económicos y ambientales, sino que también abrirá nuevas oportunidades de crecimiento y diferenciación en un mercado cada vez más consciente de la sostenibilidad.
En definitiva, la economía circular es más que una estrategia ambiental; es una visión audaz para el futuro. Al incorporar el concepto de infinito, este modelo busca crear un sistema en el que cada acción contribuye a un ciclo continuo de bienestar económico, social y ambiental. Es, sin duda, la respuesta a algunos de los mayores desafíos del desarrollo sostenible. Y teniendo la solución en nuestra mano ¿a qué esperamos para ponerla en marcha?

e VAERSA REPORTAJE


La entidad Valenciana d’Estratègies i Recursos per a la Sostenibilitat Ambiental, S.A. (en adelante VAERSA) ha sido pionera en la gestión de los residuos procedentes de la recogida selectiva de envases en la Comunidad Valenciana. Actualmente, VAERSA gestiona la mayoría de los envases de la Comunidad Valenciana, llevando dicho servicio mediante cuatro plantas de clasificación de envases ligeros, ubicadas en Castellón, Picassent, Alzira y Benidorm.
A principios del año 2000 se puso en marcha la primera planta de clasificación de envases de la Comunidad Valenciana en la localidad de Alzira. La separación y clasificación se efectuaba de forma manual y cumplía con las necesidades del momento. A lo largo de los años, las entradas han ido incrementándose, y se fue regulando con el incremento de turnos y horas de producción en la Planta de Alzira y con la puesta en escena de otros centros de clasificación donde ya se contempló la necesidad de automatizar el proceso para favorecer la clasificación del material.

En el caso de Alzira estábamos hablando de una planta cuya capacidad nominal era de tres toneladas por hora. Se hicieron mejoras a lo largo de los años para intentar mejorar todo el proceso, pero ante el creciente incremento de este tipo de residuos y ante la previsión de crecimiento para los años próximos, se tuvo que plantear la remodelación completa en la Planta de Alzira que, por su antigüedad y capacidad, permitía el mayor incremento de capacidad y absorción de dichos incrementos de flujo.
Teniendo clara la estrategia para poder atender las necesidades futuras de tratamiento de residuos de envases procedentes del contenedor amarillo, se estimó ampliar la capacidad a ocho toneladas frente a las tres toneladas que teníamos en un origen.
El proyecto fue ambicioso y complicado desde un principio, al tener que respetar las infraestructuras actuales que, por espacio disponible, eran un obstáculo significativo. Se tuvieron una serie de premisas bien definidas desde el principio, y los criterios de diseño iban encaminados a llegar a la capacidad de tratamiento estimada en las mejores condiciones de prestación del servicio. Se pretendía dotar a la planta de elementos y equipos necesarios para la selección automática de los materiales recuperables y, del mismo modo, que dichos equipos de selección automática tuvieran una
REPORTAJE

APARTE DE LAS MEJORAS A NIVEL DE EFECTIVIDAD, RECUPERACIÓN Y CAPACIDAD DE TRATAMIENTO, SE HA DADO UN GRAN SALTO DESDE EL PUNTO DE VISTA ERGONÓMICO PARA LOS TRABAJADORES EN LOS PUESTOS DE TRIAJE Y CONTROL DE CALIDAD
capacidad suficiente para tratar, en un futuro, un flujo de residuos con un mayor porcentaje de envases recuperables. Exigíamos también obtener una máxima flexibilidad y modularidad en el diseño de la instalación para permitir adaptaciones a la evolución de la cantidad (aumento del régimen de alimentación) y calidad de los materiales de entrada, también según épocas del año puntuales.
Aparte de las mejoras a nivel de efectividad, recuperación y capacidad de tratamiento, se pretendía dar un gran salto desde el punto de vista er-
gonómico para los trabajadores en los puestos de triaje y control de calidad, donde pasábamos de realizar un triaje en positivo a un triaje en negativo en líneas generales. Además, se contem-
= PUBLICIDAD
REGULATOR – CETRISA
SUMINISTRA LOS EQUIPOS DE SEPARACIÓN DE METALES
pló la instalación de cabinas en aquellos puestos donde no se contaba con una cabina por las características del diseño de la línea anterior. Otros aspectos a tener en cuenta, y no menos importantes, fueron las recomendaciones para unificar la elección de equipos para unificar los repuestos requeridos, la optimización de los recorridos de residuos sobre cinta transportadora, la minimización de los recorridos de maquinaria móvil y la disminución de la necesidad de uso de maquinaria móvil, así como la máxima accesibilidad a equipos para labores de mantenimiento mediante la optimización de recorridos de pasarelas en el diseño final. El valor estimado de la inversión ascendió a 4.698.987,10 € (IVA excluido), y los plazos de ejecución de los trabajos se acotaron a cuatro meses, incluyendo la demolición de la anterior línea de proceso. El diseño final propuesto por el integrador adjudicatario de la licitación cumplía con las exigencias y nos garantizaba una

PARA LA NUEVA PLANTA DE ALZIRA
REGULATOR – CETRISA, empresa líder en la fabricación de equipos para la separación y el reciclaje de metales, ha suministrado los equipos de separación de metales en la ampliación de la Planta de clasificación de envases de Alzira.
Se han suministrado un total de 4 equipos: un overband electromagnético y una polea magnética para la eliminación de material férrico y dos separadores inductivos para la separación de elementos metálicos no ferrosos.
El overband electromagnético corresponde al modelo R-SKM12.11 que permite trabajar hasta 500 mm de distancia de la banda y con una longitud magnética de 1.100 mm.
La polea magnética, colocada en la cabeza de la cinta transportadora, ayuda en la separación de los elementos férricos que están más cerca de la banda, cubiertos por otros materiales que dificultan su separación con otros equipos.
Los Separadores de inducción trabajan con anchos útiles de trabajo de 1200 mm y 1800 mm, modelos R-SPM1200-ADS y R-SPM1800-ADS. Poseen la configuración magnética adecuada para trabajar con el material procesado y están equipados con las últimas mejoras introducidas en todos los equipos en este último año.
REGULATOR – CETRISA ofrece a sus clientes su experiencia y know-how, aportando soluciones integrales en la valorización de residuos, mediante la separación y el reciclaje de metales.



disponibilidad de línea mínima del 95%, considerando este tiempo como el disponible de funcionamiento de la planta, sin paradas por motivos de mantenimiento no previstos. Dicha disponibilidad se justificaba gracias al trazado de las plataformas, escaleras, pasarelas y su interconexión, que garantizaba los desplazamientos rápidos del personal de planta y con ello la disponibilidad global de la planta para accesos rápidos a posibles incidencias de producción. También se dotaba a la línea de diferentes puntos de bypass para aquellos equipos que se consideraban críticos, tales como prensas, equipos abrebolsas o balísticos. En la remodelación realizada, uno de los cambios más evidentes nos lo encontramos en la etapa de preselección o triaje de voluminosos, donde se ha instalado una cabina que consta de seis tolvas diseñada para la segregación de cuatro materiales distintos. Se retira desde material valorizable como cajas de PEAD, garrafas, chatarra o sábanas de FILM industrial, a material voluminoso no recuperable valorizable que, mediante las tolvas,
se dirigirá a compactadores de rechazo. En este punto, se ha facilitado el trabajo de los triadores y se garantiza la ergonomía postural en los movimientos repetitivos.

tivos por cualquier circunstancia, se puede enviar el material a otra cinta de transporte, haciendo que pase por líneas alternativas sin tener que parar el proceso.
Superada la etapa de separación de voluminosos, el material es alimentado al trómel de tres cuerpos (< 40 mm, < Ø 240 mm, < Ø 400 mm). En este punto, se ha aportado modularidad en el diseño, haciendo que las cintas que recogen las fracciones sean reversibles, de modo que actúen de bypass. En el caso de que uno de los equipos que se encuentran a posteriori del trómel, como los separadores balísticos o abrebolsas, no se encuentren opera -
La fracción del hundido del trómel que presenta una granulometría menor a 40 mm es conducida al compactador de rechazo previo paso por un separador magnético. Los flujos procedentes del segundo y tercer hundido del trómel son alimentados a sendos separadores balísticos. La finalidad principal de esta etapa de clasificación densimétrica es la división del flujo de acuerdo con sus características físicas.
La separación balística da como resultado tres fracciones:





Rental RECYCLING
Maquinaria de compostaje y reciclaje nueva, de ocasión, restauradas o de alquiler rrt@rrt.es · www.rrt.es


• La fracción procedente del hundido del separador balístico presenta una granulometría menor a 40 mm y está formada principalmente por materia orgánica e inertes.
• La fracción rodante/pesada (3D), está compuesta fundamentalmente por envases ligeros y algunos elementos impropios. Esta fracción procedente de los dos separadores balísticos se recoge sobre la cinta y es conducida al proceso de selección automática de rodantes. Previo a los equipos de separación automática, se instala una boca de captación neumática para la recuperación de FILM.
• La fracción plana/ligera (2D) de ambos separadores balísticos, formada principalmente por FILM y papel/cartón. En el salto entre dos cintas donde se vierte, se ha instalado una boca de aspiración. Una vez retirado el material FILM, se dirigirá sobre cinta junto con el rechazo de selección automática de rodantes, donde se realiza un triaje manual. El material no seleccionado es enviado para alimentar la prensa de rechazos.
El sistema de captación neumático retirará tanto del flujo de rodantes como de planos la fracción de FILM por
medio de dos campanas de aspiración. El FILM aspirado se dirigirá mediante conducto hasta el decantador o válvula alveolar, que depositará la fracción sobre una cinta en la que se realiza un control de calidad del material. Tras pasar por dicho control, el material es conducido hasta una cinta reversible de alimentación a la prensa de FILM o a un troje automático de almacenamiento, en caso de avería de la prensa o necesidades de la producción.
Una vez se extrae del material rodante la fracción de FILM, este se transporta mediante una cinta a la línea de separación automática. Se ha implantado un modelo en línea, eliminando la alimentación a 90º, para conseguir tanto un funcionamiento mejor




CONTINÚA LIDERANDO LA GESTIÓN DE RESIDUOS EN LA COMUNIDAD
VALENCIANA, ADAPTÁNDOSE
de los equipos (mayores efectividades) como menores necesidades de limpieza (menos derrames) o mantenimiento. Al final de esta cinta se ha colocado un separador magnético; el material recuperado cae mediante tolva a una cinta de acumulación para ser prensado posteriormente en la prensa de metales. El material no seleccionado cae directamente sobre un separador de inducción, donde se recupera el alu-
minio, que será transportado mediante una cinta a la cabina de control de calidad. El aluminio seleccionado se acopiará en una cinta de almacenamiento. Igualmente, el material no seleccionado cae directamente y en línea a la cinta aceleradora del primer separador óptico de ancho útil 3.000 mm, monoválvula y de un solo canal, que recuperará PET. El material PET soplado por este separador óptico se transporta median-
te una cinta a un pinchabotellas y de ahí, a dentro de la cabina, donde tenemos el control de calidad. Finalmente, el PET seleccionado se almacena en dos bunkers automáticos y reversibles, a la espera de ser prensado. El material no seleccionado en el primer separador óptico es transportado a dos ópticos más de doble canal y de ancho útil 3.000 mm. En estos ópticos se separa el Cartón para Bebidas y Alimentos (CBA), PEAD y Plástico Mezcla (PM). Se dispone la opción de recircular el material de envases que se haya podido escapar para volver a la cascada de ópticos. El objetivo de la recirculación es corregir los errores cometidos en la separación óptica previa y de esta forma, volver a introducir material solicitado de nuevo a la cascada de separación óptica.

El material seleccionado por los ópticos, previo paso por los puestos de calidad, se almacena en los bunkers automáticos y reversibles a la espera de su prensado.
El rechazo de la cascada de separación óptica es recogido en una cinta transportadora y dirigida a un segundo separador inductivo que recupera el posible aluminio que haya podido pasarse del proceso inicial mejorando de esta manera la eficiencia del proceso. Lo que no seleccione el segundo inductivo se vierte sobre una cinta uniéndose al flujo de rechazo de planares sobre el que se realiza un triaje manual de los materiales que no han sido seleccionados de forma automática en la cabina principal. Los puestos de triaje disponen de tolvas para la selección del PM, CBA, FILM, PEAD y PET. Todos los materiales se pueden verter directamente sobre sus correspondientes silos automáticos y reversibles. Cabe destacar que, en caso de avería de alguna de las tres prensas de subproducto, el sistema permite prensar cualquiera de estos materiales en cualquiera de las tres prensas evitán-





dose paradas por avería o atasco de estos equipos.
La disposición final de cintas, prensas y equipos se ha realizado buscando minimizar el trasiego de contenedores y cabe destacar que todo el personal de triaje secundario y de control de calidad se encuentra en una misma cabina facilitando la rotación de puestos, así como cualquier movimiento entre ellos, sin necesidad de desplazarse por la planta, con mayor seguridad y optimización del tiempo empleado. Se ha implementado una red de pasarelas para mantenimiento que conectan los equipos de la línea, así como una plataforma o pasarela de visitas independiente para facilitar la visualización general del proceso evitando afectar a la operativa habitual de operación. Se consigue, de esta manera, un control de calidad óptimo sobre el material que se lleva a cada uno de los recuperadores. Con estas mejoras, VAERSA continúa liderando la gestión de residuos en la Comunidad Valenciana, adaptándose a las necesidades actuales y futuras con un enfoque en la eficiencia y la sostenibilidad.

Ambisort ha anunciado una nueva asociación con Italrec, empresa italiana líder en la fabricación de tecnologías y maquinaria para el reciclaje de materiales plásticos. Esta alianza tiene como objetivo proporcionar al mercado español maquinaria e instalaciones para mejorar significativamente la eficiencia y eficacia en la gestión y reciclaje de estos residuos.
Con más de 38 años de experiencia en el reciclaje de plásticos, Italrec desarrolla una amplia gama de máquinas sólidas y de alto rendimiento 100% fabricadas en Italia para el reciclaje de todos los polímeros. Las tecnologías de Italrec permiten procesar una amplísima gama de materiales: desde plásticos rígidos como HDPE, PP y PET, hasta film de origen industrial, urbano y agrícola. Su enfoque en la innovación tecnológica y en la satisfacción del cliente ha llevado al éxito de numerosos proyectos a nivel mundial.
• Líneas de lavado y flotación: Estos sistemas garantizan la correcta limpieza y separación de los plásticos antes de la extrusión, eliminando contaminantes y separando polímeros mediante flotación en agua, seguidos por una fase de secado para preparar el plástico para la granulación.

• Sistema de Densificación: DEC®. Un densificador continuo patentado capaz de procesar materiales con altos niveles de humedad residual, ofreciendo facilidad de uso, eficiencia energética y mejor calidad del producto final regenerado. Este sistema es esencial para eliminar completamente la humedad, aumentar el peso específico de los plásticos no rígidos y reutilizar materiales compuestos que normalmente se descartarían. Una máquina polivalente que encuentra sus usos en el reciclaje químico, reciclaje mecánico y producción de RDF.
• Líneas especiales: Para el tratamiento del residuo de pulper de papel, con sistema probado y certificado capaz de resolver el problema de los elevados costes de gestión derivados del vertido, separa del residuo recursos
Ambisort cierra una nueva asociación con Italrec, empresa italiana líder en la fabricación de tecnologías y maquinaria para el reciclaje de materiales plásticos. Esta alianza proporciona al mercado español maquinaria e instalaciones para mejorar significativamente la eficiencia y eficacia en la gestión y reciclaje de estos residuos
como plásticos poliolefínicos y fibra de papel. Recuperando como materia prima más del 90% de lo que antes se consideraba desecho.
Italrec no solo es un socio confiable a nivel mundial, sino que también puede diseñar soluciones innovadoras para productos que no se ajustan a los materiales tradicionalmente reciclados, gracias a su constante desarrollo técnico e importantes inversiones en I+D.
TECNOLOGÍA DE WESTERIA
Además de la alianza con Italrec, Ambisort incorpora la tecnología de Westeria para la separación de plásticos. Sus sistemas AirBasic, AirStar y AirLift utilizan corrientes de aire para separar plásticos de materiales más pesados, manejando grandes volúmenes de material y mejorando la pureza y calidad de los materiales reciclados.
Con estas tecnologías complementarias, Ambisort puede ofrecer una gama completa de equipos que se ajustan a las necesidades específicas de cada cliente, asegurando una gestión de residuos más eficiente y sostenible.
DIRECTOR DE ECONOMÍA CIRCULAR DE IHOBE

Las oportunidades que abre el ecodiseño para una economía circular
Nuria Suárez
TEMAS: ECODISEÑO, SOSTENIBILIDAD, ECONOMÍA
Hace ya más de una década que el Gobierno
Vasco trabaja para transformar los tradicionales patrones de fabricación y consumo y tornarlos más circulares. Ejemplo de ello es el
“Manual práctico de Ecodiseño para una economía circular” que ha publicado recientemente el organismo y que busca poner en valor los productos fabricados de manera sostenible en el territorio, haciendo de éstos la norma en el mercado. En esta entrevista hablamos con José María Fernández Alcalá, Director de Economía Circular de Ihobe, para conocer en detalle cómo está trabajando Ihobe para hacer extensiva la práctica del ecodiseño, el potencial de esta herramienta para transformar el tejido empresarial vasco y reducir el impacto ambiental de los procesos, cómo se alinean con el cumplimiento de los objetivos europeos y de qué manera se proyectan en los próximos años de cara a alcanzar un modelo económico circular.
Ihobe fue un organismo pionero en apoyar el diseño de productos con un enfoque circular en España. ¿Cómo definen el término ecodiseño desde la entidad? ¿cómo valoran la evolución de este campo en la última década?
Efectivamente, en Ihobe impulsamos el ecodiseño entre las empresas vascas desde 1999, animando a los distin -
tos sectores de producción a integrar el medio ambiente como aspecto a considerar en el diseño o rediseño de sus productos desde una perspectiva del ciclo de vida completo del mismo. Además, el ecodiseño es una pieza fundamental dentro de la Estrategia de Economía Circular de Euskadi 2030.
Como tal, el “ecodiseño” sería la de una metodología que considera los aspectos ambientales a lo largo del proceso de desarrollo de productos, esforzándose en conseguir minimizar el impacto ambiental de un producto a lo largo de su Ciclo de Vida. Se centra por tanto en dos claves: la primera conocer y medir el impacto ambiental del producto en todo su ciclo de vida para, a partir de ahí, reducir este impacto ambiental, mejorando su diseño.
En estos 25 años de experiencia acumulada, han sido muchas las empresas que han integrado plenamente el ecodiseño en su forma de concebir nuevos productos que poner en el mercado. Buen ejemplo de ello es “ZIRKULARRAK – Basque circular products exhibition”, una recopilación de más de 200 productos diseñados y fabricados en Euskadi, con casos concretos en 10 categorías de productos totalmente diferentes. Este trabajo de recopilación dio paso a una exposición itinerante que ha recorrido diferentes puntos de la geografía vasca y que aún se puede disfrutar en su web: https://zirkularrak.ihobe.eus/.
De entre los numerosos beneficios que el diseño para el reciclaje es capaz de brindar a las empresas, ¿cuáles serían los más destacados? ¿qué potencial atribuyen al ecodiseño de cara a mejorar el rendimiento empresarial?
En primer lugar, me gustaría señalar que el ecodiseño es mucho más que el diseño para el reciclaje. Antes del reciclaje tenemos el diseño para la durabilidad, el diseño para la reparabilidad, el diseño para la recuperación del producto… La visión del ecodiseño parte de las necesidades del usuario del producto, que es el centro del negocio. El ecodiseño busca cómo aportar mayor valor con el impacto ambiental mínimo posible, optimizando el consumo de materiales y reduciendo su huella ambiental y de carbono. Por ello, antes de pensar en el reciclaje, tenemos que optimizar al máximo las prestaciones con relación al cliente. Sólo cuando hayamos maximizado la vida útil del producto, pasaremos a pensar la forma de recuperar las materias primas contenidas en él, esto es, en el diseño para el reciclaje.
Así que, al analizar el ecodiseño desde una perspectiva de circularidad, se trata de maximizar el valor que aportamos como empresa, minimizando los impactos ambientales. No hay que perder de vista que el 80% del impacto ambiental de un producto se determina en la fase de diseño. Además de una estrategia de mejora ambiental, el ecodiseño se confirma como una estrategia de competitividad empresarial, al permitir ofertar productos de mayor valor que cada vez, afortunadamente, son mejor valorados y reconocidos por sus clientes, gracias al mejor nivel de información y mayor exigencia.
Este mismo año Ihobe ha lanzado un Manual práctico de Ecodiseño para una economía circular. ¿De qué manera esperan impactar en el tejido empresarial con esta herramienta? ¿cuáles son sus puntos más destacados?
En sus inicios, el ecodiseño se centraba en trasladar a las empresas la perspectiva de “ciclo de vida”, es decir, pensar más allá de lo que ocurría dentro de las empresas y analizar el producto

JOSÉ MARÍA FERNÁNDEZ ALCALÁ, IHOBE

tanto “aguas arriba” (obtención de materias primas y componentes) como “aguas abajo” (distribución, uso y fin de vida).
Este enfoque inicial ha permitido a las empresas importantes mejoras, pero se centraba exclusivamente en el pensamiento de que un producto iba a tener una única vida, la representada por una primera persona usuaria del mismo. Sin embargo, desde la perspectiva de la economía circular hoy vemos que los productos pueden y deben tener segundas y terceras vidas. Que un primer usuario renuncie a poseer un producto que ha adquirido, no quiere decir que tengamos que desecharlo. Es posible recuperarlo y volverlo a integrar el mercado, sea como una mera reutilización del mismo o aportando más valor a través de estrategias de recuperación del producto entre las que podemos mencionar la renovación, el reacondicionamiento y la remanufactura.
Por este motivo, Ihobe ha actualizado la metodología, publicando una nueva versión de la metodología de Ecodiseño, a través de un nuevo “Manual práctico de Ecodiseño para una economía circular”. Además, hemos querido intencionadamente que este nuevo manual sea respetuoso con el trabajo hecho por las empresas hasta la fecha incorporando la nueva visión que la circularidad puede aportar al ecodiseño.
A nivel europeo, el pasado mes de mayo se aprobaba un nuevo Reglamento sobre ecodiseño. ¿Cómo esperan que las nuevas normas y requerimientos impacten en los sistemas productivos?
Efectivamente el Parlamento Europeo aprobó el pasado 27 de mayo el nuevo Reglamento de ecodiseño que, tras su publicación en el Diario Oficial de la Unión Europea, entró en vigor el pasado 18 de julio. Se basa en el ecodiseño como punto de partida para la definición de nuevos patrones de producción y consumo acordes con los objetivos europeos en materia de sostenibilidad, en particular en relación con el clima, el medio ambiente, la energía y los objetivos en materia de uso de recursos y biodiversidad. Y lo hace introduciendo nuevos requisitos básicos de ecodiseño para mejorar la durabilidad, fiabilidad, reparabilidad, actualizabilidad, reutilizabilidad y reciclabilidad, así como las posibilidades de reacondicionamiento y mantenimiento de los productos. También aborda otras cuestiones como la presencia de sustancias químicas peligrosas en los productos, el aumento del contenido reciclado o la reducción en la generación de residuos a través de un reciclado de alta calidad. A su vez, presenta otras importantes novedades, como la puesta en marcha del Pasaporte Digital de Producto, con el que se pretende poner la información ambiental a disposición de los agentes que operan a lo largo del conjunto de la cadena de valor, la prohibición de destrucción de productos de consumo
no vendidos o la mejora de la vigilancia del mercado por parte de las administraciones públicas para luchar contra el fraude y la competencia desleal.
Todavía queda tiempo, porque a partir de ahora, la Comisión Europea debe establecer qué requisitos son los específicos para los distintos productos y productores, y los países de la UE dispondrán de 18 meses para cumplirlos, pero sin a lugar a dudas estamos ante un ambicioso nuevo texto legal que aspira a dar un impulso a aquellos productos y a aquellas empresas que ya han incorporado plenamente el ecodiseño en su forma de actuar.
El Reglamento europeo sobre ecodiseño aborda diferentes criterios de durabilidad, reutilización, actualización y reparabilidad del producto. ¿De qué manera apoyará Ihobe a las empresas para que cumplan con dichos requerimientos? ¿existen incentivos directos para este ámbito?
El nuevo manual de ecodiseño de Ihobe está totalmente alineado con las exigencias de este nuevo reglamento eu-
ropeo de ecodiseño. A partir de ahí, hemos puesto en marcha un amplio abanico de actividades orientadas a apoyar a las empresas. No perdamos de vista que este reglamento tiene dos visiones: una de cumplimiento legal, a través de la fijación de una serie de criterios de diseño obligatorios que deberán cumplir todos los productos de una misma categoría que se comercialicen en Europa; pero otra aún más importante de transparencia, orientada a la mejora de la competitividad de aquellas empresas que voluntariamente vayan más allá de estos requisitos mínimos. Tal y como establece el preámbulo de este nuevo reglamento, su objetivo último es que los productos sostenibles sean la norma en el mercado único europeo y para ello, pone en marcha instrumentos de información que, junto con otras medidas legales orientadas a la lucha contra el blanqueo ecológico o “greenwashing”.
En ese empeño estamos trabajando desde Ihobe y para ello, disponemos de diferentes líneas de actuación: informando y sensibilizando a las empresas a través de sesiones online gratuitas como nuestros “Ekostegunak – Jueves de econo-

JOSÉ MARÍA FERNÁNDEZ ALCALÁ, IHOBE
En materia ambiental, la legislación y la demanda de los clientes son los dos aspectos más relevantes a la hora de llamar a las empresas a la acción
mía circular”; con formación en el uso de nuevas metodologías y herramientas a través de nuestro programa formativo para profesionales en activo que ponemos en marcha con CONFEBASK, la Confederación Empresarial Vasca y sus organizaciones territoriales; desarrollando nuevas herramientas técnicas, pensadas especialmente para pymes, como es el caso de la nueva herramienta informática CLIMATE & CIRCULARITY CALCULATOR; acompañamiento en el desarrollo de proyectos a través de la iniciativa PYME Circular Euskadi; o reconociendo y divulgando aquellos casos de éxitos a través de campañas como la de “ZIRKULARRAK –Basque circular products exhibition”.
En términos de impacto ambiental, social y económico, ¿cuáles han sido algunos de los resultados más destacados de las políticas y programas de ecodiseño liderados por Ihobe? ¿qué obstáculos han enfrentado?
En Euskadi, al igual que ha ocurrido a nivel europeo, las medidas implementadas en materia de ecodiseño han tenido unos resultados muy importantes. Sólo hasta 2020, la Comisión Europea estimó que ambos instrumentos generaron ahorros anuales de energía por valor de 165 Mtep (millones de toneladas equivalentes de petróleo), aproximadamente al 9 % del consumo total de energía de la UE y una reducción del 7 % de las emisiones de carbono. Y de cara al futuro, se espera que las nuevas políticas de ecodiseño generen por sí solas un tercio de los ahorros necesarios para alcanzar el objetivo de reducción de emisiones del 55 % de la UE para 2030.
Su impacto no es sólo ambiental, pues mejora la competitividad y el posicionamiento de las empresas, como refleja el documento “Oportunidades de negocio que ofrece el ecodiseño a las empresas del País Vasco” que elaboramos entre Ihobe y el Instituto Vasco de Competitividad Empresarial, Orkestra.
Algunos obstáculos se corrigen en el nuevo reglamento de ecodiseño, conexas como la mejora de la información y la vigilancia de mercado, o en iniciativas legislativas como las relacionadas con el empoderamiento de los consumidores y la lucha contra el blanqueo ecológico. Otros responden a necesidades internas de las empresas como falta de conocimiento en el manejo de nuevas herramientas o inercias del pasado en la toma de decisiones. La incorporación de nuevo talento en las organizaciones es clave para afrontar un modelo económico que incorpora reglas de juego diferentes.
La implantación de una economía circular requiere de una fuerte colaboración interdisciplinar. ¿De qué manera fomentan modelos participativos entre empresas y administraciones? ¿qué beneficios directos se derivan de involucrar a todos los agentes de la cadena de valor?
Sin lugar a duda, la colaboración público-privada está en el ADN de las líneas de trabajo de Ihobe. Así la hacemos a través de 3 iniciativas que disponemos para esta colaboración. La primera, el Basque Ecodesign Center donde integramos
La incorporación de nuevo talento en las organizaciones es clave para afrontar un modelo económico que incorpora reglas de juego diferentes
a grandes empresas líderes en sus respectivos sectores de actividad y que nos sirve para el desarrollo conjunto de nuevos marcos metodológicos y la tracción de las cadenas de suministro locales. Actualmente, contamos ya con 18 grandes empresas que a su vez aglutina alrededor de 16.000 firmas proveedoras en todo el mundo. La segunda iniciativa sería PYME Circular Euskadi donde trabajamos directamente con las pymes, nuestro principal cliente. Sólo el año pasado, Ihobe prestó servicios a más de 1500 de ellas gracias a la participación y al trabajo en red con los 28 agentes intermedios. Por último, contamos con Basque Circular Hub, red de centros de servicios avanzados en economía circular de Euskadi, en el que trabajamos la vigilancia, el desarrollo de nuevo conocimiento, el talento, el empleo verde y la capacitación de profesionales en activo. Es una iniciativa que aglutina a todas las universidades que operan en el País Vasco, así como a la red de centros de formación profesional integrados en Tknika.
Entre los eslabones del ciclo de vida de un producto, destaca su correcto tratamiento. Con las innovaciones en diseño y tecnología, ¿qué oportunidades se abren para mejorar la eficiencia del tratamiento de residuos?
Ante este nuevo paradigma, ¿cómo deberán las empresas adaptar sus estrategias de producción para cumplir con las normativas ambientales más estrictas? ¿cuál será el rol que adopte el consumidor en todo este proceso?
Hay dos estímulos en temas ambientales que mueven a las empresas por encima del resto: la legislación y la demanda de los clientes.
Más allá de la trasparencia, las empresas deben contar con incentivos económicos que les permitan rentabilizar la incorporación de estrategias de diseño que mejoren la reciclabilidad
En una economía plenamente circular, los residuos no existen y solo hablaríamos de recursos. Si lo pensamos bien, un residuo es un recurso ineficientemente gestionado y eso, no debería darse. Es necesario dar un impulso al fomento de la reciclabilidad real de los productos, desarrollando métodos que evalúen correctamente la reciclabilidad de un producto e integrarla como un aspecto más de información al consumidor a través del futuro pasaporte digital. Más allá de la trasparencia, las empresas deben contar con incentivos económicos que les permitan rentabilizar la incorporación de estrategias de diseño que mejoren esta reciclabilidad. La ecomodulación positiva de las tasas asociadas a los sistemas colectivos de responsabilidad ampliada del productor (SCRAP) puede ser un buen ejemplo de ello. Trabajando con esta perspectiva, conseguiremos que los productos en su fin de vida sean auténticos sumideros de recursos que poder reintegrar en la economía de forma competitiva.
Dentro del Pacto Verde Europeo, se han desarrollado iniciativas para activar un consumo de productos sostenibles. En el ámbito de compra entre empresas podemos encontrar medidas como la responsabilidad ampliada del productor, que obliga a que la empresa que comercialice un producto asuma la responsabilidad sobre la totalidad del mismo, , y nuevos instrumentos como el de la diligencia debida, que obliga a que las grandes empresas adopten un sistema basado en el riesgo para prevenir, mitigar, eliminar o minimizar los efectos adversos sobre el medio ambiente derivados de sus propias actividades, filiales y socios comerciales a lo largo de la cadena de actividades de estas. En el ámbito de compra que une a empresas y consumidores finales, se ha aprobado la nueva directiva de empoderamiento de los consumidores para la transición ecológica, publicada el pasado mes de febrero, y que persigue mejorar los derechos de las personas consumidoras frente a las alegaciones “ecológicas” engañosas. Esta normativa se complementará con la futura Directiva sobre Alegaciones Ecológicas que se enfocará en regular las ecoetiquetas y alegaciones ambientales para que sean fiables.
Con una visión más a largo plazo y relacionado con la transición hacia una economía circular, ¿qué relevancia tendrá de aquí a unos años el diseño sostenible de productos? ¿de qué manera se espera que transforme el tejido empresarial vasco?
Si analizamos las directrices políticas presentadas por Ursula von der Leyen en la sesión de investidura celebrada en Estrasburgo el pasado 18 de julio, veremos que las dudas sobre la ambición europea en materia de sostenibilidad se han disi-
JOSÉ MARÍA FERNÁNDEZ ALCALÁ, IHOBE

En los próximos años deberemos ser capaces de transformar no sólo los productos que fabricamos, sino también el tejido industrial para liderar las oportunidades que abre la economía circular
pado. Una de sus primeras promesas consistió, precisamente, en la implementación plena del marco legal emanado del Pacto Verde Europeo en el horizonte del año 2030. En una visión a largo plazo, podemos esperar en Europa un nuevo modelo, si no plenamente circular, sí al menos mucho más eficiente en el consumo de recursos con un claro objetivo de alcanzar la ansiada neutralidad climática en 2050. En esa nueva economía, los productos líderes en el mercado europeo serán cada vez más sostenibles. Esta nueva economía va a requerir también importantes cambios en la forma en la gestión de las empresas. No hay que perder de vista que, si un producto dura más, va a ser necesario fabricar menos unidades para satisfacer la demanda del mercado. Y ello puede tener implicaciones en el empleo. Afortunadamente esto tiene solución apostando por concep-
tos como el de la servitización, donde el producto no desaparece, sino que se crean nuevas propuestas de valor agregando servicios asociados al mismo. Y ahí se generan nuevos empleos. Se estima que la plena aplicación de los principios de la economía circular podría generar en Europa más de 700.000 nuevos empleos en 2030. Para abordar el reto de la servitización, junto con el nuevo manual de ecodiseño, Ihobe acaba de publicar el trabajo “Del producto al modelo de negocio: servitización en una economía circular”, que permite profundizar en este concepto.
Por lo tanto, el reto que tenemos para los próximos años consiste en ser capaces de transformar no sólo los productos que fabricamos, sino también nuestro tejido industrial para poder liderar las oportunidades que se nos abren con el cambio hacia este nuevo modelo económico circular.
Con el foco puesto en extender el ciclo de la vida de los productos y acelerar la transición circular del continente europeo, el diseño ecológico se postula cada vez más como un requisito indispensable para comercializar bienes en la UE. Tres expertos en la materia desgranan su previsible impacto, evolución y desafíos.

DAVID ALLO RESPONSABLE DE SOSTENIBILIDAD EN TEXFOR

SONIA GARCÍA-HERAS RESPONSABLE DE EPR Y RECICLAJE DE PRODUCTO EN DECATHLON ESPAÑA

SANDRA RAMOS INVESTIGADORA EN ECONOMÍA CIRCULAR Y MEDIO AMBIENTE EN AIMPLAS
-1-
¿QUÉ DESAFÍOS ENFRENTAN LAS EMPRESAS AL DESARROLLAR PRODUCTOS ECODISEÑADOS?

David Allo, TEXFOR
Para empezar, la propia definición de ecodiseño y qué es sostenible. En la actualidad, la UE está trabajando con la norma de Ecodiseño que estará lista en el año 2027. Por ahora, la sostenibilidad es una entelequia con muchas definiciones, cada una con sus sensibilidades. Por eso es tan importante definir, tal y cómo se hizo hace años con la Agricultura Ecológica. Aunque en el caso del textil será más complejo por la diversidad sectorial, los impactos deslocalizados y el cómo hacer la labor de vigilancia fuera de fronteras.
El Ecodiseño en sector textil es algo muy técnico y complejo debido a la diversidad de productos y procesos. Si miras a tu alrededor, el textil está por todas partes con diferentes composiciones, mezclas y acaban generando infinidad de productos (Automoción, hogar, agricultura, decoración, sanitario, etc.). Si te miras al espejo, verás que cada día vestimos también diferentes composiciones y acabados. Esto se traduce en complejidad y poca homogenización, justo lo contrario a lo que cualquier norma o estándar necesita.
En general, para hacer abordajes de ecodiseño las cosas cuanto más homogéneas y simples mejor; así resulta más sencillo marcar indicadores y mejorarlos. De eso trata el ecodiseño, de medir y mejorar. Hay que ir de materia prima a materia prima y proceso a proceso, buscando mejoras, puesto que cada producto tiene su finalidad. Poliéster y Algodón no son comparables. Por ser simplistas, quizás podemos comparar por bloques de materias primas (naturales, sintéticas y artificiales) pero cuando llegamos a procesos y especialmente acabados, se hace muy complejo.

Sonia García-Heras, Decathlon
El primer desafío es el cambio de mentalidad a la hora de concebir un producto. Es crucial que la funcionalidad del producto sea tan prioritaria como los principios de la economía circular. Por lo tanto, debemos considerar todo el ciclo de vida del producto, desde la extracción de las materias primas hasta su fin de vida, evaluando el impacto que tendrá a nivel medioambiental, social y económico.
Para adoptar este enfoque circular, la formación y la capacitación son fundamentales. En nuestro equipo, contamos con aproximadamente 580 ingenieros de producto y 400 diseñadores, todos ellos formados en ecodiseño. Esto les permite integrar la evaluación del ciclo de vida y del impacto del producto en sus decisiones desde las primeras etapas del desarrollo.
En Decathlon, creemos que la formación debe ser integral y abarcar a todos los niveles, desde nuestros ingenieros de
producto y diseñadores, que tienen el primer contacto con el desarrollo del producto, hasta nuestros vendedores, que están en contacto directo con los clientes. Por ello, hemos capacitado a todos nuestros equipos en los principios de la economía circular. En España, específicamente, hemos formado a más de 10.000 empleados. Además, en nuestras tiendas, contamos con un equipo especializado en circularidad que trabaja en los modelos de negocio circulares disponibles en Decathlon, como el alquiler, la suscripción, la compra-venta de material de segunda vida y nuestro servicio de taller y mantenimiento. Otro gran desafío es combinar las características técnicas y/o funcionales con las consideraciones medioambientales. En nuestro caso, diseñamos productos para la práctica deportiva, donde las características técnicas son imprescindibles. No siempre es fácil integrar la tecnicidad con el ecodiseño. Para lograrlo, es esencial recurrir a la innovación y a soluciones disruptivas que nos permitan seguir mejorando nuestros productos y sus prestaciones, minimizando su impacto ambiental.

Para las empresas supone un desafío porque tienen que modificar el concepto con el que diseñan los nuevos productos en todas las etapas de su ciclo de vida. Pero esto a su vez, significa una inversión hacia sí mismos, ya que reutilizar y compartir recursos tiene también un gran beneficio desde el punto de vista económico, ya que supone una ventaja competitiva
de diferenciación, valor añadido, reducción de costes económicos y de reducción del impacto ambiental. Alinearse con una economía circular ofrece una oportunidad para reinventar la economía, haciéndola más sostenible y competitiva en el mercado. El primer paso para una implementación eficaz del ecodiseño en una empresa sería crear una nueva cultura sensibilizando a sus trabajadores y clientes, enfocándose en las ventajas que supone la economía circular.

Sonia García-Heras, Decathlon
El ecodiseño es el núcleo de una economía circular y, por tanto, imprescindible para la transición hacia ella. Sabemos que el 80% de los impactos medioambientales de un producto se determinan en su etapa de concepción o diseño.
-2-
¿CUÁL

David Allo, TEXFOR
Infinito. Estamos en un momento muy interesante en cuanto a esa transición, ganando estructura de definiciones, de conocimiento y en un futuro cercano de mercado también. En el ámbito estatal, España está bien posicionada en cuanto a producción de materias primas, liderando a escala europea la producción de hilo de algodón reciclado, con marcas internacionales, etc. Sería genial conseguir en sostenibilidad y circularidad lo que el “Made in Italy” consiguió con el diseño y que esto permita ganar competitividad a productores de materias primas, industriales, marcas y resto de grupos de interés sectoriales.
Si observamos los principios de la economía circular, todos hacen referencia a conceptos de diseño como la durabilidad, reparabilidad y reciclabilidad. Por tanto, el diseño posibilita la aplicación de estos principios, ya sea al crear un producto, un servicio o un modelo de negocio.
El ecodiseño nos permite aplicar un pensamiento sistémico al desarrollar soluciones. Como dijo Albert Einstein, “los problemas relevantes a los que nos enfrentamos no pueden solucionarse aplicando el mismo nivel de conciencia que quien los ha creado”. El diseño de un modelo económico lineal ha tenido éxito en la creación de productos asequibles a gran escala, pero también ha sido la causa subyacente del cambio climático, la pérdida de biodiversidad y la escasez de recursos naturales. Según la Fundación Ellen MacArthur, la extracción y procesamiento de recursos naturales para la fabricación de productos representa más del 90% de la pérdida de biodiversidad y del estrés hídrico. Además, el 45% de las emisiones globales de gases de efecto invernadero provienen de cómo fabricamos y usamos los productos.
Por tanto, el potencial del ecodiseño en la transición y transformación de una economía lineal a una circular es incuestionable.
Para Decathlon, el ecodiseño es clave para avanzar hacia una economía circular. Por ello, trabajamos con una metodología de ecodiseño exigente, avalada por la comunidad científica. En nuestro caso, comenzamos a trabajar en 2007 junto a ADEME (la Agencia Francesa del Medio Ambiente). Posteriormente, en 2013 nos unimos a la Comisión Europea para participar en los grupos de trabajo de la Product Environmental Footprint (PEF), y como resultado de este esfuerzo, en 2016 lanzamos nuestro primer producto ecodiseñado: el forro polar Forclaz 50. Elegimos este producto porque era uno de nuestros más vendidos en todos los países, por lo que sabíamos que su impacto sería significativo.
Desde entonces, hemos ido incorporando más productos ecodiseñados a nuestra oferta, lo que ha llevado a que en 2023 el 38,8% de nuestras ventas provenga de productos ecodiseñados, una cifra que durante este año está creciendo exponencialmente. Finalmente, el año pasado recibimos la calificación de “ejemplar” en el sello AFAQ ECO DESIGN otorgado por AFNOR, la más alta que concede este sello. Este reconocimiento, sin duda, nos enorgullece y nos motiva a seguir trabajando y mejorando en la aplicación de criterios de ecodiseño en nuestros productos.

Sandra Ramos, AIMPLAS
El ecodiseño es una estrategia clave que impulsa la transición hacia una
economía circular. El potencial del ecodiseño radica en la incorporación de medidas preventivas durante las fases de su ciclo de vida (producción, uso y fin de vida) priorizando alternativas más sostenibles y, por lo tanto, disminuyendo su impacto medioambiental. De esta forma, se facilita la reutilización o reciclaje del producto una vez ha finalizado su ciclo vida.
ropa laboral para policías, médicos..., o cuando se compra cualquier producto textil para un teatro, butacas, decoración… sólo se mira el precio y no las condiciones de fabricación de estos productos.

Sonia García-Heras, Decathlon
En Decathlon, creemos firmemente que la armonización de la definición y los requisitos de ecodiseño son fundamentales para avanzar hacia una economía circular.

Sandra Ramos, AIMPLAS
-3-
¿CÓMO CONTRIBUIRÁ LA NUEVA LEGISLACIÓN SOBRE ECODISEÑO A LA TRANSICIÓN HACIA UNA ECONOMÍA CIRCULAR?

David Allo, TEXFOR
Pues veremos a ver. De entrada, más legislación es casi siempre sinónimo de menos competitividad. Como siempre, sobrevivirán los que mejor se adapten. Lo que más temor da, es el posible poco control de mercado y que sea mejor saltar la norma que cumplirla o que se pierda competitividad en mercados internacionales.
Otro punto muy doloroso, es que las Administraciones públicas no sean ejemplificadoras con más y mejor compra pública sostenible. Aquí se exige legislación ambiental y social para producir, pero cuando se compra
En Decathlon, acogemos de manera muy positiva el nuevo reglamento sobre ecodiseño de productos sostenibles.
Sin duda, este reglamento contribuirá al logro de los objetivos climáticos y energéticos de la Unión Europea. Además, consolidará una política de productos sostenibles que impulsará la eficiencia en el uso de recursos, la protección de la biodiversidad y la salud de los ciudadanos, al mismo tiempo que protegerá a los consumidores.
La implementación de requisitos de ecodiseño comunes en toda la Unión Europea fomentará el desarrollo de productos más sostenibles y facilitará la adopción de nuevos modelos de negocio circulares.
El reglamento también ayudará a las empresas y a la industria a incorporar criterios circulares y de ecodiseño de manera armonizada y equitativa en todos los países miembros.
Al garantizar que en la UE sólo circulen productos que cumplan con los requisitos del nuevo reglamento, se facilitará su libre circulación y se asegurará la reducción del impacto medioambiental a lo largo de todo el ciclo de vida de los productos.
La nueva legislación servirá de impulso para lograr la transición hacia una economía circular. Recientemente, ha entrado en vigor el nuevo reglamento 2024/1781 de ecodiseño que tiene por objeto establecer requisitos de diseño ecológico que deben cumplir los productos para su introducción en el mercado o su puesta en servicio, con el objetivo de mejorar la sostenibilidad medioambiental para hacer productos más sostenibles y reducir la huella de carbono y la huella medioambiental global a lo largo de su ciclo de vida, y de garantizar su libre circulación en el mercado interior. Además, el presente Reglamento establece un pasaporte digital del producto, dispone el establecimiento de requisitos obligatorios de contratación pública ecológica y crea un marco para prevenir la destrucción de productos de consumo no vendidos.
Por lo tanto, el ecodiseño es clave para desarrollar un futuro sostenible a nivel europeo ya que con esta estrategia se implementan acciones más sostenibles que suponen un menor impacto ambiental y un acercamiento a los objetivos de sostenibilidad marcados por la UE.
EN PRIMERA PERSONA

DVÍCTOR MORALO
PARTNER EN ECIJA
esde el 18 de julio de 2024 está vigente el Reglamento (UE) 2024/1781 del Parlamento Europeo y del Consejo, de 13 de junio de 2024, por el que se establecen los requisitos de ecodiseño de productos sostenibles.
Los objetivos principales de este Reglamento son la reducción de los impactos ambientales negativos del ciclo de vida de los productos, la mejora del funcionamiento del mercado interior, impulsar la oferta y la deman-
da de bienes sostenibles, lograr una producción sostenible y garantizar unas condiciones de competencia equitativas para los productos que se venden en el mercado interior. Fomenta el diseño ecológico, abarcando durabilidad, reutilizabilidad y eficiencia energética, y establece requisitos armonizados para la industria. También prevé la creación de un pasaporte digital del producto para el establecimiento de criterios obligatorios de contratación pública ecológica y crea un marco para prevenir la


destrucción de productos de consumo no vendidos.
El referido Reglamento establece como obligatorio el Pasaporte Digital del Producto (DPP), que se define como un conjunto de datos específicos de un producto que incluye la información sobre la sostenibilidad del mismo, previamente definida por la Comisión Europea para cada grupo de producto, y al que se puede acceder por medios electrónicos mediante un soporte de datos. Esta información está relacionada con los aspectos del diseño ecológico: actualizabilidad, reparabilidad, mantenimiento y reacondicionamiento de los productos; presencia de sustancias preocupantes en los productos; eficiencia de los productos en cuanto al uso de energía y de recursos; contenido de material reciclado en los productos; refabricación y reciclado de los productos; huella de carbono y huella ambiental de los productos; generación prevista de residuos de los productos.
Los productos solo podrán introducirse en el mercado europeo si existe un DPP que cumpla con los requisitos
EL REGLAMENTO DE ECODISEÑO DE PRODUCTOS SOSTENIBLES ESTABLECE COMO OBLIGATORIO EL PASAPORTE DIGITAL DEL PRODUCTO (DPP), ESTABLECE CRITERIOS OBLIGATORIOS DE CONTRATACIÓN PÚBLICA ECOLÓGICA Y CREA UN MARCO JURÍDICO PARA PREVENIR LA DESTRUCCIÓN DE PRODUCTOS DE CONSUMO NO VENDIDOS

de información relacionados con los aspectos de sostenibilidad a los que nos hemos referido. La información requerida debe estar disponible en el producto, su envase, el pasaporte del producto, una etiqueta, un manual de usuario, o un sitio web, y debe ser comprensible para los consumidores.
La nueva norma estable los requisitos aplicables al DPP. Para empezar, el pasaporte debe reunir una se-
rie de condiciones: estar vinculado a un identificador único a través de un soporte de datos, el cual debe estar presente físicamente en el producto, su envase o en la documentación que lo acompañe; toda la información en el pasaporte debe seguir estándares abiertos, estar en un formato que pueda funcionar con diferentes sistemas, y ser legible por máquina y accesible mediante búsqueda; y la información
incluida puede referirse al modelo del producto, al lote o al artículo.
Por otro lado, los pasaportes de los productos deben ser totalmente interoperables con otros DPP en relación con los aspectos técnicos y organizativos de la comunicación y la transferencia de datos. Los consumidores y los agentes económicos tendrán acceso gratuito al pasaporte del producto en función de sus derechos de acceso respectivos. Los datos contenidos en el pasaporte serán almacenados por el agente económico responsable o sus representantes autorizados. Si estos representantes manejan los datos, no podrán venderlos, reutilizarlos o tratarlos más allá de lo necesario para los servicios de almacenamiento o tratamiento correspondientes.
Se debe asegurar la autenticación, fiabilidad e integridad de los datos. Los DPP se diseñarán y operarán para asegurar un alto nivel de seguridad y privacidad, evitando el fraude.
La Comisión Europea creará y mantendrá un Registro que almacenará la información de los DPP. Este registro contendrá, como mínimo, datos sobre los productos y sus identificadores únicos. El agente económico que introduzca el producto en el mercado cargará la información requerida en el registro. Además, la Comisión determinará la información adicional que se almacenará, teniendo en cuenta los siguientes crite-
LOS PRODUCTOS SOLO PODRÁN INTRODUCIRSE EN EL MERCADO EUROPEO SI EXISTE UN DPP QUE CUMPLA CON LOS REQUISITOS DE INFORMACIÓN RELACIONADOS CON LOS ASPECTOS DE SOSTENIBILIDAD + VÍCTOR MORALO,
rios: la necesidad de verificar la autenticidad del pasaporte, la pertinencia de la información para mejorar la eficiencia de los controles de mercado y aduaneros, y evitar una carga administrativa excesiva para los agentes económicos. La Comisión será considerada responsable del tratamiento de datos personales en el registro.
La Comisión también conectará el Registro con el sistema de intercambio de certificados de la ventanilla única aduanera de la Unión Europea, permitiendo el intercambio automatizado de información con los sistemas aduaneros nacionales, y especificará los detalles de dicha interconexión mediante un acto de ejecución. Las autoridades aduaneras comprobarán, antes de autorizar el despacho a libre práctica, si el identificador único de producto incluido en la declaración aduanera coincide con uno registra-
do en el registro. Cuando la información contenida en el pasaporte se almacene también en un registro, la Comisión podrá especificar que las autoridades aduaneras verifiquen la coherencia entre la información almacenada en el registro y la declaración en aduana antes de autorizar el despacho. Para ello, la Comisión tendrá en cuenta, como mínimo, la necesidad de mejorar el cumplimiento de los productos introducidos en el mercado de la Unión con los requisitos de diseño ecológico y la necesidad de evitar una carga desproporcionada para las autoridades aduaneras. Si se encontrasen discrepancias, se denegará el despacho y se notificará a las autoridades competentes. La verificación se realizará electrónicamente y de forma automática a través del entorno de ventanilla única de la UE para las aduanas. Las autoridades aduaneras podrán obtener y utilizar la información contenida en el pasaporte del producto y el registro para el desempeño de sus funciones.
En definitiva, podemos decir que el DPP aumentará la información disponible del producto en materia de sostenibilidad y facilitará el acceso a ella. Permitirá a los consumidores evaluar los productos y compararlos, tomar decisiones de compra más sostenibles y, con ello, cambiar los hábitos de consumo, lo que hará posible la transición a una economía circular.
EL DPP AUMENTARÁ LA INFORMACIÓN DISPONIBLE DEL PRODUCTO EN MATERIA DE SOSTENIBILIDAD Y FACILITARÁ EL ACCESO A ELLA. PERMITIRÁ A LOS CONSUMIDORES EVALUAR LOS PRODUCTOS Y COMPARARLOS, TOMAR DECISIONES DE COMPRA MÁS SOSTENIBLES Y, CON ELLO, CAMBIAR LOS HÁBITOS DE CONSUMO, LO QUE HARÁ POSIBLE LA TRANSICIÓN A UNA ECONOMÍA CIRCULAR
TECNOLOGÍA
En la gestión moderna de residuos, la compactación eficiente de materiales reciclables como el cartón y el plástico es crucial. Las prensas verticales de Bramidan y las soluciones PRESTO ofrecen los avances para conseguirlo y con la incorporación de tecnologías como BRA-IN y PRES-TO-GO, las empresas pueden optimizar sus procesos de
compactación, reducir costos y mejorar su eficiencia operativa.
COMPACTADORAS Y PRENSAS VERTICALES BRAMIDAN
La marca Bramidan se ha consolidado como líder en el ámbito de las compactadoras y prensas verticales. Equipadas con la última tecnología

Con la incorporación de tecnologías como BRA-IN de Bramidan y PRES-TO-GO de PRESTO, las empresas pueden optimizar sus procesos de compactación, reducir costos y mejorar su eficiencia operativa
y diseñadas para mejorar el manejo de residuos, destacan por su ciclo de prensado rápido. Esto se traduce en un significativo ahorro de tiempo y dinero para las empresas, ya que reduce el tiempo que los operarios deben dedicar a la manipulación de residuos, permitiendo que se enfoquen en otras tareas productivas.
Bramidan ofrece una amplia gama de prensas verticales que abarcan desde las 3 hasta las 50 toneladas de presión y son capaces de crear balas que varían entre los 30 y los 600 kilos,
adaptándose a las necesidades específicas de cualquier empresa.
AUTOCOMPACTADORAS Y PRENSAS HORIZONTALES CONTINUAS PRESTO
En el caso de las empresas que manejan grandes volúmenes de desechos, las auto-compactadoras PRESTO representan la solución ideal. Sus contenedores están pensados para tratar cantidades significativas de residuos reciclables, residuales o industriales similares a los domésticos. En particular, los contenedores compactadores de desechos húmedos PRESTO son altamente efectivos para eliminar grandes cantidades de basura residual o industrial húmeda.
En el ámbito del reciclaje de papel, cartón, plástico y otros materiales reciclables, las prensas horizontales continuas de PRESTO son una opción eficaz y fiable. Estas prensas automáticas son capaces de manejar tareas de compactación a gran escala, lo que las convierte en una herramienta indispensable para empresas de diversos sectores. La robustez y la eficiencia de estas prensas aseguran

un rendimiento óptimo en gestión de reciclables.
Y MONITOREO CON TECNOLOGÍA BRA-IN Y PRES-TO-GO
Una característica que une a todas las soluciones de Bramidan y PRESTO es la tecnología BRA-IN y PRES-TO-GO. Esta avanzada tecnología permite co -

nectar todos los equipos de compactación, proporcionando una vista integral de 360 grados sobre el funcionamiento del equipo y minimizando los costos directos e indirectos del manejo de residuos a lo largo del tiempo.
Por otra parte, el sistema de monitoreo brinda numerosos beneficios de eficiencia, independientemente de si se utiliza una única prensa vertical o una flota completa de máquinas. Entre las ventajas se incluyen la recopilación de datos sobre niveles de llenado, balas listas para recolección y errores de funcionamiento, así como la visualización del rendimiento y la ubicación de las máquinas. Además, este sistema facilita la interacción con el equipo mediante notificaciones relevantes para los gestores de residuos.
Todas estas innovaciones no solo simplifican el control y el ahorro, sino que también posicionan a Bramidan y PRESTO a la vanguardia del competitivo mercado de la gestión de residuos.


La gestión de residuos alrededor del mundo es un problema intrincado y multifacético, que involucra una red compleja de partes interesadas y depende de múltiples factores interrelacionados. A pesar de los esfuerzos colectivos de gobiernos, organizaciones no gubernamentales, el sector privado y trabajadores informales para abordar esta crisis, la naturaleza “perversa” del problema lo hace difícil de resolver con soluciones simples. La efectividad de los sistemas de gestión de residuos requiere no solo la participación activa del sector privado en el diseño de productos, sino también un cambio de comportamiento masivo en los hogares. Además, factores como los precios globales del petróleo, el valor de los materiales reciclables y la inestabilidad geopolítica añaden más capas de complejidad, lo que dificulta la implementación de soluciones universales y perpetúa los problemas ambientales asociados, como las emisiones de GEI y la pérdida de biodiversidad. Basado en el reciente informe de Perspectivas mundiales de la gestión de residuos 2024*: “Más allá de la era de los residuos:* Convertir la basura en un recurso”, elaborado por el Programa
de las Naciones Unidas para el Medio Ambiente (UNEP) junto con la International Solid Waste Association (ISWA), el presente reportaje profundiza en los obstáculos a enfrentar para transformar el modelo de gestión de residuos; y explora las vías convergentes para prevenir y gestionar los residuos de forma eficiente.
Desatención a la urgencia del reto de los residuos
La urgencia del reto de los residuos constituye un problema crítico que afecta profundamente tanto a la sociedad como al medio ambiente. Sin embargo, la falta de reconocimiento de este desafío global representa uno de los principales impedimentos para el desarrollo soluciones efectivas y sostenibles. Por esta razón, es imperativo que la crisis actual motive un compromiso urgente por parte de los líderes políticos, productores y otras partes interesadas para asumir una mayor responsabilidad y adoptar medidas más ambiciosas.
En este contexto, la carencia de datos precisos sobre la contaminación y riesgos para la salud pública asociados


igualdad. Sin un reconocimiento explícito de estas disparidades, los avances hacia una economía más circular y justa son limitados.
a los residuos no controlados agrava la situación. La mala gestión de residuos se relaciona con una amplia gama de enfermedades, incluyendo problemas de fertilidad y desigualdades sanitarias a largo plazo. Sin embargo, la falta de registros adecuados sobre la eliminación informal de residuos, como el vertido o la incineración ilegal, o la cada vez mayor complejidad de los productos, que contienen productos químicos peligrosos, dificultan la comprensión real de los impactos ambientales y sobre la salud humana, subestimando así las consecuencias de estos residuos. Por otro lado, los impactos climáticos derivados de la generación y gestión de residuos han sido históricamente subestimados, lo que ha resultado en una falta de inversión en su reducción como estrategia de mitigación del cambio climático. A pesar de que se estima que entre el 15% y el 25% de las emisiones globales de gases de efecto invernadero (GEI) podrían mitigarse con una mejor gestión de residuos, este potencial sigue sin ser plenamente reconocido en las políticas nacionales e internacionales. Ejemplo de esto ha sido que las emisiones de metano, un potente gas de efecto invernadero proveniente de la descomposición anaeróbica de residuos orgánicos en vertederos, o las emisiones de la quema abierta de residuos, no hayan sido evaluadas ni registradas correctamente, lo que reduce las oportunidades de inversión en la recogida y valorización de residuos orgánicos.
Falta de inclusión
En segundo lugar, la gestión de residuos enfrenta desafíos significativos
debido a la falta de inclusión en las políticas e infraestructuras, que no reconocen adecuadamente los aspectos de género y subestiman el papel del sector informal. Este actual enfoque excluyente ha llevado a que las decisiones de gestión de residuos sean menos efectivas e inadecuadas para el contexto local, lo que aumenta los riesgos de fracaso. En este sentido, es esencial que las políticas futuras adopten un enfoque más inclusivo, que valore y aproveche las contribuciones de todos los actores involucrados, desde las mujeres y los jóvenes hasta los trabajadores informales, para lograr una gestión de residuos más equitativa y sostenible.
A este respecto, uno de los retos persistentes es la falta de reconocimiento de las diferencias de género presentes en la cadena de valor, un problema significativo que perpetúa estereotipos y limita la capacidad de las mujeres para influir en las decisiones que afectan su vida diaria. Las mujeres, a menudo responsables de la gestión de residuos en el hogar y participantes clave en el sector informal, enfrentan riesgos de salud, condiciones laborales precarias, y discriminación. Además, cuando los sistemas de gestión se formalizan, las mujeres corren el riesgo de quedar excluidas de oportunidades de formación y empleo, lo que refuerza aún más la des-
También, el sector informal, que desempeña un papel crucial en la gestión de residuos, especialmente en regiones donde los servicios formales son deficientes, ha sido históricamente infravalorado. Estos trabajadores, que incluyen un alto porcentaje de mujeres, jóvenes, personas con bajos ingresos y otras comunidades vulnerables, realizan tareas esenciales como la recolección y clasificación de residuos, a menudo en condiciones peligrosas y sin reconocimiento legal. A pesar de su importancia, este sector sigue siendo marginado en las políticas de desarrollo, ignorando su experiencia y conocimiento, y obviando su contribución a la economía, la sociedad y el medio ambiente. Asimismo, la formalización de servicios puede desplazar a estos trabajadores, privándolos de sus medios de subsistencia, lo que subraya la necesidad de proteger sus derechos y garantizar su inclusión en la transición hacia una economía circular. La desilusión y el pesimismo en las comunidades locales, resultado de no ser escuchados, también pueden frenar el progreso en la mejora de los sistemas de gestión de residuos.
Legislación inadecuada
Cabe destacar, en tercer lugar, que la legislación relacionada con la gestión de residuos, a menudo suele ser inadecuada e ineficaz, en parte debido a definiciones ambiguas y a la falta de coherencia en su aplicación internacio -
ES ESENCIAL
ADOPTEN
ENFOQUE MÁS INCLUSIVO, QUE VALORE Y APROVECHE LAS
DE TODOS LOS ACTORES INVOLUCRADOS
nal. Deficiencias que, no solo dificultan la correcta clasificación y gestión de los residuos, sino que limitan el desarrollo de una economía circular y complican la formulación de políticas uniformes. La falta de un entorno regulador propicio obstaculiza la participación del sector privado en la gestión de residuos, debido a barreras burocráticas o carencia de infraestructuras. Además, la falta de normativa específica sobre la recogida y reciclaje de flujos de residuos, junto con la ausencia de incentivos para el uso de materiales reciclados, inhibe el desarrollo de mercados nacionales de reciclaje. También, la inconsistencia en los sistemas de recopilación de datos entre diferentes actores a lo largo de la cadena de valor
LA FALTA DE UN ENTORNO
REGULADOR PROPICIO Y APLICACIÓN DEFICIENTE DE LA NORMATIVA NO SOLO
DIFICULTAN LA CORRECTA CLASIFICACIÓN Y GESTIÓN DE LOS RESIDUOS, SINO QUE
LIMITAN EL DESARROLLO DE LA ECONOMÍA CIRCULAR
obstaculiza el intercambio de información, limitando aún más la eficiencia en la gestión de residuos.
Por otro lado, la aplicación deficiente de la normativa existente y la insuficiencia de sanciones eficaces fomentan prácticas inadecuadas y corrupción, tanto a nivel nacional como en el comercio internacional de residuos. Además, la privatización de los servicios de gestión de residuos, aunque potencialmente beneficiosa, también corre el riesgo de monopolizarse, favoreciendo a grandes multinacionales y marginando a las empresas locales. Estas deficiencias se ven exacerbadas por la falta de cooperación internacional y por los elevados costos de una gestión adecuada, lo que hace que el comercio global de residuos sea especialmente vulnerable a la corrupción y a la proliferación de traslados ilegales de residuos.
MANTENIMIENTO FÁCIL
COMPACTA
VERSÁTIL
Producing Biogas is easier and faster. Un sistema innovador de pretratamiento de residuos sólidos urbanos en una sola máquina, que permitirá evitar desperdicios y ahorrar espacio, energía y tiempo.



Barreras técnicas
Igualmente han de considerarse las barreras técnicas para la gestión de residuos, que bien pueden ser universales o específicas del contexto en que se aplican. Las barreras universales son comunes en todo el mundo, como por ejemplo, la dificultad para reciclar productos y envases no diseñados para este fin. A pesar de las normativas que exigen el “diseño para el reciclaje”, estos productos continúan dominando los mercados globales. Esto complica el reciclaje y suele resultar en la eliminación de estos materiales en vertederos o su incineración. Además, la recolección de residuos mezclados reduce aún más las posibilidades de recuperación de materiales, ya que la contaminación con residuos orgánicos disminuye la calidad de los reciclables y puede hacer que los residuos sean inútiles para su valorización agrícola o poco atractivos para el reciclaje, lo que exacerba el problema.
Por su parte, las barreras contextuales varían según las condiciones locales, como el clima, la infraestructura y los recursos disponibles. En regiones cálidas, por ejemplo, la gestión de residuos alimentarios requiere recolecciones más frecuentes para evitar problemas de salud pública, lo que incrementa los costos operativos. La falta de infraestructura adecuada, como carreteras en buen estado o estaciones de transferencia de residuos, también puede aumentar los costos de transporte, que ya son uno de los mayores gastos en la gestión de residuos. Además, las tecnologías de gestión de residuos desarrolladas en países de renta alta pueden no ser adecuadas para regiones con diferentes condiciones económicas y sociales, lo que puede resultar en instalaciones ineficientes y costosas.
Por último, las barreras financieras y de mercado constituyen un obstáculo significativo para la transición hacia una economía circular y una gestión eficaz de residuos. Desafíos que se manifiestan principalmente en dos
áreas: la inadecuación de los mecanismos de financiación y la falta de responsabilidad de los contaminadores. A menudo, los mecanismos de financiación para la gestión de residuos son insuficientes o están mal orientados, y el valor de los materiales reciclables no cubre los costos operativos

de los sistemas de gestión, lo que genera una dependencia de la financiación externa. Las barreras para crear mercados sostenibles incluyen el aumento de la generación de residuos, la falta de disposición a pagar por servicios de gestión, y la falta de incentivos económicos para una gestión adecua -
da. Además, las condiciones desfavorables de los préstamos y la falta de acceso a capital limitan la capacidad de los municipios para invertir en infraestructura de gestión de residuos.
Además, el principio de “quien contamina paga” no siempre se aplica efectivamente, lo que provoca que las

Y ESTRATEGIAS PARA EL CAMBIO
FINANCIACIÓN PARA LA GESTIÓN DE RESIDUOS SON INSUFICIENTES O ESTÁN MAL ORIENTADOS, Y EL VALOR DE LOS MATERIALES RECICLABLES NO CUBRE LOS COSTOS
OPERATIVOS DE LOS SISTEMAS DE GESTIÓN, LO QUE GENERA
UNA DEPENDENCIA DE LA FINANCIACIÓN EXTERNA
externalidades negativas de una mala gestión de residuos recaigan sobre la sociedad en general, especialmente sobre las comunidades más vulnerables. Aunque existen instrumentos como impuestos a los envases de plástico o sistemas de Responsabilidad Ampliada del Productor (RAP), estos a menudo no logran incentivar adecuadamente la reducción de residuos ni internalizar los costos ambientales. Los sistemas de RAP, en particular, han sido eficaces en algunos aspectos, pero insuficientes para reducir la generación de residuos. Además, las diferencias en las normativas internacionales complican la aplicación uniforme de estos principios. Las iniciativas voluntarias, como los créditos de plástico y compromisos globales, también han mostrado avances limitados y riesgos de ser utilizados para “greenwashing”.
ESTRATEGIAS PARA EL CAMBIO
Una vez identificados los principales impedimentos para el cambio en el actual modelo de gestión de residuos, resulta crucial explorar soluciones y estrategias efectivas para superar estos desafíos, mitigar los impactos negativos
LA CARENCIA DE DATOS PRECISOS Y COHERENTES SOBRE LA GENERACIÓN Y EL IMPACTO DE LOS RESIDUOS, ASÍ
LA IMPLEMENTACIÓN DE POLÍTICAS EFECTIVAS
y facilitar la transición hacia prácticas más sostenibles y responsables.
Priorizar los residuos
El primer paso para abordar eficazmente la crisis global de los residuos es otorgar al problema la importancia que le corresponde. Para ello, es fundamental que los líderes políticos prioricen la reducción y la gestión de los residuos. Este proceso debe iniciarse con la recopilación y utilización de datos fiables, así como con el despliegue de tecnologías digitales que fortalezcan la cadena de valor de los residuos.
Actualmente, la carencia de datos precisos y coherentes sobre la generación y el impacto de los residuos, así como la falta de metodologías uniformes a nivel nacional, obstaculiza la implementación de políticas efectivas. En este sentido, establecer un enfoque unificado, como la creación de un Observatorio Mundial de Residuos, permitiría una mejor comprensión del problema y facilitaría la planificación de infraestructuras y servicios adecuados. La recopilación de datos no solo apoya la toma de decisiones informadas, sino que también refuerza la gobernanza y financiación adecuada, y promueve la inclusión de todas las voces afectadas por la gestión de residuos.
Por otro lado, la transición digital del sector residuos es clave para garantizar transparencia y fiabilidad, prevenir la contaminación, proteger las operaciones de reciclaje de riesgos legales y financieros, optimizar procesos como
la recolección y clasificación, o facilitar la formalización de sistemas de gestión de residuos en países con infraestructuras menos desarrolladas, mediante aplicaciones que conectan a recolectores con generadores de residuos. En la actualidad, herramientas como la inteligencia artificial y otras tecnologías permiten predecir la composición de los residuos y mejorar la eficiencia en su manejo, así como apoyar la gestión de residuos urbanos con datos precisos. No obstante, es fundamental que la inclusión digital sea equitativa, evitando que las brechas tecnológicas perpetúen desigualdades.
El segundo eje crucial para lograr un desarrollo sostenible y minimizar el impacto de los residuos es la prevención. Para ello, es primordial adoptar de modelos “cero residuos” o de economía circular, que buscan maximizar el uso de productos y materiales, minimizan la generación de residuos y protegen tanto la salud humana como el medio ambiente. Además, la creciente preocupación por los costes de los residuos está impulsando la explo -
ración de modelos de producción y consumo más sostenibles, incluyendo la prohibición de productos innecesarios y la inversión en reutilización y rellenado. Sin embargo, para lograr un entorno de cero residuos, es vital que todas las partes trabajen conjuntamente en la transformación de los sistemas de suministro de productos y servicios, así como en la reducción de los residuos.
Otro desafío global que atañe a la prevención de residuos es el desperdicio alimentario, representando un tercio de los alimentos globales. Combatir esta pérdida masiva de recursos es, por consiguiente, esencial para reducir la enorme huella ambiental que provocan estos residuos. En este contexto, las campañas de concienciación sobre la gestión de alimentos y residuos en el hogar, junto con la redistribución de alimentos y la educación en cocinas comerciales, pueden reducir significativamente el desperdicio. Además, los residuos alimentarios inevitables pueden aprovecharse de manera sostenible en una bioeconomía circular para producir compost, biocombustibles o utilizarse en industrias como la cosmética y la farmacéutica.
Sin embargo, ningún cambio será factible si no parte, en primera instancia, de las propias personas. El cambio social es esencial para mejorar la gestión de residuos, implementar y mantener prácticas sostenibles. Para ello,
PRIMORDIAL
HACIA UNA GESTIÓN SOSTENIBLE DE LOS RESIDUOS: OBSTÁCULOS Y ESTRATEGIAS PARA EL CAMBIO
LA GESTIÓN DE RESIDUOS
DEBE ABORDAR NO SOLO LOS ASPECTOS TÉCNICOS, SINO
TAMBIÉN LAS REPERCUSIONES SOCIOECONÓMICAS, ASEGURANDO UNA TRANSICIÓN
JUSTA QUE BENEFICIE A TODAS LAS PERSONAS, ESPECIALMENTE A LAS MÁS
VULNERABLES
es pertinente adoptar la “ciencia del comportamiento”, que proporciona herramientas eficaces para promover la participación ciudadana, al hacer más fácil y accesible el “hacer lo correcto”. Las iniciativas exitosas han demostrado que, con mensajes claros y coherentes, y proporcionando la infraestructura adecuada, es posible lograr cambios significativos en los comportamientos individuales y colectivos. Además, para que las iniciativas sean verdaderamente efectivas y equitativas es fundamental garantizar la inclusión y representación de todos los sectores de la sociedad. Esto significa que la gestión de residuos debe abordar no solo los aspectos técnicos, sino también las repercusiones socioeconómicas, asegurando una transición justa que beneficie a todas las personas, especialmente a las más vulnerables. Esto implica incluir a las mujeres en la toma de decisiones y reconocer su papel clave o integrar a los trabajadores informales del sector de la gestión de residuos, entre otros.
Crear capacidad nacional
Por último, desarrollar la capacidad nacional en la gestión de residuos es crucial para enfrentar la escasez
global de profesionales capacitados. Esto requiere una expansión urgente de programas de formación, intercambio de conocimientos y certificación profesional para construir una fuerza laboral cualificada, que impulse mejoras significativas en la gestión de residuos. Para ello, será fundamental fortalecer la infraestructura y la legislación. En este sentido, los gobiernos nacionales juegan un papel crucial, debiendo asegurar la implementación de servicios universales de recolección de residuos, prohibir prácticas nocivas como el vertido o la incineración al aire libre, establecer objetivos claros de reciclaje a nivel municipal o promover la demanda de productos reciclados mediante políticas de contratación pública y exenciones fiscales.
Además, la participación del sector privado, especialmente de las PYMEs, es clave para reducir costes y mejorar la gestión de residuos. Las políticas que reducen los riesgos y fomentan las inversiones pueden crear un entorno empresarial competitivo y propicio, impulsando tanto la eficiencia de recursos como el crecimiento económico. También, la cooperación internacional ofrece valiosas oportunidades para compartir estrategias efectivas y fomentar
LAS POLÍTICAS QUE REDUCEN
LOS RIESGOS Y FOMENTAN LAS INVERSIONES PUEDEN CREAR UN ENTORNO EMPRESARIAL COMPETITIVO Y PROPICIO, IMPULSANDO TANTO LA EFICIENCIA DE RECURSOS COMO EL CRECIMIENTO ECONÓMICO
economías circulares, facilitando un cambio sostenible y equitativo en la gestión de residuos.
CREAR CAPACIDAD NACIONAL PARA LA GESTIÓN DE RESIDUOS REQUERIRÁ DE UNA EXPANSIÓN
URGENTE DE PROGRAMAS DE FORMACIÓN, INTERCAMBIO DE CONOCIMIENTOS Y CERTIFICACIÓN PROFESIONAL PARA CONSTRUIR UNA FUERZA
LABORAL CUALIFICADA
Una vez identificados los obstáculos y propuestas las soluciones, queda evidenciada la importancia de abandonar el modelo lineal de consumo de recursos y adoptar enfoques de economía circular y residuos cero, que mantengan los materiales en uso el mayor tiempo posible, y mejoren la reciclabilidad, combatan los delitos relacionados con residuos y garanticen una transición justa que proteja la seguridad y el bienestar de los trabajadores del sector de residuos. En definitiva, la transición circular es esencial para mitigar el impacto ambiental y asegurar un futuro habitable para las próximas generaciones, que además traerá consigo importantes beneficios socioeconómicos. Sin embargo, se necesita de la colaboración efectiva entre gobiernos, sector privado y sociedad civil. Si bien ya se están percibiendo avances prometedores, es esencial seguir reforzando estos esfuerzos y adaptándolos a los contextos específicos de cada región. “Sin un cambio rápido y a gran escala, la humanidad se enfrentará a cantidades inmanejables de residuos con impactos potencialmente irreversibles sobre la biodiversidad, la salud humana y el cambio climático”, advierte la UNEP.
TECNOLOGÍA I IMABE
En la gestión de residuos, la eficiencia y la durabilidad son esenciales para el éxito. Por ello, el Centro de Tratamiento de Residuos (CTR) de Valladolid ha elegido las prensas de IMABE, empresa líder en soluciones tecnológicas avanzadas para el reciclaje y la gestión de residuos.
Entre los procesos que se llevan a cabo en el CTR Valladolid, instalación gestionada por FCC Medio Ambiente, se incluyen la separación de residuos, el compostaje de materia orgánica, el reciclaje de materiales recuperables y


la generación de energía a partir de residuos no reciclables.
Sus instalaciones, diseñadas para cumplir con los más altos estándares de eficiencia y sostenibilidad, están equipadas con cuatro prensas IMABE: dos prensas H-200/4000 LAT para rechazos, una prensa H-75/1800 ESP LAT para materiales reciclables y una prensa CH-40 para chatarra.
Estas prensas no sólo se destacan por su robustez, sino también por su capacidad de adaptación a las necesidades específicas del centro, de gran tamaño, versátiles y potentes. Con una construcción ideal para soportar las condiciones más exigentes, las máquinas fabricadas por IMABE,
garantizan un rendimiento óptimo durante años de operación continua, avaladas por sus 50 años de experiencia en el sector.
Gracias a la implementación de las prensas IMABE, el CTR de Valladolid logrará aumentar su capacidad de procesamiento, reducir los costos operativos y mejorar la calidad del material reciclado. Además, la facilidad de mantenimiento y la durabilidad de las prensas aseguran una mayor productividad y un retorno de la inversión acelerado.
IMABE www.imabeiberica.com/es

Rental Recycling Technology continua su expansión en el mercado nacional e internacional, consolidándose en poco tiempo como un partner fiable y de calidad. RRT ha sido adjudicatario del concurso público para el suministro

de un trómel eléctrico GREMAC e1 en el vertedero de Huesca, lo que refuerza su presencia y referencias en España.
Además, han suministrado un trómel eléctrico GREMAC e2+ a Agropark en México, una empresa dedicada a la

producción de compost a partir de residuos de invernadero.
Otro hito importante, ha sido la adjudicación del concurso público mediante fondos Next Generation para el suministro de una volteadora eléctrica para la planta de compostaje de Tàrrega. La volteadora eléctrica JT RecTec E530, semiautomática y sin conductor será la primera de este tipo en España. Un avance significativo hacia las emisiones cero, mejor eficiencia y utilización de tecnología limpia en el mundo del compostaje.
Con estos nuevos contratos y la expansión en el mercado mexicano, RRT está bien posicionada para continuar su crecimiento y ofrecer soluciones efectivas y sostenibles a nuestros clientes en todo el mundo.

y oportunidades en la gestión de residuos y economía circular en España: el papel de los sistemas de alerta


ELUIS MEDINA-MONTOYA
DIRECTOR DE PROYECTOS DE LA FUNDACIÓN PARA LA ECONOMÍA CIRCULAR
n los últimos años, la gestión más eficiente de los residuos y la transición hacia una economía circular se han convertido en prioridades fundamentales para la Unión Europea y sus Estados miembros. España, al igual que otros países europeos, se enfrenta a desafíos significativos para cumplir con los ambiciosos objetivos establecidos por la UE para 2030 y 2035. Estos retos no solo representan obligaciones
legales, sino también oportunidades para transformar el modelo económico y ambiental del país.
La situación actual de la gestión de residuos en España presenta un panorama complejo. Recientemente hemos sabido que la Comisión Europea ha abierto expedientes a varios países, incluido España, por no estar cumpliendo los objetivos en materia de gestión de residuos. Este hecho subraya la urgencia de implementar medidas más efec-
tivas y acelerar la transición hacia prácticas más sostenibles.
Entre los principales desafíos se encuentran las bajas tasas de reciclaje en comparación con los objetivos europeos, la excesiva dependencia de los vertederos para la eliminación de residuos, la insuficiente infraestructura para la recogida selectiva, especialmente de biorresiduos y la falta de armonización en las políticas y prácticas entre las diferentes comunidades autónomas.
EN PRIMERA PERSONA
La transición hacia una economía circular en España muestra avances, pero aún queda un largo camino por recorrer. Se ha observado un cierto incremento en la concienciación pública sobre la importancia de la separación de fracciones en origen en nuestros hogares, empresas o establecimientos y el reciclaje y la reducción de residuos, así como el desarrollo de iniciativas innovadoras en sectores clave como el textil, la construcción y la alimentación. Además, hay cada vez un mayor énfasis en el diseño de productos para facilitar su reciclaje y, mejor aún, su reutilización.
Sin embargo, persisten barreras como la falta de incentivos económicos adecuados, la necesidad de mayor inversión en I+D+i para tecnologías de reciclaje, y la necesidad de una coordinación más efectiva entre los diferentes niveles de la administración pública.
A nivel europeo, el Pacto Verde Europeo y el Plan de Acción para la Economía Circular han establecido objetivos
ambiciosos que todos los Estados miembros deben cumplir. Estos incluyen, entre otros, reciclar el 65% de los residuos municipales y el 75% de los residuos de envases para 2030, así como reducir el vertido a un máximo del 10% de los residuos municipales para 2035.
España, en particular, se enfrenta al desafío de alcanzar estos objetivos partiendo de una posición rezagada en comparación con algunos de sus vecinos europeos. Según datos recientes, la tasa de reciclaje de residuos municipales en España ronda el 35%, muy por debajo del objetivo del 50% establecido ya para 2020, si bien si parece estamos cumpliendo objetivos en materia de reciclaje de residuos de envases.
Uno de los retos más apremiantes es la implementación efectiva de la recogida separada de biorresiduos en todo el territorio nacional. Esta fracción, que representa en peso más del 40% de los residuos municipales, tiene un gran potencial para ser reciclada en compost y
biogás, reduciendo significativamente la cantidad de residuos que terminan en vertederos.
Otro desafío importante, efectivamente, es la reducción del depósito de residuos en vertederos. España aún depende en gran medida de esta práctica, que ocupa el último lugar en la jerarquía de gestión de residuos de la UE. La transición hacia métodos de tratamiento más sostenibles requerirá no solo inversiones en infraestructura, sino también cambios en las políticas y en el comportamiento de los consumidores. En este sentido, resulta muy significativo que mientras en las encuestas los ciudadanos responden que más del 85% separan sus residuos en casa por fracciones, la realidad es que sólo en torno al 25% de los residuos domésticos llegan efectivamente separados a las plantas y centros de tratamiento. Algo está fallando, pues el ciudadano sabe qué es lo que debería hacer, pero no lo está haciendo.

ESPAÑA, AL IGUAL QUE OTROS PAÍSES EUROPEOS, SE ENFRENTA A DESAFÍOS SIGNIFICATIVOS PARA CUMPLIR CON LOS AMBICIOSOS
OBJETIVOS ESTABLECIDOS POR LA UE PARA 2030 Y 2035. ESTOS
RETOS NO SOLO REPRESENTAN OBLIGACIONES LEGALES, SINO TAMBIÉN OPORTUNIDADES PARA TRANSFORMAR EL MODELO ECONÓMICO Y AMBIENTAL DEL PAÍS
+ LUIS MEDINA-MONTOYA, FUNDACIÓN PARA LA ECONOMÍA CIRCULAR
ES FUNDAMENTAL TRABAJAR EN LAS POLÍTICAS “AGUAS ARRIBA” DE LA ECONOMÍA CIRCULAR, PROMOVIENDO EL ECODISEÑO, LA DURABILIDAD DE LOS PRODUCTOS Y LOS MODELOS DE NEGOCIO CIRCULARES
En cuanto a las oportunidades, la transición hacia una economía circular ofrece un potencial significativo para la creación de empleos verdes. Según estimaciones de la Comisión Europea, la implementación completa de la legislación vigente en materia de residuos podría crear más de 400.000 empleos en la UE, muchos de los cuales podrían generarse en España.
En este contexto, es crucial incrementar el volumen de residuos gestionados mediante la valorización energética, tanto a través de plantas incineradoras como de la digestión anaeróbica para la producción de biogás o biometano. En ambos aspectos, España está muy por debajo de las ratios de países de nuestro entorno, lo que representa una oportunidad significativa para mejorar la gestión de residuos y contribuir a los objetivos de energías renovables.
Es importante destacar que, en el marco del nuevo paradigma de la Economía Circular, cualquier residuo se considera un fracaso del sistema. Por lo tanto, la mayor parte de los esfuerzos en esta materia deben dirigirse a la prevención en la generación de residuos, más que a su gestión posterior. Es fundamental trabajar en las políticas “aguas arriba” de la economía circular, promoviendo, como decía antes, el ecodiseño, la durabilidad de los productos y los modelos de negocio circulares.
En este sentido, la nueva Ley 7/2022 de residuos y suelos contaminados para la economía circular está jugando un papel fundamental. Entre otras cuestiones, esta ley amplía y refuerza el concepto de la responsabilidad ampliada del productor, la RAP, y su alcance, lo que está suponiendo grandes cambios en las cadenas de producción y suministro de todos los sectores productivos y económicos de nuestro país.
La innovación tecnológica en el tratamiento y valorización de residuos representan sin duda una oportunidad importante. España tiene la posibilidad de convertirse en un líder en el desarrollo de nuevas tecnologías para el reciclaje y la recuperación de materiales, lo que no solo beneficiaría al medio ambiente, sino que también impulsaría la competitividad económica del país.
Además, la mejora en la eficiencia del uso de recursos que conlleva la economía circular puede traducirse en importantes beneficios económicos para las empresas españolas. La Comisión Europea estima que las medidas de eficiencia de recursos podrían suponer un ahorro neto de 600.000 millones de euros para las empresas de la UE.
El desarrollo de mercados sólidos para materiales reciclados es otro ámbito de oportunidad. A medida que aumenta la
demanda de productos sostenibles, las empresas que puedan ofrecer materiales y productos reciclados de alta calidad estarán bien posicionadas para aprovechar estas nuevas oportunidades de mercado. En este contexto de desafíos y oportunidades, herramientas como ANTICIPA, desarrollada por la Fundación para la Economía Circular, emergen como recursos valiosos. Los sistemas de alerta temprana en la gestión de residuos pueden desempeñar un papel crucial al proporcionar diagnósticos continuos y en tiempo real sobre la evolución de políticas y medidas implantadas en materia de prevención y gestión de residuos municipales.
Estas herramientas permiten a las autoridades anticipar resultados y ajustar estrategias para asegurar el cumplimiento de los objetivos europeos. Facilitan la comparación del desempeño entre diferentes regiones, promoviendo la adopción de mejores prácticas. Además, pueden identificar tempranamente desviaciones en el cumplimiento de objetivos, permitiendo acciones correctivas oportunas.
La postura conocida del Ministerio para la Transición Ecológica y el Reto Demográfico subraya la importancia de contar con este tipo de herramientas para monitorear el progreso y facilitar la toma de decisiones informadas en materia de gestión de residuos.
ESPAÑA TIENE LA POSIBILIDAD DE CONVERTIRSE EN UN LÍDER EN EL DESARROLLO DE NUEVAS TECNOLOGÍAS PARA EL RECICLAJE Y LA RECUPERACIÓN DE MATERIALES, LO QUE NO SOLO BENEFICIARÍA AL MEDIO AMBIENTE, SINO QUE TAMBIÉN IMPULSARÍA LA COMPETITIVIDAD ECONÓMICA DEL PAÍS
España se encuentra en un momento crucial en su camino hacia una gestión de residuos más sostenible y una economía verdaderamente circular. Los desafíos son significativos, pero las oportunidades para la innovación, la creación de empleo y la mejora ambiental son igualmente importantes. El éxito en esta transición requerirá un esfuerzo coordinado de todos los actores involucrados, públicos y privados y herramientas como los sistemas de alerta temprana serán fundamentales para proporcionar la información necesaria que guíe este proceso de transformación.
A. Gala, M. Guerrero
URBASER I www.urbaser.com e
El proyecto iCAREPLAST (acrónimo de Integrated catalytic recycling of plastic residues into added-value chemical ), financiado por la Comisión Europea con 7,9 millones de euros a través del programa H2020, dentro de la iniciativa SPIRE, pretende abordar los acuciantes problemas de gestión de residuos plásticos en Europa, aportando una solución innovadora, rentable y eficiente en materia de energía para el reciclado químico y la recuperación de estos residuos, evitando que acaben en vertederos y/o

incineradoras y reduciendo la huella de carbono. La tecnología iCAREPLAST combina procesos de pirólisis, tratamiento catalítico y tecnologías de separación por membranas para transformar los residuos plásticos urbanos en productos químicos valiosos, entre ellos compuestos aromáticos, que son claves para la producción de polímeros de calidad virgen, cerrando de esta manera el ciclo del material. Urbaser ha tenido una participación clave en el desarrollo del proyecto, siendo el socio responsable de la validación de
la tecnología a escala de planta piloto (TRL 7), que se ha llevado a cabo en las instalaciones del Centro de Innovación Tecnológica para el tratamiento de residuos Alfonso Maíllo (CIAM) de Zaragoza. Otro logro importante ha sido el desarrollo de un sistema de oxicombustión, que mejora aún más la sostenibilidad medioambiental del proceso.
En un momento en el que el modelo económico lineal ha demostrado ser

insostenible a largo plazo, el futuro va a estar marcado por sistemas productivos, de consumo y de gestión de residuos que tengan como eje principal los modelos basados en economías circulares. Este nuevo enfoque busca crear un ciclo cerrado de diseño, producción y consumo que minimice la entrada de recursos, la generación de residuos y las emisiones contaminantes. En este panorama, empresas como Urbaser, reconocida recientemente por el Ministerio de Ciencia e Innovación con el Premio Nacional de Innovación en la
categoría de Gran Empresa Innovadora, desempeñan un papel crucial. Dentro de este nuevo enfoque de economía circular, las Administraciones públicas están demandando a las empresas de gestión medioambiental tecnologías para la gestión eficiente y sostenible de los residuos urbanos que actualmente tienen como destino final el vertedero, entre ellos los plásticos posconsumo tipo film, para cumplir con el objetivo de vertido establecido en la Directiva Marco de residuos 2008/98/CE (actualizada re-
cientemente 2018/851/CE) y alcanzar los objetivos del Pacto Verde Europeo en materia de circularidad y neutralidad climática. Como respuesta a esta necesidad y siguiendo los paradigmas de la economía circular, es necesario contar con el reciclado químico, que está en estos momentos comenzando o llegando a sus primeros desarrollos industriales, como una solución complementaria al reciclado mecánico, ya que es capaz de valorizar corrientes de residuos plásticos heterogéneos (p.ej. mezcla de poliolefinas). Además, los materiales fi-
iCAREPLAST ha sido incluida en el CORDIS Results Pack
“Descarbonización, eficiencia energética y circularidad para una Unión Europea climáticamente neutra y sostenible” como una de las investigaciones más relevantes en materia de innovación energética en 2024
nales producidos, en su totalidad o en parte, a partir de nuevos plásticos obtenidos por reciclaje químico son indistinguibles de los producidos a partir de plástico virgen, ya que los procesos de reciclaje químico llegan en algún punto de la cadena de producción a un nivel de circularidad total partiendo de los monómeros fundamentales para producir nuevos plásticos.
Dentro de esta estrategia de economía circular surge el proyecto iCAREPLAST (https://www.icareplast.eu/ index.htm) desarrollado por diferentes organismos de investigación, universidades y empresas europeas, cuyo objetivo principal es proporcionar una alternativa económica y energéticamente eficiente para el reciclado y valorización de los residuos plásticos procedentes de los residuos sólidos urbanos que, debido a sus características, contaminación o su baja cuota de mercado, se envían actualmente a incineración o vertedero, así como reducir su impacto ambiental a través de un método de reciclaje químico avanzado basado en la combinación de las tecnologías de pirólisis, tratamiento catalítico y separación por membranas. Con el objetivo de posicionarse en un lugar preferente dentro de este marco de tecnologías de valorización y ofrecer a sus clientes soluciones sostenibles de gestión de residuos, Urbaser ha participado como socio en el proyecto iCAREPLAST, aportando su amplia experiencia y conocimiento
en soluciones medioambientales para liderar las actividades de demostración a escala de planta piloto (TRL 7). La iniciativa iCAREPLAST ha sido incluida en el CORDIS Results Pack “Descarbonización, eficiencia energética y circularidad para una Unión Europea climáticamente neutra y sostenible” como una de las investigaciones más relevantes en materia de innovación energética en 2024.
SITUACIÓN ACTUAL DE LA GENERACIÓN Y GESTIÓN DE
Actualmente, los materiales plásticos se utilizan para una gran variedad de aplicaciones, sectores y productos de tal forma que se han convertido en una parte esencial de nuestro día a día (Faraca y Astrup, 2019). Como prueba de ello, se puede destacar que la balanza comercial para la industria del plástico en Europa fue de 9,2 billones de euros en 2022 (Plastics Europe, 2023). Sin embargo, las características inherentes a los plásticos que los dotan de propiedades tan interesantes como la durabilidad o la ligereza, los hacen a su vez unos materiales de difícil manejo a la hora de su gestión como residuos (Wong y cols., 2017) lo cual agrava un problema que se está volviendo cada vez más crítico debido al continuo incremento de residuos plásticos. De acuerdo con los últimos datos propor-
cionados por Plastics Europe (2023), la producción de materiales plásticos en 2022 alcanzó los 58,7 millones de toneladas, de las cuales 5,3 (9 %) corresponderían a España (Plastics Europe, 2024). Poniendo la mirada sobre los residuos plásticos, durante 2022 se recolectaron unos 2,9 Mt de residuos plásticos posconsumo si se tiene en cuenta tanto los que se gestionan mediante los sistemas de recogida selectiva como los de residuos mezclados, de los cuales el 38,6 % se deposita en vertedero (Plastics Europe, 2024). Esta forma de eliminación de los residuos choca frontalmente con la jerarquía establecida por la Unión Europea en su Directiva Marco sobre residuos (EU, 2008), en la que el depósito en vertedero es la opción menos deseable para la gestión de residuos debido a los graves impactos medioambientales que genera junto con la evidente pérdida de recursos. En este sentido, las políticas impulsadas desde la Unión Europea tratan de transformar el sistema económico europeo dirigiéndolo hacia modelos más circulares a través de la adopción de nuevas directivas, cuyo objetivo es conseguir que en 2035 la cantidad de residuos depositada en vertederos esté por debajo del 10 % (EU, 2018).
Según datos internos de Urbaser, los polímeros más abundantes en los residuos sólidos urbanos (RSUs) son los de tipo poliolefínico: polietileno de baja densidad (PEBD), polietileno de alta densidad (PEAD), polipropileno (PP) y polietileno de baja densidad lineal (PEADL). Entre todos, constituyen un 67 % del total de residuos plásticos recogidos. Los otros polímeros mayoritarios, que representan un 28,9 % del total incluyen el poliestireno (PS), el policloruro de vinilo (PVC) y el tereftalato de polietileno (PET). Actualmente, la principal alternativa para reciclar este tipo de residuos es el reciclado mecánico (Ragaert y cols.,
2017). Sin embargo, este tipo de reciclaje está ampliamente implantado únicamente para dos tipos de plásticos: el PEAD y el PET. Cualquier otro tipo de residuos plásticos procedentes de RSUs suscita grandes dudas frente a procesos de reciclado mecánico ya sea por la falta de cantidad (estabilidad de la alimentación) o por la gran contaminación que presentan los flujos de estas corrientes (gran heterogeneidad e impropios). Por lo tanto, es esencial considerar el desarrollo de nuevas e innovadoras tecnologías como las que apuestan por el reciclado químico como métodos complementarios al reciclado mecánico, en consonancia con la estrategia propuesta por la Comisión Euro -
PROYECTO ICAREPLAST. UNA APUESTA
pea y, especialmente, para el PEBD y el PEBDL, que son los componentes mayoritarios en la cadena de suministro de packaging y que suponen la mayor fracción de los residuos plásticos que todavía se depositan en vertedero (Dahlbo y cols., 2018).
Entre las diferentes tecnologías que apuestan por el reciclaje químico de los residuos plásticos, la pirólisis es una de las más prometedoras, ya que permite transformar directamente los residuos plásticos en sustancias de interés para la industria petroquímica (Khoo, 2019). En este sentido, las compañías petroquímicas líderes del sector están mostrando cada vez más interés por este tipo de productos, ya que les permitirán en el futuro llegar
a producir lo que se denomina “poliolefinas circulares”, ya que su origen reside en los residuos plásticos (BASF, 2024; NESTE, 2023; REPSOL, 2023) y supone un claro ejemplo de circularidad en este nuevo enfoque de los sistemas productivos.
El proyecto iCAREPLAST, financiado con fondos europeos, aborda el reciclaje rentable y energéticamente eficiente de una gran fracción de los plásticos no reciclables y películas multicapa actuales con el objetivo de mejorar la circularidad de la industria del plástico. De este modo contribuye a la eficiencia global de esta industria,



Reciclaje de plástico

Compuestos al final de su vida útil

Residuos de envases no reciclados

Plásticos sucios de MSW
Productos químicos de valor añadido
Oxicombustión
Eficiencia energética Sostenibilidad





Fragmentación

Control y Optimización
Inteligencia Artificial
Hidrogenación

Ingeniería del ciclo de vida

tanto en términos de energía como de materias primas. La labor de iCAREPLAST no solo mejora la viabilidad económica del reciclado de plásticos, sino que también reduce la dependencia de los recursos fósiles primarios y apoya los objetivos europeos de reciclado de residuos.
La tecnología iCAREPLAST combina diferentes rutas químicas (pirólisis, etapas catalíticas y de separación) para producir nuevas materias pri-
mas, que podrían ser usadas para la obtención de polímeros de calidad virgen o como material de partida para otros procesos en industrias petroquímicas, de productos químicos finos, automotrices y de detergentes/ surfactantes.
En el centro de las actividades del proyecto se encuentra el diseño, fabricación, instalación y prueba en entorno real, en las instalaciones del Centro de Innovación Tecnológica para el
La tecnología iCAREPLAST combina diferentes rutas químicas (pirólisis, etapas catalíticas y de separación) para producir nuevas materias primas, que podrían ser usadas para la obtención de polímeros de calidad virgen o como material de partida para otros procesos
tratamiento de residuos Alfonso Maíllo (CIAM) de Urbaser en Zaragoza, principalmente de la tecnología de pirólisis y del tratamiento catalítico posterior en una planta piloto con una capacidad de procesamiento de 100 kg/h. Otra línea de actuación fundamental llevada a cabo por Urbaser es el desarrollo de una línea de pretratamiento de residuos plásticos capaz de obtener un material homogéneo en forma de granza y que cumpla las especificaciones de entrada al proceso de pirólisis.
Tras el acondicionamiento del material de partida, la tecnología iCAREPLAST continúa con el proceso de pirólisis. Como resultado del craqueo térmico, se obtiene una fracción líquida de hidrocarburos que es posteriormente sometida a procesos catalíticos de alquilación o aromatización. Finalmente, los productos de interés de alto valor añadido obtenidos (alquilaromáticos y BTX) se recuperan
iCAREPLAST prevé mejorar un 12 % el rendimiento a líquidos de pirólisis, reducir en torno al 45 % las necesidades energéticas, reducir la producción de residuos en un 95 % y reducir las emisiones de efecto invernadero entre el 58 % y el 76 %. En términos económicos, se calcula que el rendimiento económico del proceso de reciclaje aumentaría hasta un 200 %
mediante una tecnología avanzada de separación selectiva de membranas. La fracción gas se somete a un proceso de oxicombustión utilizando una novedosa pila de combustible basada en células de óxido sólido con el fin de llevar a cabo una combustión altamente eficiente desde el punto de vista energético, generando únicamente CO ² (que es capturado y posteriormente valorizado) y agua, llevando a cabo todo el proceso en un contexto de eficiencia energética y respeto al medio ambiente. La fracción restante, sólido carbonoso o char, puede ser vendida como producto de interés en otros sectores. Para asegurar la sostenibilidad de todo el proceso, la tecnología iCAREPLAST cuenta con un sistema de control avanzado con el objetivo de armonizar los objetivos económicos y ambientales, haciendo uso de indicadores significativos definidos teniendo en cuenta los análisis de LCA (evaluación del ciclo de vida) y LCC (coste del ciclo de vida). Los resultados obtenidos durante el desarrollo y ejecución del proyecto iCAREPLAST han sido positivos y han permitido validar la escalabilidad y viabilidad de las tecnologías desarrolladas por los diferentes socios del proyecto, así como la estabilidad del proceso y la calidad del producto final obtenido. iCAREPLAST prevé mejorar un 12 % el rendimiento a líquidos de pirólisis, reducir en torno al 45 % las necesidades energéticas, reducir la producción de residuos en un 95 % y reducir las
emisiones de efecto invernadero entre el 58 % y el 76 %, lo que implicaría llegar a niveles inferiores a cero neto si se tiene en cuenta la sustitución de productos secundarios. En términos económicos, se calcula que el rendimiento económico del proceso de reciclaje aumentaría hasta un 200 %.
Para poder ofrecer esta solución de gestión sostenible a los clientes, queda pendiente, por un lado, completar el desarrollo de la tecnología iCAREPLAST (pasar de TRL 7 a TRL 9) mediante la construcción de la primera planta demo para poder demostrar su viabilidad técnico-económica antes de alcanzar su pleno potencial a nivel industrial y, por otro lado, estudiar e implementar modificaciones en las plantas de tratamiento de RSUs encaminadas a garantizar la disponibilidad de esta materia prima (balas de plástico film), tanto en cantidad como en calidad. Este último punto es clave, junto con la necesidad de un marco regulatorio estable y predecible, para que el reciclado químico sea una realidad a escala industrial. Asegurar la circularidad de los plásticos es necesario para alcanzar las tasas de reciclado marcadas por la Unión Europea.
BASF, 2024. BASF to Incorporate Chemical Plastic Recycling Process in U.S. Manufacturing - Environment+Energy Leader Faraca, G., Astrup, T., 2019. Plastic waste from recycling centres: Characterization and evaluation of
plastic recyclability. Waste Manage. 95, 388 – 398. https://doi.org/10.1016/j.wasman.2019.06.038
Dahlbo, H., Poliakova, V., Mylläri, V., Sahimaa, O., Anderson, R., 2018. Recycling potential of post-consumer plastic packaging waste in Finland. Waste Manage. 71, 52-61. https://doi.org/10.1016/j.wasman.2017.10.033
NESTE, 2023. Neste decides to invest in liquefied waste plastic upgrading unit at its Porvoo refinery
Plastics Europe, 2023. Plastics –the fast Facts 2023.https://plasticseurope.org/wp-content/ uploads/2023/10/Plasticsthefastfacts2023-1.pdf
Plastics Europe, 2024. National infographics: Circular Economy for Plastics 2024. https://plasticseurope.org/wp-content/ uploads/2024/05/CircularEconomy_nationalinfographics_2024.pdf
Wong S.L., Ngadi N., Abdullah T.A.T., Inuwa I.M., 2017. Current state and future prospects of plastic waste as source of fuel: A review. Renew. Sustain. Energy. Rev. 50, 1167–1180. https://doi. org/10.1016/j.rser.2015.04.063
EU, 2008. Directive 2008/98/EC of the European Parliament and of the Council of 19 November 2008 on waste and repealing certain directives.
https://eur-lex.europa.eu/eli/dir/2008/98/oj EU, 2018. Directive (EU) 2018/850 of the European Parliament and of the Council of 30 May 2018 amending Directive 1999/31/EC on the landfill of waste (Text with EEA relevance) https:// eur-lex.europa.eu/legal-content/es/TXT/?uri=CELEX%3A32018L0850
Ragaert, K., Delva, L., Van Geem, K., 2017. Mechanical and chemical recycling of solid plastic waste. Waste Manage. 69, 24-58.
https://doi.org/10.1016/j.wasman.2017.07.044
REPSOL, 2023. Plastics2Olefins project: Recycling plastic waste into high-value materials (innovationnewsnetwork.com)

Uno de los pasos más firmes de BURÉS PROFESIONAL S.A. en respuesta a la creciente sensibilidad colectiva hacia el respeto al medio ambiente se produce en 1996 con la puesta en marcha de su sección de reciclado de restos vegetales de poda, VERD RECYCLING.
VERD RECYCLING se especializa en la valorización de restos de poda. Los residuos son triturados, clasificados y mezclados (dos trituradoras primarias y dos trituradoras secundarias, así como 4 trommels repartidas en las plantas de Girona y Barcelona y que permiten realizar una clasificación en
diferentes volumetrías), asegurando una correcta aireación y humedad para promover la actividad microbiana necesaria para su descomposición.
El proceso de compostaje de VERD RECYCLING se caracteriza por su eficiencia y sostenibilidad. El uso de tecnología avanzada para monitorear y controlar las condiciones del compost garantiza un producto final de alta calidad.
El compromiso de VERD RECYCLING con el medio ambiente va más allá de la producción de abonos orgánicos. La empresa también se enfoca en la educación ambiental, promoviendo
prácticas de jardinería sostenible y la importancia de residuos verdes entre las comunidades locales.
VERD RECYCLING no solo ofrece una solución eficiente para la gestión de residuos de poda, sino que también contribuye significativamente a la agricultura sostenible. El enfoque innovador y el compromiso con el medio ambiente posiciona la empresa como modelo en el sector de la valorización de restos de poda.
Recientemente ha surgido un gran interés en diversificar y aumentar el empleo de caucho reciclado procedente del neumático al final de su vida útil. En este sentido, la utilización de caucho de neumáticos en productos de aplicación en entornos urbanos se presenta como una alternativa sostenible y ventajosa. Por otro lado, existe un compromiso de las ciudades con la Economía Circular, materializado ini -
cialmente en el “Pacto Global de los Alcaldes sobre el Clima y la Energía (GCoM)” y el “llamamiento a las ciudades por una Economía Circular” firmado en 2015 en París. Ambas fueron las primeras iniciativas internacionales donde las autoridades locales asumieron un compromiso a favor de la Economía Circular.
El neumático, que durante años ha rodado por las ciudades, cuando llega al final de su vida útil se transforma


en materiales reciclados que pueden incorporarse en los entornos urbanos contribuyendo a la economía circular. Para dar a conocer los diferentes usos que tienen los materiales reciclados procedentes del neumático en los entornos urbanos Signus ha editado una completa Guía. Dicho documento, dirigido principalmente a los ayuntamientos, está concebido para que sea una herramienta de ayuda para dar cumplimiento a su compromiso por la economía circular en las ciudades. A lo largo de la Guía se presenta información detallada sobre las diferentes aplicaciones de caucho en ciudades, con características y ventajas generales del caucho reciclado, productos y soluciones de diversa aplicación en entornos urbanos y ejemplos gráficos.
EN PRIMERA PERSONA

LCORALÍA PINO
RESPONSABLE DEL ÁREA DE SOSTENIBILIDAD Y EFICIENCIA ENERGÉTICA DEL INSTITUTO TECNOLÓGICO HOTELERO (ITH)
a transición hacia una economía circular es un desafío ineludible para sectores con una alta huella ambiental, como el hotelero. Los hoteles, en su búsqueda por reducir el impacto medioambiental, están integrando principios de la economía circular en sus operaciones, centrados en disminuir el desperdicio alimentario, mejorar la gestión de residuos y fomentar el reciclaje. Este cambio no solo responde a las demandas de sostenibilidad de los consumidores, sino que también impulsa la eficiencia operativa y la rentabilidad a largo plazo.
EL DESAFÍO DEL DESPERDICIO
ALIMENTARIO: UN PROBLEMA
GLOBAL CON SOLUCIONES LOCALES
El desperdicio alimentario es uno de los problemas más graves del sector hotelero. La Organización de las Naciones Unidas para la Alimentación y la Agricultura (FAO) estima que un tercio de los alimentos producidos en el mundo se pierde o se desperdicia. En los hoteles, esto representa una pérdida económica considerable y un impacto ambiental significativo.

Para abordar este problema, muchos hoteles han adoptado tecnologías avanzadas que monitorizan y reducen el desperdicio alimentario. Sistemas que utilizan inteligencia artificial analizan los residuos en tiempo real, identificando patrones de desperdicio y proporcionando datos para ajustar compras y menús. Esta tecnología ayuda a los chefs y gerentes a tomar decisiones más informadas, reduciendo el desperdicio en un promedio del 40-70%, lo que mejora la sostenibilidad y genera ahorros significativos.
+ CORALÍA PINO, ITH

CIRCULAR EN SUS OPERACIONES NO SOLO PARA DAR RESPUESTA A LAS DEMANDAS DE SOSTENIBILIDAD, SINO QUE TAMBIÉN IMPULSA
LA EFICIENCIA OPERATIVA Y LA RENTABILIDAD A LARGO PLAZO
Además de la tecnología de monitoreo, los hoteles están implementando prácticas como el menú a la carta, que permite prever mejor la demanda y reducir la producción innecesaria de alimentos. También están adoptando estrategias de gestión de inventarios inteligentes, asegurando que los ingre-
dientes se utilicen antes de que caduquen, minimizando las pérdidas. Otra medida importante es la colaboración con organizaciones benéficas para redistribuir el exceso de alimentos, lo que reduce el desperdicio y fortalece la responsabilidad social corporativa de los hoteles. Estas prácticas se recogen en el “Estudio de buenas prácticas para prevenir y reducir las pérdidas y el desperdicio alimentario (pda) en los hoteles”, realizado por el ITH el año pasado y subvencionado por la Secretaría de Estado de Turismo.
EN PRIMERA PERSONA
RECICLAJE:
HACIA UNA
OPERACIÓN SIN RESIDUOS
La gestión de residuos es crucial en la economía circular, y el sector hotelero no es la excepción. Los hoteles generan una amplia gama de residuos, desde plásticos y papel hasta residuos orgánicos y productos de un solo uso, que requieren una gestión eficiente y sostenible.
La implementación de programas de reciclaje integrales es una de las primeras medidas adoptadas por muchos hoteles. Estos programas incluyen la separación de residuos en la fuente, con contenedores de reciclaje en habitaciones y áreas comunes, y la colaboración con empresas especializadas en el reciclaje. Sin embargo, el reciclaje es solo un componente de la estrategia más amplia de gestión de residuos.
Para avanzar hacia una operación sin residuos, algunos hoteles están adoptando tecnologías como los compactadores de residuos y los digestores
CIRCULAR NO SE LIMITA SOLO A LA
RESIDUOS Y LA REDUCCIÓN DEL
DESPERDICIO ALIMENTARIO.
TAMBIÉN IMPLICA UN REDISEÑO COMPLETO DE LAS
OPERACIONES HOTELERAS PARA
anaeróbicos. Los compactadores reducen significativamente el volumen de residuos, disminuyendo la frecuencia de las recolecciones y los costos asociados. Por otro lado, los digestores anaeróbicos convierten los residuos orgánicos en biogás y fertilizantes, ce-
rrando el ciclo de los materiales y proporcionando una fuente de energía renovable que puede ser utilizada en las instalaciones del hotel.
DISEÑO Y OPERACIONES
SOSTENIBLES: MÁS ALLÁ DEL RECICLAJE
El enfoque en la economía circular no se limita solo a la gestión de residuos y la reducción del desperdicio alimentario. También implica un rediseño completo de las operaciones hoteleras para hacerlas más sostenibles, comenzando con la construcción de los hoteles. El uso de materiales reciclados y sostenibles es clave, desde el mobiliario hasta los materiales de construcción, eligiendo productos que pueden ser reutilizados o reciclados al final de su vida útil.
El diseño sostenible también incluye la implementación de tecnologías para la eficiencia energética y la gestión del agua, como los sistemas de recolección de agua de lluvia y depuración de aguas

grises, paneles solares y aerotermia. Estas tecnologías no solo reducen la dependencia de recursos no renovables, sino que también contribuyen a la reducción de los costos operativos a largo plazo. En el día a día, los hoteles están adoptando prácticas como la eliminación de productos de un solo uso, sustituyendo botellas de plástico y envases de amenidades por alternativas reutilizables o biodegradables. Asimismo, la implementación de tecnologías de gestión de la energía basadas en IoT (Internet de las Cosas) permite a los hoteles monitorear y optimizar el uso de la energía en tiempo real, reduciendo el desperdicio y mejorando la eficiencia.
INNOVACIÓN Y COLABORACIÓN:
CLAVES PARA EL ÉXITO
La transformación hacia una economía circular en el sector hotelero no es un proceso que pueda lograrse de forma aislada. Requiere la colaboración entre diversos actores, incluyendo proveedores, empleados, huéspedes y comunidades locales. Los hoteles que lideran esta transición están forjando alianzas estratégicas con empresas tecnológicas, organizaciones no gubernamentales y gobiernos locales para desarrollar e implementar soluciones innovadoras. Un ejemplo de esta colaboración es la asociación entre cadenas hoteleras y startups tecnológicas para desarrollar aplicaciones de gestión de residuos, que permiten a los hoteles rastrear su producción de residuos y encontrar las mejores soluciones para reducirla. Estas aplicaciones no solo facilitan el
FUNDAMENTALES, EL SECTOR HOTELERO TIENE LA OPORTUNIDAD
RESPONSABLE Y RESILIENTE, DONDE EL DESPERDICIO SE
CONVIERTE EN UN RECURSO EN POTENCIA + CORALÍA PINO, ITH
cumplimiento de las normativas locales sobre residuos, sino que también permiten a los hoteles medir y reportar sus avances en sostenibilidad de manera más efectiva.
En este sentido, el Instituto Tecnológico hotelero (ITH) realizó hace dos años un Estudio de Viabilidad Técnica del proyecto “Smart gastro cycle 4.0 (For) hotels - IoT for no Food Waste”, que propone dotar de Inteligencia Artificial, el Internet de las Cosas y las herramientas digitales disponibles en el mercado para facilitar la creación de una economía circular en la cadena de generación, transformación y distribución de la alimentación en el sector hotelero, con el objetivo de minimizar el desperdicio alimenticio maximizando su reutilización. El objetivo final de este estudio fue plantear la viabilidad de la implantación de un proyecto para dotar a los hoteles de las herramientas y procesos tecnológicos necesarios para garantizar una progresiva reducción del desperdicio alimenticio, una distribución del excedente entre entidades sociales locales y un correcto reciclado y compostado. El estudio se llevó a cabo con la colaboración de Garden Hoteles, que ya ha implemen-
LOS HOTELES QUE LIDERAN ESTA TRANSICIÓN ESTÁN FORJANDO ALIANZAS ESTRATÉGICAS CON EMPRESAS TECNOLÓGICAS, ORGANIZACIONES NO GUBERNAMENTALES Y GOBIERNOS LOCALES PARA DESARROLLAR E IMPLEMENTAR SOLUCIONES INNOVADORAS
tado en sus procesos algunas de las tecnologías propuestas como viables en dicho estudio.
CONCLUSIÓN: EL FUTURO CIRCULAR DEL SECTOR HOTELERO
El sector hotelero está en un punto de inflexión, donde la adopción de los principios de la economía circular no es solo una opción, sino una necesidad. Los avances en tecnología y las estrategias innovadoras están permitiendo a los hoteles reducir significativamente su desperdicio alimentario, gestionar sus residuos de manera más eficiente, fomentar el reciclaje y reducir el consumo de energía y sus correspondientes emisiones de carbono. Estos esfuerzos no solo contribuyen a la preservación del medio ambiente, sino que también generan un valor añadido al negocio al mejorar la eficiencia operativa.
Sin embargo, el camino hacia una economía circular es continuo y requiere un compromiso constante. La adopción de nuevas tecnologías y la implementación de prácticas sostenibles deben ser vistas como inversiones en el futuro, no solo como respuestas a las demandas actuales. Con la colaboración y la innovación como pilares fundamentales, el sector hotelero tiene la oportunidad de liderar el cambio hacia un modelo económico más responsable y resiliente, donde el desperdicio se convierte en un recurso en potencia y cada acción cuenta para crear un impacto positivo en el planeta.

REPORTAJE
e Iván Contreras, Eduardo Ordóñez C. Grupo VICAL
Grupo VICAL, compañía propietaria de las instalaciones, inició su actividad productiva en 1964 en Guatemala convirtiéndose en una de las principales fábricas de envases de vidrio de Centroamérica. En 1978, gracias al incremento de la demanda de este producto se agrega la segunda planta de producción en Costa Rica.
Actualmente el grupo cuenta con esas dos plantas de producción con 3 hornos en Guatemala y 1 horno en Costa Rica, con 11 líneas de producción en las dos plantas, que cuentan con una capacidad total diaria de alrededor de 900 toneladas métricas. Estas plantas son operadas por más de 1.500 colaboradores totalmente capacitados para el efecto y con una actitud 100% orientada al servicio y a resultados.
La producción actual de vidrio cristalino se realiza principalmente en Guatemala con 8 líneas de producción y un alimentador de coloreado en línea, y la producción de colores (ámbar y verde esmeralda) se realiza básicamente en Costa Rica con 3 líneas de producción.
Las instalaciones de Grupo VICAL cuentan con una inmejorable posición geográfica, estando ubicadas estratégicamente en el norte y sur de Centroamérica, atendiendo dentro de su mercado geográfico natural y en el extranjero a alrededor de 200 clientes en más de 20 países. Actualmente se suministra envases para la industria alimentaria, farmacéutica, cervecera, refrescos y licores, bajo sistemas y certificaciones de calidad e inocuidad alimentaria que aseguran estas características tan importantes.


El vidrio es un material permanente, 100% reciclable infinitamente. Por estas características el vidrio permite que su reciclaje sea un proceso extraordinariamente eficiente que permite aprovechar la totalidad del material recuperado mediante un proceso de fundición simple. Reciclar vidrio es muy importante para el medio ambiente, ya que permite un ingente ahorro de energía, emisiones, materias primas y desechos.
Uno de los objetivos operativos de Grupo VICAL es el de incrementar constantemente el contenido de material reciclado en fórmula, por lo que
tener más y mejor vidrio posconsumo se ha convertido en una búsqueda constante de la organización.
Gracias a esto se han desarrollado más de 1000 centros de acopio en toda la región centroamericana y el Caribe que proveen de este vidrio para ser reciclado a las 2 plantas de Grupo VICAL en Guatemala y Costa Rica.
Esta organización, apegada a los principios de innovación, cree e implementa constantemente los más recientes avances técnicos disponibles para permanecer a la vanguardia dentro de su segmento. En ese sentido, Grupo VICAL decide invertir en una planta de lavado y clasificación automatizada de vidrio que le permite hacer esta labor de una forma más rápida y eficiente. Es así como a partir del 15 de abril inicia operaciones esta nueva planta que permite acondicionar el vidrio para ser introducido en la fórmula de los nuevos envases.
Esta planta de reciclaje de vidrio posconsumo, fue diseñada por la em-


presa PICVISA, basada en Barcelona, España. Siendo ellos mismos quienes dirigieron tanto la ingeniería como la fabricación de los equipos, supervisión del montaje y comisionamiento, junto con el departamento de Ingeniería de planta de Grupo VICAL y contratistas locales y extranjeros. La construcción y puesta en marcha de este equipo único en la región tardó 4 meses y finalizó en Marzo, y en ella intervinieron más de 50 personas. Esta nueva instalación es capaz de eliminar contaminantes metálicos ferrosos y no ferrosos, plásticos, piedras, cerámica, acondiciona el tamaño de los fragmentos de vidrio y clasificar el vidrio de acuerdo con su color, todo de forma automática. Todo esto en una banda sin fin que permitió incrementar la eficiencia del proceso acondicionamiento de vidrio posconsumo del 85% a un 99%, convirtiéndolo en una materia prima para la producción de nuevos envases. Actualmente cuenta con una capacidad de procesamiento de 15 toneladas por hora, capacitada para trabajar 24 horas y puede ampliar su capacidad hasta 25 tonela -
das/hora, en el momento que la producción lo requiera.
El vidrio recolectado en Centroamérica representa poco más del 50% del material que se utiliza para producir nuevos envases en las plantas de Grupo VICAL. Y esta nueva planta en Guatemala complementa al equipo ya existente desde hace algunos años en Costa Rica y que hoy están ubicadas estratégicamente en el norte y en el sur de la región, listas para recibir el material posconsumo de toda esta.
• Alimentación: la planta cuenta con una rampa de acceso por la cual un cargador frontal aprovisiona mediante una tolva al sistema de la pedacería de vidrio que en ese punto inicia el proceso de acondicionamiento.
• Separación magnética: el vidrio posconsumo se conduce por bandas hacia las cintas magnéticos las cuales separan los materiales ferrosos liberando al material de este potencial contaminante.
• Cribado: posteriormente el vidrio pasa por un sistema de cribas que cla-




sifica las partículas del mismo en los diferentes tamaños.
• Extracción de ligeros: en este momento por medio de tiro inducido y una campana de extractora que libera el flujo de vidrio de etiquetas, materiales como trozos de maderas, plásticos, etc., que por su peso puedan ser eliminados por este método.
• Separación inductiva: en este sitio por medio de la creación de un arco eléctrico se separan los desechos de aluminio o materiales no ferrosos.
• Molino de rodillos: posteriormente las partículas de mayor tamaño pasan por el molino de rodillos el cual asegura que el tamaño de las mismas sea el ideal que es que cada una de ellas mida entre 6 y 60 mm.
• Separación óptica: este tipo de equipo recibe el flujo de vidrio y por medio de sistema de sensores ópticos e inteligencia artificial así como sistemas neumáticos realizan la separación de los diversos materiales, eliminando piedras contaminantes,
plástico y cerámica que aún persisten dentro del material. Además en esta parte del proceso se clasifica el vidrio por color.
Al finalizar el proceso, el producto terminado, el vidrio ya clasificado
y limpio, es conducido por medio de una banda contínua que lo conduce para hacer la mezcla con materias primas y obtener la fórmula correcta para así poder elaborar nuevas botellas de vidrio.
Este impresionante equipo es manejado por 2 operarios que fueron capacitados por técnicos españoles para así poder migrar a esta nueva tecnología con la menor cantidad de dificultades posibles.
Es importante indicar que el proyecto incluyó el edificio u obra civil que lo alberga, la cual se diseñó de tal forma que quedaron habilitados accesos y divisiones que cuentan con los espacios para los mantenimientos necesarios, los procesos de orden y limpieza, asi como para poder retirar los materiales de desecho producto del proceso de limpieza del material.
Gracias a la puesta en marcha de esta planta, Grupo VICAL avanza en su meta de incrementar cada año la cantidad de vidrio posconsumo que llegan a sus hornos y continuar operando obteniendo cada día más y mejor vidrio, con una operación cada vez más sostenible.



e Nuria Suárez

LA IMPARABLE OLA DE CIRCULARIDAD QUE SE
EXPANDE POR EUROPA EN ESTOS MOMENTOS
NO HACE SINO CRECER Y CADA VEZ ABARCA
MÁS ÁMBITOS. TAL ES EL CASO DE LA CONSTRUCCIÓN, UN SECTOR CON ALTA CAPACIDAD DE ADAPTACIÓN QUE EN LOS ÚLTIMOS AÑOS HA PASADO DE CENTRARSE CASI EN EXCLUSIVA EN LA OBRA FINAL PARA ATENDER A CRITERIOS
VANGUARDISTAS COMO EL DISEÑO CIRCULAR, EL ANÁLISIS DEL CICLO DE VIDA, LA MEDICIÓN DEL CONSUMO ENERGÉTICO O LA INCORPORACIÓN DE MATERIAS PRIMAS SECUNDARIAS. ES EN ESTE ÚLTIMO ASPECTO SOBRE EL QUE NOS CENTRAMOS EN ESTE REPORTAJE, DONDE ABORDAMOS DE LA MANO DE TRES GRANDES EXPERTOS EL ENORME POTENCIAL QUE POSEEN LA CORRECTA GESTIÓN Y RECICLAJE DE LOS RESIDUOS DE CONSTRUCCIÓN Y DEMOLICIÓN (RCD) EN EL CAMINO HACIA UN CONTINENTE EUROPEO DESCARBONIZADO.
El cuidado de los aspectos ambientales siempre es rentable en cualquier sector, no solo desde el punto de vista económico, sino también contemplado como pilar básico obligatorio dentro de las políticas de responsabilidad social de las empresas. En materia de áridos reciclados, la importancia de hacer extensiva su reutilización y reciclaje radica en los nume-
rosos beneficios que lleva atribuidos y que no se limitan únicamente al terreno constructivo. Para conocer de primera mano las oportunidades que se abren en este incipiente campo y examinar las barreras y desarrollos normativos que llevan atribuidos los residuos de construcción y demolición (RCD), contamos con la visión experta de Laura Silva, Jefa de proyectos en el Instituto de Tecnología de la Construcción (ITeC), Pablo Pérez, Director Técnico Grupo de Interés
Áridos Reciclados de RCD y Rita Martinez, Responsable Economía Circular de la Asociación Nacional de Empresarios Fabricantes de Áridos (ANEFA).
En los últimos años una confluencia de factores ha hecho crecer el interés por la gestión sostenible de los residuos de construcción y demolición, entre los que encontramos una mayor conciencia ambiental, tanto social como del propio sector de la construcción; el agotamiento cada vez más acelerado de los recursos naturales; una legislación reciente centrada en promover la economía circular; el incremento de los costos a la eliminación de residuos y la demanda creciente de certificaciones que acrediten la sostenibilidad de los procesos.
Desde ANEFA argumentan que el sector de los áridos lleva más de 30 años promoviendo los áridos reciclados, pero han sido los últimos instrumentos normativos de la Comisión Europea los que han comportado un significativo empujón para impulsar la gestión sostenible de los RCD. “En particular, desde el prisma del adecuado reciclado de estos materiales para su uso como materias primas secundarias en las nuevas obras de construcción. El sector de la construcción es considerado como prioritario por la Comisión Europea en el marco del Plan de Acción de Economía Circular y todas las políticas para desvincular el crecimiento económico de la utilización de materas primas naturales están muy reforzadas en el marco del Pacto Verde Europeo”. Rita Martinez asegura que la clave del éxito de la utilización generalizada de los materiales reciclados en obra radica en “una normativa estandarizada de referencia a aplicar para cada uso, adecuado al nivel de riesgo de la operación, así como un buen diseño constructivo y una red de suministradores adecuadas y suficientes que garantice su disponibilidad”.

Con buena planificación, la gestión de RCD deriva en ahorros económicos y ambientales, aumentando la rentabilidad empresarial al evitar costes de depósito en vertedero y materias primas.
Rita Martinez, Responsable
Economía Circular de la Asociación Nacional de Empresarios Fabricantes de Áridos (ANEFA).
En la actualidad, el principal reto que enfrenta el mundo de la construcción es cumplir los principios de la economía circular, lo cual pasa, en palabras de Pablo Pérez por la sustitución de áridos procedentes del sector extractivo por materias primas secundarias. “No tenía sentido, ni lo tiene en la actualidad, que un recurso tan valioso como los RCD se estuvieran eliminando, en el mejor de los casos, en escombreras controladas. Para los RCD es de aplicación la misma normativa que para cualquier otro residuo, lo que implica la aplicación de criterios de prevención y reutilización y la obligación de su entrega para ser reciclados a un gestor autorizado en plantas de reciclaje de residuos de construcción y demolición. Además, no podemos olvidar los cambios que se están produciendo en el marco legislativo, especialmente lo derivado de la entrada en vigor de normativa europea de obligada transposición, pues contribuirá en mayor medida a operar un cambio relevante en las normativas nacionales y autonómicas al establecer la reintroducción al mercado de materias primas secundarias”.
Algunas estadísticas cifran en cerca de un 50% el consumo por parte del sector de la construcción de los materiales que se extraen, lo que comporta un impacto muy elevado sobre el territorio y la biodiversidad; ya que a su vez es responsable del 30% de los residuos generados, lo que acrecienta la necesidad de alternativas sostenibles, como el uso de áridos reciclados. En este sentido, Laura Silva sostiene que “la sociedad en general y el sector de la construcción en particular son cada vez más conscientes de los impactos ambientales negativos de una gestión inadecuada de los RCD. Es por ello que la implementación de leyes y regulaciones más estrictas que promueven la gestión sostenible de los RCD y la economía circular están impulsando su adopción en la industria”.
La experta enumera entre los principales beneficios que presentan los RCD su capacidad de evitar los costos asociados al transporte y disposición en vertederos, así como la necesidad

Las empresas constructoras que adoptan prácticas de economía circular pueden mejorar su imagen corporativa, aumentar su competitividad y atraer a clientes más conscientes del medio ambiente.
Laura Silva, Jefa de proyectos en el Instituto de Tecnología de la Construcción (ITeC).
de extraer y procesar materiales vírgenes, lo que genera ahorros en costos de materiales y contribuye al cumplimiento de los Objetivos de Desarrollo Sostenible (ODS). Además, Silva explica que se generan nuevos puestos de trabajo para las labores de recolección, procesamiento y comercialización de materiales reciclados, a parte de mejorar la competitividad de aquellas empresas constructoras que implementen prácticas de gestión sostenible de RCD.
¿AVANZAMOS HACIA UNA IMPLEMENTACIÓN GENERALIZADA DE RCD?
A pesar de existir multitud de instrumentos transversales y generales para impulsar el cambio de modelo económico, los expertos señalan que no hay, salvo en casos excepcionales, herramientas específicas para el sector de la construcción, más allá de las iniciativas voluntarias. Si bien existen infinidad de iniciativas que permitirán avanzar en el cambio de modelo económico en el sector de la construcción, faltaría el mecanismo tractor determinante que supone la aplicación práctica de las políticas de compra pública verde. “La contratación pública supone el 14% del PIB total de la UE, con lo que, cualquier iniciativa mediante la inclusión en los contratos de cláusulas ambientales supondrá un avance crucial. El cambio está próximo. La revisión del Reglamento Europeo (RPC) sobre los productos de construcción será sin duda un detonante importantísimo ya que recogerá el marco necesario para los futuros procedimientos de contratación pública ecológica aplicables a productos de construcción”.
Así, los productos de construcción del futuro requerirán la extracción de una menor cantidad de recursos y generarán menos contaminación y menos residuos, por lo que la edificación se posicionará como eslabón clave en
RECICLADOS RECLAMA QUE LA ADMINISTRACIÓN PÚBLICA
ACTUÉ COMO ELEMENTO
TRACTOR Y APLIQUE CRITERIOS DE COMPRA PÚBLICA VERDE, PREMIANDO EL USO DE MATERIALES RECICLADOS Y FAVORECIENDO EL CONSUMO DE PRODUCTOS DE CONSTRUCCIÓN
RECICLABILIDAD
la lucha contra el cambio climático. Pablo Pérez asegura que la principal barrera es la “costumbre”, así como la falta de regulación. “En numerosas obras se siguen mezclando todos los residuos en un mismo contenedor, lo que dificulta su reciclaje, aludiendo a la falta de espacio o tiempo. Para cambiar estas malas prácticas únicamente es necesario tener voluntad, o un marco normativo adecuado para imponer las obligaciones en caso de falta de esa voluntad. Para los RCD es de aplicación la misma normativa que para cualquier otro residuo, lo que implica la aplicación de criterios de prevención y reutilización y la obligación de su entrega a un gestor autorizado en las plantas de reciclaje correspondientes”. Laura Silva, por su parte, enumera cuatro barreras principales que impiden la implementación de prácticas de economía circular en el sector de la construcción: la falta de conocimiento y concienciación de los beneficios de la economía circular y las prácticas sostenibles en la construcción; las barreras regulatorias, ya que en algunos casos, la normativa y los procesos ad-
ministrativos pueden dificultar la reutilización y el reciclaje de RCD, como la falta de estándares claros para materiales reciclados o la complejidad de los trámites para la obtención de permisos; las dificultades logísticas y falta de infraestructura adecuada para la recolección, transporte, procesamiento y comercialización de RCD y, por último, los costos iniciales, ya que “la implementación de sistemas de gestión de RCD y la adaptación a prácticas de construcción sostenibles pueden requerir una inversión inicial que no todos los actores del sector están dispuestos a asumir”, apunta.
A ello se suma que en la actualidad la demanda de materiales reciclados en la construcción aún no es suficiente para absorber toda la oferta disponible, lo que puede dificultar su valorización. En este sentido, el sector de los áridos reciclados reclama que la administración pública actué como elemento tractor y aplique criterios de compra pública verde, premiando el uso de materiales reciclados y favoreciendo el consumo de productos de construcción que tienen un elevado porcentaje de reciclabilidad.
Partiendo de lo positivo, desde ANEFA comentan que en la actualidad existe normativa de planificación, estrategias, objetivos e indicadores que impulsan el uso de RCD. “También contamos con un sector muy profesionalizado, con una enorme capacidad de desarrollar I+D+i y con iniciativa privada que ha hecho su trabajo y ha conseguido los permisos y autorizaciones y realizado las inversiones necesarias para liderar el cambio de modelo económico”, indica Rita Martinez. “Ahora bien, la ausencia de desarrollo reglamentario adaptado a las características de esto nuevos materiales ha provocado una cierta desconfianza hacía su calidad u homogeneidad”, añade. La falta de confianza en las nuevas materias primas es, sin duda, una de las
ÁRIDOS RECICLADOS: PILAR DE LA CONSTRUCCIÓN SOSTENIBLE

principales barreras que el sector continúa sufriendo a la hora de introducir los áridos reciclados en el mercado. Los expertos aluden a la importancia de la normalización para garantizar el cumplimiento de sus prescripciones técnicas y su imprescindible estandarización. De esta manera los clientes podrán tener seguridad de que, independientemente de la naturaleza de los áridos que adquieren, éstos cuentan con los mismos requisitos de calidad que garantizan la máxima durabilidad de los edificios y las infraestructuras. ¿La solución propuesta? Profesionalizar todavía más el sector y exigir el marcado CE a los materiales que lo requieran y a los que no, una adecuada declaración de prestaciones.
Como novedad, la Ley 7/2022, de 8 de abril, de residuos y suelos contaminados para una economía circular introdujo nuevos objetivos y exigencias para el uso y gestión de los RCD. Entre los más destacados encontramos la obligación de diseñar los productos de construcción considerando el reciclaje al final de su vida útil y la obligación de realizar la separación en obra de los residuos de construcción. Pablo Pérez expresa su preocupación ante el hecho de que se siguen incorporando productos no reciclables en la construcción cuya separación es muy compleja. “No tiene sentido y contraviene los preceptos recogidos en la Ley el hecho de que sigamos incorporando en la construcción materiales que cuentan con buenas propiedades térmicas, acústicas y constructivas pero que, al final de su vida útil, deben acabar en vertedero, contaminando los residuos de construcción en su conjunto. Es necesario consolidar el mercado de los áridos reciclados para darles salidas”.

En esta misma línea, Rita Martinez extrapola el problema al conjunto de la sociedad, apelando a que los ciudadanos “no deberíamos permitir que fueran a vertedero recursos que todavía son aprovechables”. Si bien en el pasado fue una de las soluciones más generalizadas, ya no es justificable al existir una robusta red de gestores de RCD y medidas económicas que desincentivan el depósito en vertedero. “La actual Ley de Residuos impulsa un principio que hasta la fecha había estado un poco olvidado, el de proximidad. La aplicación del mismo es básica para estos residuos y materiales, pues aunque
su escaso valor económico imposibilita su transporte a larga distancia, resultan estratégicos. Desde hace años el sector se ha tomado en serio su papel como protagonista del mundo del reciclaje de residuos, representando en Europa aproximadamente el 50% del sector, ya que cuenta con innumerables sinergias para liderar la gestión de RCD y la producción de áridos reciclados y artificiales”, añade. En relación a la Ley de Residuos, Laura Silva se muestra positiva con los avances establecidos, pero comenta que existen algunos aspectos adicionales a considerar. “La utilización exten-
dida de RCD ofrece diversas oportunidades para acelerar la transición hacia la economía circular en el sector de la construcción, y es por ello que la Ley de Residuos debería agilizar y simplificar los trámites administrativos para facilitar la gestión de RCD, además de establecer criterios de calidad más estrictos para los materiales reciclados a partir de RCD, asegurando su idoneidad para su uso en la construcción”. Junto con lo anterior, Silva enfatiza el rol primordial que debe jugar el fomento de la investigación, desarrollo e innovación en tecnologías para la gestión eficiente de estos materiales”.
ÁRIDOS RECICLADOS: PILAR DE LA CONSTRUCCIÓN SOSTENIBLE
En la fotografía actual, el consumo de áridos reciclados supone aproximadamente un 2,4% respecto al consumo total de áridos, según señalan desde ANEFA, con lo que todavía queda mucho camino por recorrer en este sentido. Con la idea de incrementar la tasa de sustitución hasta el 11 o 15%, la innovación se está canalizando en estos momentos a través novedosos sistemas de demolición y plantas compactas de reciclaje que mejoren la autogestión en obra y el reaprovechamiento en la misma de sus propios residuos tratados, junto con técnicas de separación de las fracciones menos deseables, como partículas metálicas, las flotantes y los yesos, de cara a aumentar la precisión y la eficiencia de los procesos.
El pronóstico para la próxima década, tal y como asegura Rita Martinez, apunta hacia un avance decidido en materia de políticas de compra pública verde, así como el fortalecimiento de aquellos instrumentos que faciliten la puesta en práctica de los compromisos con la economía circular. “Se normalizarán el ecodiseño y las buenas prácticas para lograr una gestión eficaz de

EL MEDIO
AMBIENTE Y DISMINUYENDO
EL IMPACTO AMBIENTAL DE LA CONSTRUCCIÓN
los RCD generados en las obras. Esto, junto con la mejora de las infraestructuras de gestión, hará que se consolide el cambio de modelo económico en el sector de la construcción”.
Laura Silva concuerda con lo anterior y enfatiza que el sector de la construcción está mostrando un creciente compromiso con el cambio de paradigma hacia la economía circular, relacionado en parte con las exigencias marcadas por Europa. “Cada vez más empresas constructoras están implementando sistemas de gestión circular, haciendo crecer la demanda de materiales reciclados por parte de arquitectos, promotores y clientes, impulsando el desarrollo de este mercado”. Junto con ello, se están desarrollando inicia-
tivas de colaboración entre diferentes actores de la cadena de valor de la construcción y campañas de sensibilización y formación para profesionales. Silva remarca el enorme potencial de la utilización extendida de RCD, “generando beneficios ambientales, económicos y sociales. El sector está mostrando un compromiso creciente, aunque lento, con este cambio de paradigma, lo que permite avanzar hacia un futuro más sostenible para la industria de la construcción”.
Mirando hacia el futuro del sector constructivo, Pablo Pérez pone en valor el trabajo conjunto entre todos los agentes involucrados: gestores, administración, constructores, transportistas y organismos de investigación. “Desperdiciar una materia prima obtenida de un proceso de reciclaje es un lujo que la sociedad actual ya no se puede permitir, ni por razones ambientales ni económicas. Existen numerosos proyectos muy interesantes que aportarán grandes beneficios, pero si después de todo siguen entrando en las instalaciones los residuos mezclados y contaminados y se opta por seguir consumiendo áridos naturales, no avanzaremos. Por encima de lo anterior, Pérez se muestra optimista: “el camino iniciado no tiene retorno”.
Desperdiciar una materia prima obtenida de un proceso de reciclaje es un lujo que la sociedad actual ya no se puede permitir, ni por razones ambientales ni económicas.
Pablo Pérez, Director Técnico Grupo de Interés Áridos Reciclados de RCD.


n nuestros días asistimos a una aleación curiosa, poco común, entre discursos sociales ya consolidados y políticas públicas, una aleación que podemos llamar un consenso. Nos referimos al acuerdo en torno a la necesidad (y, por qué no, al imperativo) de ser sostenibles.
Del interés social por la sostenibilidad existen variados indicios, y uno de ellos es el número de búsquedas en motores como Google, en aumento constante desde 2019. Asimismo, son innumerables los avances de las políticas públicas en nuestro entorno.
La transición hacia una economía circular forma parte de este consenso, de este infrecuente acuerdo entre discursos sociales que reclaman y visi-
bilizan la necesidad de prácticas sostenibles, por un lado, y políticas públicas que apoyan, canalizan y traccionan los cambios que se necesitan en el tejido socioeconómico para alcanzar la sostenibilidad por el otro.
Desde 2022, una iniciativa de la ciudad de Madrid y de su Ayuntamiento viene impulsando esa transición y encarnando aquel consenso: el CIEC Madrid, localizado en el distrito de Vicálvaro.
Se trata de un Centro que forma parte de la visión estratégica de la ciudad para las transiciones energética, digital y verde, y que a la necesidad de la sostenibilidad medioambiental de las empresas suma la convicción de que también debe darse su sostenibilidad económica.
En sus casi tres años de existencia la experiencia acumulada en la diversidad de acciones y proyectos que acoge e impulsa el CIEC Madrid nos permite identificar una serie de palancas y oportunidades, que podemos resumir en cinco y que están en la base del Centro y de sus objetivos y misión:
1. Innovación tecnológica: la adopción de tecnologías avanzadas, como la inteligencia artificial, la impresión 3D y el ecodiseño, permite desarrollar soluciones más eficientes y circulares al tiempo que testar ideas de negocio. El CIEC Madrid cuenta con el FabLab, un laboratorio digital equipado con recursos y máquinas de última generación y abierto a todos los ciudadanos.
2. Colaboración público-privada: la cooperación entre Administraciones,
empresas y ciudadanos es crucial para crear un ecosistema que fomente prácticas circulares y sinergias cruzadas, y el CIEC Madrid funciona a partir de esa sinergia.
3. Educación y concienciación: una cultura de circularización (esto es, de hábitos y mentalidades) puede promoverse desde lo local, recurriendo a una comunicación multicanal (especialmente digital), ofreciendo programas educativos y desplegando campañas de sensibilización.
4. Políticas y regulaciones: implementar políticas que promuevan la economía circular y desincentiven prácticas no sostenibles es vital para incidir de manera positiva en el comportamiento de los agentes económicos y sociales.
5. Financiación y apoyo a startups: proveer recursos financieros y mentoría a nuevas empresas que desarrollen soluciones innovadoras en el ámbito de la economía circular viene a cerrar el círculo, especialmente con la colaboración sistémica de grandes empresas.
Estas palancas no se limitan a la experiencia del CIEC Madrid sino que son extrapolables a otros contextos urbanos.
Y es que, a pesar de las oportunidades que ofrece el actual consenso sobre la necesidad de ser sostenibles, existen varios desafíos.
Algunos de estos desafíos los conocemos de primera mano y desde la puesta en marcha y avance del CIEC Madrid, y atañen tanto a cuestiones de gestión como de recursos. Por mencionar algunos:
1. Resistencia al cambio, con empresas y personas aún aferrados a modelos lineales de producción y consumo.
2. Ampliar la infraestructura necesaria para implementar y mantener prácticas circulares como los centros de valorización, el reciclaje avanzado, un extremo que se verifica en algunos sectores económicos y por tamaño de empresa.
3. Costos iniciales, con una inversión de arranque para adoptar tecnologías y prácticas circulares que puede ser alta, lo que desincentiva a algunas empresas.
4. Desigualdad en el acceso a recursos necesarios para implementar prácticas sostenibles.
El Centro de Innovación en Economía Circular es un ejemplo concreto de la visión estratégica de Madrid para las transiciones digital, verde y energética. Nuestro objetivo es transformar Madrid desde lo local, contribuyendo a que nuestra ciudad se consolide como un referente de la economía circular a nivel europeo y global.
¿Qué hacemos y cómo lo hacemos?
En el CIEC Madrid nos dedicamos a:
• Impulsar la transformación del tejido económico hacia la circularidad, con programas de apoyo y mentoría a empresas, startups y emprendedores que buscan minimizar su impacto ambiental y promover la economía circular.
• Ofrecer capacitación y formación: proporcionamos cursos y talleres
prácticos abiertos, gratuitos y accesibles para proveer a las empresas y ciudadanía las herramientas necesarias para avanzar hacia la circularidad, favoreciendo, simultáneamente, la creación de empleos verdes para colectivos vulnerables.
• Impulsar la innovación tecnológica: facilitamos el acceso a tecnologías de vanguardia en nuestro FabLab, donde se pueden desarrollar y probar nuevas soluciones, contribuyendo, así, a la creación de una cultura de la innovación y la experimentación para concienciar y promover avances empresariales en torno a la circularidad.
• Promover soluciones verdes: desarrollamos y favorecemos la creación de soluciones basadas en la naturaleza (compostaje, cubiertas verdes, jardinería sostenible y adaptada al cambio climático y agricultura urbana) que no solo protegen el medio ambiente, sino que también fomentan la inclusión y la cohesión social.
• Consolidar la colaboración público-privada: fomentamos alianzas estratégicas entre el sector público y privado y dentro del privado en proyectos que benefician a toda la comunidad, y esto desde la organización y gobernanza misma del Centro, co-gestionado por el Ayuntamiento y diversas empresas e instituciones privadas.
La misión del CIEC Madrid es, así, clara y anclada en la práctica local y urbana: promover y respaldar la transformación de las empresas desde un modelo lineal a uno circular, así como crear nuevas empresas que NUESTRO

resuelvan necesidades en torno a la circularidad.
Vamos a seguir atrayendo empresas estratégicas al ecosistema circular y diseñar vías de colaboración efectiva entre el sector privado y el CIEC Madrid. Queremos continuar convirtiéndonos en un nodo de conocimiento con un impacto positivo en la sociedad, especialmente en la economía madrileña. Además, estamos comprometidos con soluciones, ideas y proyectos que llevan en su ADN la sostenibilidad no solo medioambiental, sino también econó-
CIEC MADRID SE POSICIONA COMO UN CATALIZADOR DEL CAMBIO HACIA UNA ECONOMÍA MÁS CIRCULAR, FOMENTANDO
mica, para asegurar que las empresas que apoyamos puedan prosperar en un mercado competitivo y sostenible. Queremos que la ciudadanía, a través de nuestras actividades, se sume a este intenso proceso de cambio, del cual es un elemento clave.
En resumen, el CIEC Madrid se posiciona como actor de aquel consenso que mencionábamos al principio, como un catalizador del cambio hacia una economía más circular, fomentando la innovación, la colaboración y la educación para construir un futuro más verde y equitativo.

e Nuria Suárez
LOS ÚLTIMOS AÑOS HEMOS SIDO TESTIGOS DE LAS CONSECUENCIAS
DIRECTAS DERIVADAS DE LA SOBREEXPLOTACIÓN DE MATERIAS PRIMAS Y EL SUBSIGUIENTE IMPACTO AMBIENTAL GENERADO POR LA EXTRACCIÓN
SIN MESURA DE MATERIALES NO RENOVABLES. TRATANDO DE DAR RESPUESTA A ESTE PROCESO AÚN REVERSIBLE, LOS ESFUERZOS SE
DIRIGEN HACIA EL DESARROLLO DE MATERIALES ALTERNATIVOS NO CONTAMINANTES. EN ESTA PIEZA NOS PONEMOS DEL LADO DE LA INVESTIGACIÓN
INNOVACIONES EN EL CAMPO DE LOS MATERIALES BIODEGRADABLES, PROFUNDIZANDO EN LOS BENEFICIOS ATRIBUIDOS AL USO GENERALIZADO DE MATERIALES SOSTENIBLES FRENTE A LOS CONVENCIONALES.
Encontrar materiales alternativos cuyas prestaciones sean tan buenas o mejores que las de los materiales convencionales y garantizar un impacto ambiental mínimo. Tales son los ambiciosos objetivos que se marca el ámbito investigador para ofrecer nuevos productos con garantías de sostenibilidad. Tratando de alcanzar el equilibrio justo entre durabilidad y biodegradabilidad, los estudios en este campo avanzan a gran velocidad, auspiciados por la necesidad de alcanzar la neutralidad climática en las próximas décadas. En este reportaje, Puerto Morales, profesora de investigación en el Instituto de Ciencia de Materiales de Madrid (ICMM-CSIC), ofrece su visión experta acerca de los prometedores hallazgos en el campo de la electrónica biodegradable, mientras que Amparo Chiralt y Chelo González-Martínez, investigadoras en el Instituto Universitario de
Ingeniería de Alimentos de la Universidad Politécnica de Valencia, nos adentran en el intrincado mundo de los envases alimentarios biodegradables.
La búsqueda de alternativas viables capaces de hacer frente a la gran problemática de generación de residuos está ganando cada vez más peso en la investigación científica. Esto responde tanto al reducido impacto ambiental de las mismas, como al potencial ahorro en costos y su contribución a un futuro más sostenible. Con la misión de hallar alternativas válidas para sustituir a los plásticos convencionales, Amparo Chiralt y Chelo González-Martínez, inmersas en el grupo de investigación en Biopolímeros del
BIODEGRADABLES
CRUCIALES PARA LOGRAR UN FUTURO LIBRE DE RESIDUOS
Instituto de Ingeniería de Alimentos FoodUPV, trabajan para mejorar las propiedades de estos materiales biodegradables alternativos y que puedan ser competitivos. Además, el grupo forma investigadores en el área de innovación en materiales para el envasado de alimentos, a fin de transferir al mercado personal preparado que pueda llevar a cabo una buena labor en el sector productivo. “Con los materiales biodegradables se abren multitud de oportunidades para el envasado alimentario, ya que el uso de este tipo de envase permitiría su desecho junto con los restos del alimento en el contenedor de materia orgánica, evitando los procesos de separación del envase y el reciclado”, comentan.
En campos muy diferentes, se están investigando soluciones con gran proyección, como es la electrónica biodegradable, que busca reemplazar los componentes electrónicos tradicionales con materiales que no gene-
ren residuos persistentes en el medio ambiente y puedan volver a ser utilizados en nuevos dispositivos. Tal como indica Puerto Morales, los avances en este campo son prometedores. Los materiales utilizados en la electrónica convencional, como la plata y el oro, tienen una gran durabilidad, pero también causan un impacto ambiental negativo al final de su vida útil. La electrónica biodegradable, en cambio, utiliza materiales como semiconductores orgánicos, polímeros biodegradables o materiales derivados de recursos renovables, que pueden descomponerse
naturalmente sin dejar residuos tóxicos. Esto es especialmente importante en un momento en que la producción de dispositivos electrónicos crece a un ritmo frenético. “Según la Organización de las Naciones Unidas, cada año se generan 50 millones de toneladas de basura tecnológica y, lo que es peor, el 80% de los componentes electrónicos no se reciclan y acaban en vertederos, convirtiéndose en potenciales contaminantes del suelo y las aguas subterráneas. Nuestro objetivo en el ICMM es evitar lo anterior”, explica Puerto Morales.
Con los materiales biodegradables se abren multitud de oportunidades para el envasado alimentario, ya que evitan los procesos de separación y el reciclado.
Amparo Chiralt y Chelo GonzálezMartínez, investigadoras en el Instituto Universitario de Ingeniería de Alimentos de la Universidad Politécnica de Valencia
El desarrollo de materiales biodegradables como alternativa a los plásticos convencionales en el envasado de alimentos es un campo de investigación que busca soluciones sostenibles y funcionales. Hablar de combatir la producción de plásticos convencionales es hablar intrínsecamente de la posibilidad de consumir alternativas que no se acumulen en los ecosistemas terrestres y marinos, ni generen microplásticos que acaben segregados a través de la cadena alimentaria. Por el contrario, las nuevas alternativas se degradan en moléculas pequeñas y en relativamente poco tiempo, generando CO 2 y agua al final de su proceso de degradación. Como explican las expertas de FoodUPV, esto resulta de la acción de las enzimas excretadas por los microorganismos presentes en el ecosistema, incorporándose así al ciclo natural de la materia orgánica y generando a su vez grandes ventajas a nivel medioambiental y de salud.
Amparo Chiralt y Chelo González-Martínez resaltan que la mayoría de las investigaciones actuales están alineadas con los principios de la economía circular, basados en el aprove-
Según la ONU, cada año se generan
50 millones de toneladas de basura tecnológica y el 80% de los componentes electrónicos no se reciclan y acaban en vertederos. Puerto Morales, profesora de investigación en el Instituto de Ciencia de Materiales de Madrid (ICMM-CSIC)
chamiento completo de los recursos naturales con el mínimo consumo energético e impacto ambiental. “En nuestro grupo de investigación llevamos más de 15 años trabajando con compuestos activos de origen natural, extraídos de plantas o residuos agroalimentarios, utilizando métodos ecológicos y sostenibles”, señalan.
Con esta misma finalidad de alcanzar un horizonte más sostenible, donde la generación de residuos sea mínima, desde el ICMM hacen hincapié en que los nuevos materiales alternativos resultan más económicos debido a su mayor abundancia en comparación con materiales más costosos como la plata. Llevado al campo de la electrónica biodegradable, el siguiente paso consiste
en explorar rutas de síntesis más sostenibles, que puedan llevarse a cabo mediante procesos respetuosos con el medio ambiente, utilizando reactivos menos tóxicos, a temperaturas más bajas y en tiempos más cortos. “Con el proyecto europeo Hypelignum ya hemos logrado desarrollar nanopartículas a un nivel muy reproducible, pero la idea es incrementar la producción para desarrollarlas a una escala mucho mayor. Varias empresas internacionales están interesadas en comercializarlos, por lo que el paso ya está contemplado y lo daremos en un plazo temporal relativamente corto”.
Al ser preguntadas por los principales desafíos científicos y tecnológicos derivados del desarrollo de nuevos envases alimentarios biodegradables, Amparo Chiralt y Chelo González-Martínez responden que, sin duda, uno de los retos más notorios para la puesta en el mercado de sus desarrollos es la baja producción mundial de bioplásticos, de los cuales solo el 62 % son biodegradables. “No obstante, desde 2023 ha vuelto a repuntar y se prevé que la capacidad de producción mundial aumente de unos 2,18 millones de toneladas en 2023 a aproximadamente 7,43 millones de toneladas en 2028”, sostienen.
En estos momentos, la mayor producción corresponde al poliácido láctico (PLA), seguido de los polihidroxialcanoatos (PHA), cuya procesabilidad y propiedades funcionales son más limitadas y hay que adecuarlas en su procesado a los requerimientos del envasado alimentario, lo que supone un gran reto para su implantación a nivel comercial. “Se han realizado numerosos estudios para mejorar sus propiedades, incorporando materiales
REPORTAJE

de relleno, mezclando biopolímeros con compatibilizadores, pero pocos hallazgos llegan al mercado, fundamentalmente por el mayor coste de producción”, comentan las expertas. Como estos materiales no se pueden reciclar, su utilización actual resulta problemática. “En nuestro equipo hemos hecho estudios laminando polímeros biodegradables para conseguir el mismo efecto protector. Estos serían compostables y no tendrían la limitación del reciclado, pero se trata
LA COMERCIALIZACIÓN A GRAN ESCALA DE MATERIALES
BIODEGRADABLES REQUIERE DE MAYOR INVERSIÓN PARA LOGRAR OPTIMIZAR TANTO LOS MÉTODOS DE PRODUCCIÓN
COMO SUS PROPIEDADES
FUNCIONALES
de desarrollos que no están todavía en el mercado”, aclaran.
En este mismo sentido y llevado al ámbito de aplicación de la electrónica biodegradable, Puerto Morales alega que el desafío principal es lograr que las prestaciones del material alternativo alcancen o mejoren aquellas presentes en el material convencional. Entre las tecnologías emergentes que están revolucionando el desarrollo de materiales alternativos, Morales destaca la nanotecnología, por ofrecer la oportunidad de mejorar las prestaciones de los materiales a escala nano mediante la alteración de sus propiedades físicas, químicas y mecánicas cuando se manipulan en dimensiones nanométricas.
La experta apunta que, a esta escala, los materiales exhiben comportamientos únicos, como mayor resistencia y dureza, propiedades ópticas únicas o mejora de las propiedades eléctricas, lo que puede mejorar la conductividad y permitir el desarrollo de componentes electrónicos más eficientes y rá-
pidos. “Desde el ICMM-CSIC hemos usado nanopartículas metálicas de hierro y níquel con buena conducción, que ofrecen un rendimiento similar a los materiales convencionales y que son biodegradables mediante un método más verde con el que prevenimos su oxidación, que hasta ahora ha sido el principal problema para su uso”.
INVERSIÓN ESTRATÉGICA PARA IMPULSAR TECNOLOGÍAS SOSTENIBLES
Para avanzar en la investigación de materiales biodegradables y alternativas sostenibles a los convencionales, es crucial establecer incentivos robustos que estimulen la innovación y la adopción de nuevas tecnologías. El respaldo institucional es indispensable para poder seguir avanzando en estos materiales alternativos y que puedan ir sustituyendo a los derivados del petróleo. En el caso de la Unión Europea, los diferentes organismos son los encargados de marcar la hoja de ruta a
través de directrices y normativas, en línea con los principios de la Agenda 2030 y los ODS para alcanzar una economía neutra en carbono.
“De momento las políticas están más centradas en la reutilización y reciclado de los materiales de envasado que en el uso de materiales biodegradables, que se ha reservado a unos pocos casos muy específicos”, aseguran Amparo Chiralt y Chelo González-Martínez. Aún así, afirman que la disponibilidad de polímeros biodegradables ha crecido, auspiciada por estudios que avalan su utilización segura para el envasado alimentario. “Supondría un gran avance que desde la regulación se impulsara el uso de materiales biodegradables para productos concretos, sobre todo aquellos donde el reciclado de los envases actuales plantea serios problemas. La presión legislativa sobre el uso de plásticos será clave para acelerar los desarrollos industriales y la puesta en el mercado de las alternativas para su uso en el envasado alimentario”, sentencian. El otro pilar fundamental corresponde a la incentivación económica del sector investigador. Según datos del Instituto Nacional de Estadística (INE), la inversión dedicada a Investigación y Desarrollo en España ha crecido hasta el 1,44% del PIB en los últimos años. Una cifra que, si bien es positiva, se encuentra aún lejos de unos niveles europeos que rozan el 2,22% de media, llegando a alcanzar el 3,44% para el caso de Bélgica. En este contexto, los investigadores demandan un mayor compromiso con los campos de estudio emergentes, con vistas a desarrollar tecnologías más eficientes y sostenibles para su posterior puesta en el mercado. Además, subrayan la importancia crítica de los materiales alternativos en la promoción y desarrollo de la economía circular, destacando el impacto positivo que las iniciativas y proyectos de investigación están teniendo en este ámbito.
Los materiales biodegradables serán fundamentales en la transición hacia un futuro libre de residuos, ofreciendo una solución innovadora y sostenible para enfrentar la acumulación de los mismos al término de su vida útil. La investigación y desarrollo en áreas emergentes se presentan como el punto de inicio de una transformación más amplia hacia una economía circular; un enfoque que no solo busca reducir el impacto ambiental, sino también promover el uso responsable de materiales, alineándose con los principios de sostenibilidad y minimización de residuos.
BIODEGRADABLES
PROMETEDORA, MINIMIZANDO EL IMPACTO AMBIENTAL E IMPULSANDO LA ECONOMÍA
CIRCULAR
En el incipiente campo de la electrónica biodegradable todo apunta hacia un avance significativo en los próximos años, impulsado por la necesidad de reducir el impacto ambiental de los residuos electrónicos y la creciente conciencia sostenible. “Se desarrollarán materiales más eficientes y completamente biodegradables para su uso en componentes electrónicos, como semiconductores orgánicos, polímeros biodegradables o materiales derivados de recursos renovables, como es el caso de la madera”, comenta Puerto Morales. Señala también que se crearán dispositivos más simples, modula-
res y con componentes que puedan separarse y degradarse más fácilmente. “Finalmente, estos materiales podrán ser integrados en dispositivos que se biodegradan después de cumplir su función o en envases inteligentes y dispositivos desechables para el seguimiento de diferentes parámetros ambientales”, afirma.
Para el caso de los envases biodegradables, las investigadoras de FoodUPV aseguran que su éxito en los próximos años va a depender en gran parte de los organismos e instituciones, que son quienes marcan las directrices a seguir, pero también de los consumidores, ya que son éstos los que pueden ejercer presión hacia lo que consideran más adecuado para la sociedad y el medio ambiente. “Lo ideal sería poder usar envases biodegradables en muchos alimentos y que, a su vez, estos envases permitan alargar su vida útil para reducir el desperdicio alimentario”. Amparo Chiralt y Chelo González-Martínez se muestran optimistas y sostienen que estos materiales alternativos se irán implantando poco a poco con la colaboración de todos los agentes: administración, empresas, investigadores y consumidores. “Iremos progresivamente hacia un futuro libre de plásticos en nuestros suelos, aguas y alimentos”. Tras lo expuesto, podemos afirmar que la transición hacia un futuro sostenible requerirá un enfoque integral y multidisciplinar apoyado en tres pilares: innovación en materiales biodegradables, respaldo institucional y colaboración entre distintos agentes. Los materiales biodegradables se perfilan como una solución prometedora frente a la acumulación de residuos, proporcionando una alternativa que no solo minimiza el impacto ambiental, sino que también impulsa la economía circular al promover la reutilización y la regeneración de recursos de manera sostenible.


ENTREVISTA O
DIRECTORA DE COMUNICACIÓN PARA OCEANA EN EUROPA
Nuria Suárez
Proteger y restaurar los océanos del mundo. Tal es el firme propósito de la organización Oceana, que desde su fundación en 2001 lleva todos estos años implementando acciones globales que abordan problemas específicos, como la contaminación marina, el cambio climático o la sobrepesca. A través de campañas ciudadanas e iniciativas políticas, Oceana trabaja principalmente para reducir los residuos en el mar, promover prácticas pesqueras responsables y proteger los hábitats marinos, desempeñando un papel crucial en la conservación de la biodiversidad marina y la salud de los ecosistemas oceánicos. En esta entrevista, Natividad Sánchez, directora de Comunicación para Oceana en Europa, comparte su visión sobre los esfuerzos de la organización para proteger los océanos, sus estrategias actuales y los desafíos que enfrentan a la hora de abordar los retos más urgentes.
Oceana actualmente es la mayor organización internacional en defensa de los océanos. Desde entonces, ¿cómo han evolucionado la cantidad y tipo de contaminantes marinos en los últimos 20 años? ¿y la concienciación general?
Hemos observado una evolución preocupante. Además de las emisiones de gases de efecto invernadero de los buques y de los sucesivos vertidos de hidrocarburos que se van acumulando en el mar, el océano se está llenando de residuos. El plástico se
La sociedad es consciente de la actual explosión de contaminación marina por plásticos, pero falta resolución para frenarla
ha convertido en el tipo de material dominante, con la peculiaridad de que hablamos de polímeros diversos a los que, además, se añaden miles de aditivos. Se han hallado microplásticos en zonas consideradas prístinas, como la Antártida, y los químicos liberados al medio marino están entrando en las cadenas alimentarias marinas. La sociedad es consciente de esta explosión de la contaminación por plásticos, pero falta resolución para frenarla.
A lo largo del planeta, ¿cuáles son las áreas prioritarias de actuación en las que centra sus esfuerzos Oceana? ¿qué espacios geográficos identifican como más vulnerables?
Oceana centra sus esfuerzos en la protección de hábitats marinos, la reducción de la sobrepesca, la transparencia y la
contaminación. Nuestra organización tiene oficinas en países que representan el 27% de las capturas mundiales de pescado, y calculamos que la recuperación de las poblaciones de peces podría aportar una comida diaria a mil millones de personas. También hacemos campañas para declarar áreas marinas protegidas en lugares de alto valor ecológico y asegurar que la protección no se queda solo en el papel. Dentro de Europa, hemos realizado campañas en distintos mares y actualmente seguimos muy activos en el Mediterráneo, que se encuentra entre los mares más sobreexplotados, contaminados y afectados por la pérdida de biodiversidad de todo el mundo.
En el año 2020 realizaron un estudio acerca de la contaminación plástica marina en España. ¿Qué factores han propiciado la acumulación de basura marina y qué impactos se derivan de este hecho?
Factores como la gestión inadecuada de residuos urbanos, el turismo masivo y la elevada densidad de población en el litoral contribuyen a que en España se genere gran cantidad de basura marina. A ellos hay que añadir que nuestras aguas tienen una profundidad media de 3.000 metros, por lo que poco a poco los residuos se van acumulando a gran profundidad. Las bajas temperaturas y la falta de erosión hacen que los plásticos tarden mucho en degradarse en estos entornos y alteren drásticamente el paisaje submarino. En el caso del Mediterráneo, al ser un mar semicerrado, permanecen atrapados en él sin llegar a salir al océano. Nos encontramos, por tanto, ante cambios irreversibles en los ecosistemas que afectan a los hábitats donde vive, se reproduce, crece y se alimenta la fauna marina.
recuperar todos los residuos que llegan al mar. La inmensa mayoría de ellos acaba en el fondo marino, por lo que la verdadera magnitud del problema pasa desapercibida. Una vez allí, el coste de recoger la basura marina es superior a lo que cuesta fabricar esos productos. Cuando se trata de grandes profundidades, en el hipotético caso de disponer de la tecnología para llegar a ellas, los costes diarios son enormes, por lo que nunca se va a poder retirar toda la basura marina. La única solución es reducir la fabricación y consumo de artículos innecesarios, incluyendo plásticos de un solo uso, y evitar por todos los medios que los residuos lleguen al mar.
Estudios remarcan que cerca del 80% de los plásticos que se vierten al mar provienen de tierra. ¿Qué papel desempeñan las estrategias e infraestructura de recogida y tratamiento de residuos?
Factores como la gestión inadecuada de residuos urbanos, el turismo masivo y la elevada densidad de población en el litoral contribuyen a que en España se genere gran cantidad de basura marina
La mejora en la infraestructura de recogida y tratamiento de residuos es crucial para reducir esta contaminación. Se debe incentivar el retorno de envases vacíos y la reutilización, y en ese sentido los sistemas de depósito, devolución y retorno gozan de un papel muy importante, porque minimizan la generación de basura dispersa y promueven un uso más eficiente de los envases. El reciclaje tiene sus límites, marcados por la composición del producto, la calidad de la materia prima, su degradación tras cada ciclo de reciclado, etc. En este sentido, hay que recordar que, a la hora de comercializar un producto, hay que diseñar también el final de su vida útil.
También confirmaron que las campañas de sensibilización sobre los efectos negativos del plástico en los océanos, la recogida de residuos y la limpieza de playas no han sido suficientes para mejorar la situación. ¿Por qué fallan? ¿qué medidas reclaman para aminorar la incidencia plástica en los océanos?
Las campañas de sensibilización, incluida la limpieza de playas, son muy útiles para que el ciudadano entienda que la basura marina es un problema; pero es sencillamente inviable
La organización trabaja activamente para lograr políticas basadas en la ciencia que protejan los océanos. ¿Cuenta España con medidas efectivas para controlar, reducir y penalizar la contaminación plástica marina? ¿echan en falta un marco jurídico más robusto en esta materia?
Echamos en falta que se aprovechen mejor los conocimientos que hay sobre el impacto de las basuras marinas y las oportunidades legislativas para abordarlo. En estos últimos años hemos asistido a la aprobación de la Ley de Residuos, que transponía la Directiva de Plásticos de Un Solo Uso, y a

Los sistemas de depósito, devolución y retorno gozan de un papel muy importante, porque minimizan la generación de basura dispersa y promueven un uso más eficiente de los envases
la aprobación del Reglamento sobre Envases y Residuos de Envases, que en parte transcurrió durante la presidencia española de la UE. Creemos que se podían haber aprobado medidas mucho más ambiciosas, como limitar el uso de envases de un solo uso en la hostelería, poner coto a las toallitas que contaminan ríos y mares, prohibir la suelta masiva de globos en celebraciones… Estamos arrojando al mar productos que duran siglos y que apenas se usan durante unos minutos, y todo ello por defender intereses de mercado.
Oceana en Europa trabaja de la mano de gobiernos, organizaciones y otras entidades para implementar
soluciones basadas en los hallazgos de sus estudios. ¿Cómo se desarrollan estos marcos colaborativos? ¿puede proporcionar algún ejemplo de colaboración exitosa?
Un buen ejemplo es la colaboración con la Unión Europea para la creación y gestión de áreas marinas protegidas. Oceana ha realizado numerosas expediciones para recabar documentación sobre hábitats y especies marinas. Estos datos se han aportado a las autoridades nacionales y han facilitado la labor de las administraciones. Por ejemplo, hemos participado en proyectos LIFE de la UE para declarar áreas marinas pro-

tegidas en España y en Malta dentro de la red Natura 2000, que engloba los espacios de mayor valor ecológico de la UE.
Con la mirada puesta en la próxima década, ¿qué tendencias pronostican en relación al aumento de la presencia de residuos en los océanos? ¿qué oportunidades se abren para mejorar la gestión de residuos?
Tal como ha ocurrido en las últimas décadas, la llegada de plásticos al mar seguirá en aumento, a no ser que el problema se aborde desde el origen en el tratado de la ONU

NATIVIDAD SÁNCHEZ,
OCEANA
La mejora en la infraestructura de recogida y tratamiento de residuos resulta crucial para poder abordar la contaminación marina
sobre el plástico. Actualmente se fabrican objetos sin pensar en cómo se pueden gestionar sus residuos, ni siquiera en si se pueden gestionar eficazmente. La basura marina recorre miles de kilómetros y gran parte de los países no tienen infraestructuras para tratarla, por lo que es esencial reducir la producción.
Las nuevas tecnologías están desempeñando un papel crucial para mejorar los esfuerzos de conservación marina. ¿Cuáles son algunas de las innovaciones tecnológicas más prometedoras?
Muchas veces las mejores tecnologías son las antiguas: materiales que se degradan naturalmente, sin liberar aditivos tóxicos ni requerir continuas adaptaciones en las plantas de tratamiento. Por ejemplo, la solución no es un envase compostable si en mi zona no hay instalaciones adecuadas, ni un bioplástico que liberará químicos cuando se degrade. Desde el punto de vista de la conservación, en Oceana empleamos robots submarinos para documentar el impacto de los residuos en el fondo del mar. También hemos desarrollado un modelo computacional pionero en colaboración con las universidades de Newcastle y Cádiz que permite prever los recorridos del plástico no solo en superficie, sino también en el fondo marino.
Para finalizar, ¿puede la implementación de una economía circular influir en la reducción de residuos en los océanos?
Sí, una economía circular bien diseñada es esencial para disminuir el flujo de basura en el mar. Debe basarse en reducir, reutilizar y reparar para minimizar la basura dispersa; además de no confundir entre materias primas que se reciclan y aquellas que se infrarreciclan.
Karin Meisterl FUNDACIÓ

www.ent.cat
Hoy en día, los plásticos se han convertido en una parte indispensable de la vida cotidiana. Además del crecimiento de la población mundial, el aumento del nivel de vida medio y la sustitución de los materiales tradicionales por plásticos son los factores más importantes para explicar el crecimiento de la producción mundial de plásticos. La producción mundial anual de resinas plásticas pasó de 1,7 Mt en los años 50¹ a 390,7 Mt en 2021, y la producción europea de plásticos ascenderá a 57,2 Mt en 2021².
Estamos rodeados de plásticos, incluyendo la construcción, el transporte, la electrónica y la sanidad. Sin embargo, la aplicación más común de los plásticos en todo el mundo es, con diferencia, el
envasado (de un solo uso) (44%), seguido de la construcción (18%)¹.
Se producen muchos tipos diferentes de plásticos con distintas propiedades, pero sólo unos pocos en grandes cantidades: principalmente termoplásticos, que pueden moldearse y adoptar prácticamente cualquier forma e incluyen plásticos estándar como el polietileno (PE), el polipropileno (PP), el cloruro de polivinilo (PVC) y el tereftalato de polietileno (PET)³.
Las propiedades típicas de los plásticos incluyen versatilidad, durabilidad, ligereza, resistencia, altas propiedades de aislamiento térmico y eléctrico, bajo coste y transparencia potencial, lo que los hace adecuados para una amplia gama de aplicaciones. Por desgracia, estas mismas propiedades también los convierten en una grave amenaza para
el medio ambiente⁴. El aumento de plásticos en el medio acuático también tiene un impacto negativo en la salud humana y la economía⁵.
La mala gestión de los residuos (plásticos) es la principal razón por la que las fuentes terrestres que entran en el mar por diversas vías, como los ríos, las aguas residuales urbanas y la basura de las playas, representan la gran mayoría⁶. Los aparejos de pesca desechados son otro contribuyente importante⁷. Las catástrofes naturales, como los tsunamis y las tormentas, también pueden influir en la proliferación de residuos plásticos en el océano⁸.
La Comisión Europea clasifica los residuos plásticos en macroplásticos (>25 mm), mesoplásticos (de 5 a 25 mm), microplásticos grandes (de 1 a 5 mm),
microplásticos pequeños (de 20 μm a 1 mm) y nanoplásticos (<20 μm)⁹.
Los microplásticos pueden ser de origen primario o secundario. En el primer caso, se produce deliberadamente y se encuentra en pélets, la materia prima industrial de los productos plásticos, en microperlas (normalmente PE y PS < 1 mm) añadidas a productos de cuidado personal y cosméticos o a aplicaciones industriales, en la abrasión de neumático10 o en fibras plásticas microscópicas de textiles (principalmente poliéster y acrílico)11,12. Sin embargo, los microplásticos de origen secundario representan la mayor parte de la creciente cantidad de microplásticos, dado que cuando se exponen al aire libre, los trozos de plástico más grandes se fragmentan en millones de trozos de microplástico13
La alta radiación ultravioleta, la concentración de oxígeno y la temperatura, en combinación con la abrasión física (arena, olas) aceleran los procesos de fragmentación, especialmente en ríos y costas. La degradación biológica por organismos también puede desempeñar un papel importante14
Los residuos plásticos (especialmente los microplásticos) pueden encontrarse en todas partes: desde los polos15 hasta el ecuador16 , desde ríos17, lagos18 , mar abierto19 y aguas profundas20 hasta costas21 y suelos terrestres10, desde bajos niveles hasta «puntos calientes» localizados. Y su abundancia no deja de aumentar. Con el paso de los años, el viento y las corrientes oceánicas pueden hacer que los residuos plásticos desechados o abandonados recorran largas distancias antes de quedar varados en las playas o depositados en el lecho marino, en bahías o cauces fluviales³.
Los residuos plásticos marinos tienen diversos efectos negativos en el medio ambiente. Se ha demostrado que los enredos en la fauna son los que tienen efectos más nocivos para los animales que viven cerca o en el agua: Peces,
mamíferos marinos, tortugas marinas, aves marinas y otras especies mueren estrangulados o ahogados al enredarse en redes, cuerdas sintéticas y sedales, bolsas, packs de seis anillas, etc.22 Las redes de pesca abandonadas, conocidas como «redes fantasma», son especialmente peligrosas, ya que pueden tener cientos de metros de longitud y seguir capturando animales cuando se hunden o se pierden en el lecho marino23. Además, se ha observado con frecuencia la ingestión de grandes trozos de residuos plásticos (> 5 mm) en diversas especies, como peces, aves, tortugas y cetáceos24. La ingestión de restos no nutritivos reduce el volumen efectivo del estómago y puede crear una falsa sensación de saciedad, lo que provoca una ingesta inadecuada de alimentos, desnutrición y, en casos graves, obstrucción del tubo digestivo y muerte lenta por inanición25
Debido a su pequeño tamaño, similar al de las partículas de sedimento o plancton, los microplásticos son ingeridos con mayor frecuencia por diversos organismos y acaban acumulándose en la red trófica26. Los microplásticos actúan como portadores de contaminantes nocivos, que o bien ya están
La mala gestión de los residuos (plásticos) es la principal razón por la que las fuentes terrestres que entran en el mar por diversas vías, como los ríos, las aguas residuales urbanas y la basura de las playas, representan la gran mayoría
presentes en los polímeros en forma de aditivos o monómeros, o bien se absorben en las partículas de plástico desde el agua circundante.10
Por último, los fragmentos de plástico son un vector de transporte potencial para la dispersión a larga distancia y la colonización de organismos. Los bioincrustantes (bacterias, algas, zooplancton, mejillones, etc.) adheridos a los residuos plásticos flotantes pueden influir en la composición de las especies naturales introduciendo especies alóctonas (exóticas) a través de los fragmentos de plástico. Las especies acuáticas invasoras se consideran una de las amenazas más graves para la biodiversidad y son extremadamente difíciles de controlar27
Por todo ello, las medidas para combatir la contaminación por plásticos son objeto de un amplio debate. Sensibilizar a la población es una medida importante contra el abandono de basura, pero también lo son la prevención y la gestión eficaz de los residuos. Aunque las medidas de limpieza (de playas) también son importantes, es primordial evitar que los plásticos lleguen al medio ambiente. En la UE, los residuos plásticos se gestionan principalmente con arreglo a la Directiva de Envases y Residuos de Envases (94/62/CE)28 y la Directiva Marco de Residuos (2008/98/CE)29
Para hacer frente a la contaminación por plásticos, se introdujo la Directiva sobre plásticos de un solo uso ((UE) 2019/904)30 cuyo objetivo es reducir el impacto ambiental de los productos de plástico de un solo uso mediante la prohibición de determinados artículos, el fomento del uso de alternativas sostenibles y la imposición de obligaciones a los productores en materia de gestión de residuos y esfuerzos de limpieza. Sin embargo, aún queda mucho por hacer, ya que las principales tendencias en materia de producción y consumo se mantienen en gran medida inalteradas. Dado que la mayoría de los focos de contaminación por plásticos se encuen-
tran fuera de la UE31, es fundamental actuar a escala mundial. Especialmente en los países en desarrollo, sigue faltando un marco político eficaz para la gestión de los residuos (plásticos) y su financiación, por ejemplo, mediante la responsabilidad ampliada del productor (RAP) o sistemas de devolución de depósitos32
Desde 2022, el Tratado Mundial sobre los Plásticos (‘Global Plastics Treaty’) se negocia en el marco del Programa de las Naciones Unidas para el Medio Ambiente (PNUMA) con el fin de crear un marco internacional jurídicamente vinculante para hacer frente a la contaminación por plásticos mediante la reducción de su producción, la promoción de alternativas sostenibles y la mejora de la gestión de residuos y las prácticas de reciclaje. El objetivo es implicar a todas las partes interesadas, incluidos los gobiernos, la industria y la sociedad civil. La cuarta reunión del Comité Intergubernamental de Negociación sobre la Contaminación por Plásticos (INC-4), celebrada en Ottawa (Canadá), concluyó con un proyecto avanzado de instrumento internacional jurídicamente vinculante para hacer frente a la contaminación por plásticos, aunque prosigue el debate sobre si el tratado debe aplicar normas mundiales comunes o basarse en planes nacionales voluntarios. La próxima reunión, INC-5, tendrá lugar en noviembre de 2024 en Busan (Corea del Sur), donde se espera que se finalice el texto del tratado33
1 PlasticsEurope. (2013). Plastics - The Facts 2013: An analysis of European latest plastics production, demand and waste data.
2 PlasticsEurope (2022): Plastics – The Facts 2022.
3 Young, R. J., Lovell, P. A. (2011). Introduction to polymers (Third.). USA: Taylor & Francis Group. 668 pp.
4 Thompson, R. C., Moore, C. J., vom Saal, F. S., Swan, S. H., Saal, F. S., & Swan, S. H. (2009). Plastics, the environment and human health: current consensus and future trends. Philosophical Transactions of the Royal Society of London. Series B, Biological Sciences, 364(2009), 2153–2166. https://doi.org/10.1098/ rstb.2009.0053
5 United Nations Environment Programme, UNEP (2021). From Pollution to Solution: A global assessment of marine litter and plastic pollution. Synthesis. Nairobi
6 Geyer, R., Jambeck, J. & Law, K. L. (2017). Production, use, and fate of all plastics ever made. Science Advances Research Article, 3, https://doi.org/10.1126/ sciadv.1700782
7 Lebreton, L., Royer, S. J., Peytavin, A., Strietman, W. J., Smeding-Zuurendonk, I., & Egger, M. (2022). Industrialised fishing nations largely contribute to floating plastic pollution in the North Pacific subtropical gyre. Scientific reports, 12(1), 1-11
8 Vannela, R. (2012). Are We “Digging Our Own Grave” Under the Oceans? Biosphere-Level Effects and Global Policy Challenge from Plastic(s) in Oceans. Environmental Science & Technology, 46, 7932–7933. doi:dx.doi.org/10.1021/es302584e
9 European Commission Joint Research Center, EC JRC. (2013). Guidance on Monitoring of Marine Litter in European Seas. A guidance document withon the Common Implementation Strategy for Marine Strategy Framework Directive.
10 Sommer, F., Dietze, V., Baum, A., Sauer, J., Gilge, S., Maschowski, C. and Gieré, R. (2018). Tire Abrasion as a Major Source of Microplastics in the Environment. Aerosol Air Qual. Res. 18: 2014-2028. https://doi. org/10.4209/aaqr.2018.03.0099
11 Boucher, J. and Friot D. (2017). Primary Microplastics in the Oceans: A Global Evaluation of Sources. Gland, Switzerland: IUCN. 43pp.
12 Browne, M. A., Crump, P., Niven, S. J., Teuten, E., Tonkin, A., Galloway, T., & Thompson, R. (2011). Accumulation of microplastic on shorelines woldwide: sources and sinks.
13 Law, K.L. & R.C. Thompson (2014). Oceans. Microplastics in the seas. Science.11, 345(6193):144-5. doi: 10.1126/science.1254065
14 MacLeod, M., Arp, H. P. H., Tekman, M. B., & Jahnke, A. (2021). The global threat from plastic pollution. Science 373, 61-65
15 Obbard, R. W., Sadri, S., Wong, Y. Q., Khitun, A. A., Baker, I., Richard, C., & Thompson, R. C. (2014). Global warming releases microplastic legacy frozen in Arctic Sea ice. Earth’s Future, 2, 315–320. https://doi.org/10.1002/2014EF000240.Abstract
16 Barnes, D. K. A., Galgani, F., Thompson, R. C., & Barlaz, M. (2009). Accumulation and fragmentation of plastic debris in global environments. Philosophical Transactions of the Royal Society of London. Series B, Biological Sciences, 364(1526), 1985–1998. https://doi. org/10.1098/rstb.2008.0205
17 Lebreton, L. C. M., Zwet, J. Van Der, Damsteeg, J., Slat, B., Andrady, A., & Reisser, J. (2017). River plastic emissions to the world ’ s oceans. Nature Communications, 8, 1–10. https://doi.org/10.1038/ncomms15611
18 Eriksen, M., Mason, S., Wilson, S., Box, C., Zellers, A., Edwards, W., … Amato, S. (2013). Microplastic pollution in the surface waters of the Laurentian Great Lakes. Marine Pollution Bulletin, 77(1–2), 177–182. https://doi.org/10.1016/j.marpolbul.2013.10.007
19 Cózar, A., Echevarría, F., González-Gordillo, J. I., Irigoien, X., Ubeda, B., Hernández-León, S., … Duarte, C. M. (2014). Plastic debris in the open ocean. Proceedings of the National Academy of Sciences of the United States of America, 17–19. https://doi.org/10.1073/
pnas.1314705111
20 Mordecai, G., Tyler, P. A., Masson, D. G., & Huvenne, V. A. I. (2011). Litter in submarine canyons off the west coast of Portugal. Deep-Sea Research Part II, 58(23–24), 2489–2496. https://doi.org/10.1016/j. dsr2.2011.08.009
21 Ivar do Sul, J. A., Spengler, Â., & Costa, M. F. (2009). Here, there and everywhere. Small plastic fragments and pellets on beaches of Fernando de Noronha (Equatorial Western Atlantic). Marine Pollution Bulletin, 58(8), 1236–1238.
22 Sheavly, S. B., & Register, K. M. (2007). Marine debris & plastics: Environmental concerns, sources, impacts and solutions. Journal of Polymers and the Environment, 15, 301–305. https://doi.org/10.1007/ s10924-007-0074-3
23 Stelfox, M., Hudgins, J. & Sweet, M. (2016). A review of ghost gear entanglement amongst marine mammals, reptiles and elasmobranchs. Marine Pollution Bulletin, 111 (1-2): 7-17. https://doi.org/10.1016/j. marpolbul.2016.06.034
24 Carson, H. S. (2013). The incidence of plastic ingestion by fishes: from the prey’s perspective. Marine Pollution Bulletin, 74(1), 170–174. https://doi.org/10.1016/j.marpolbul.2013.07.008
25 Stephanis, R. De, Giménez, J., Carpinelli, E., Gutierrez-exposito, C., & Cañadas, A. (2013). As main meal for sperm whales : Plastics debris. Marine Pollution Bulletin, 69(1–2), 206–214. https://doi.org/10.1016/j. marpolbul.2013.01.033
26 Wright, S. L., Thompson, R. C., & Galloway, T. S. (2013). The physical impacts of microplastics on marine organisms: a review. Environmental Pollution, 178, 483–492. https://doi.org/10.1016/j.envpol.2013.02.031
27 Gregory, M. R. (2009). Environmental implications of plastic debris in marine settings--entanglement, ingestion, smothering, hangers-on, hitch-hiking and alien invasions. Philosophical Transactions of the Royal Society of London. Series B, Biological Sciences, 364(2009), 2013–2025. https://doi.org/10.1098/ rstb.2008.0265
28 European Parliament and Council Directive 94/62/EC of 20 December 1994 on packaging and packaging waste y Directive 2008/98/EC of the European Parliament and of the Council of 19 November 2008 on waste and repealing certain Directives (Text with EEA relevance).
30 Directive (EU) 2019/904 of the European Parliament and of the Council of 5 June 2019 on the reduction of the impact of certain plastic products on the environment
31 Jambeck, J R , Geyer, R , Wilcox, C , Siegler, TR , Perryman, M , Andrady, A , Narayan, R , and Law, K L (2015) Plastic waste inputs from land into the ocean Science 347, 768–771 https://doi org/10 1126/science 1260352
32 Alpizar, F., Carlsson, G., Lanza, B. ,Carney, R.C., Daniels, M., Jaime, T., Ho, Z., Nie, C., Salazar, B., Tibesigwa & S., Wahdera (2020): A framework for selecting and designing policies to reduce marine plastic pollution in developing countries. Environmental Science & Policy. 109 : 25-35. https://doi.org/10.1016/j.envsci.2020.04.007. 33 Fourth Session | UNEP - UN Environment Programme. https://wedocs.unep.org/bitstream/handle/20.500.11822/45872/INC4_Report.pdf















Aquí puede ir su publicidad info@retema.es
RETEMA_82x47mm+3mm sangre.pdf 1 13/03/2024 17:40:32

Aquí puede ir su publicidad info@retema.es






Aquí puede ir su publicidad info@retema.es

Aquí puede ir su publicidad info@retema.es


Aquí puede ir su publicidad info@retema.es




DIRECTORIO




































Aquí puede ir su publicidad info@retema.es





